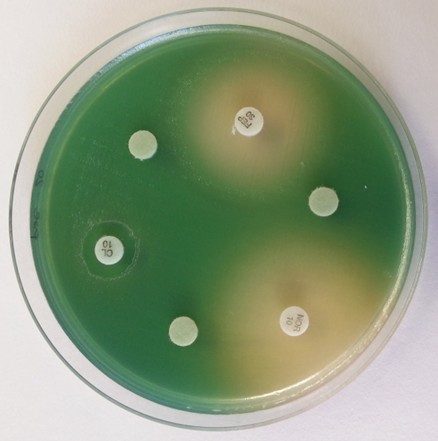

Contenu principal
Abgeschlossene Projekte
Das Programm Open Science I von swissuniversities widmete sich 2021-2024 der Umsetzung des Nationalen Open Access-Aktionsplans (OA) an den Schweizer Hochschulen und umfasst seit 2022 auch die Umsetzung des Nationalen Aktionsplans Open Research Data (ORD). swissuniversities hat dafür zwei Anträge für projektgebundene Beiträge beim Hochschulrat SHK beantragt, die 2021 und 2022 genehmigt wurden und in zwei Programmphasen umgesetzt werden. Hier werden die erfolgreich durchgeführten Projekte des Programms vorgestellt.
Phase A – Open Access
Die Phase A Open Access hatte zum Ziel, den Anteil an Open Access Publikationen der Hochschulen zu erhöhen. Eine Kombination von Massnahmen sollte es den Forschenden erleichtern, ihre Publikationen frei zugänglich zu machen. So trugen beispielsweise der Aufbau und die Vernetzung von Open Access-Diensten und -Infrastrukturen, Verhandlungen mit Grossverlagen oder die Förderung alternativer Publikationsformen zu einer nachhaltigen Umsetzung von Open Access in der Schweiz bei.
Aktionslinie Open Access Policies
Institutionelle Open Access-Richtlinien der Schweizer Hochschulen bringen den Transformationsprozess hin zu frei zugänglichen wissenschaftlichen Publikationen voran. Um eine kohärente Umsetzung von Open Access an den Hochschulen gegenüber den Forschenden, den Förderorganisationen und den Verlagen zu gewährleisten, sollen sich diese Richtlinien an gemeinsamen Prinzipien entlang internationalen Standards orientieren.
Aus diesem Grund wurde das Netzwerk der Hochschulbibliotheken (SLiNER) damit beauftragt, einen Leitfaden mit Empfehlungen für institutionelle Open-Access-Richtlinien der Schweizer Hochschulen zu erarbeiten. Diese Policy Guidelines (2019) sind auf Deutsch, Englisch und Französisch verfügbar.
Der Background Report zum Open-Access Strategy Review hat aufgezeigt, dass die institutionellen Open-Access-Strategien an den Schweizer Hochschulen erfolgreich angekommen sind: Der Anteil der Schweizer Hochschulen mit Open-Access-Policies ist seit 2015 von 49 Prozent auf 86 Prozent im Jahr 2023 gestiegen und ist damit vergleichbar mit den europäischen Entwicklungen.
Policies der Hochschulen

Übersicht der Hochschulen
- Berner Fachhochschule
- Ecole Polytechnique Fédérale de Lausanne
- ETH Zürich
- Fachhochschule Nordwestschweiz
- Haute école pédagogique de Berne
- Haute Ecole Spécialisée de la Suisse italienne
- Haute école spécialisée de Suisse occidentale
- Hochschule Luzern
- Interkantonale Hochschule für Heilpädagogik
- Pädagogische Hochschule Schaffhausen
- Pädagogische Hochschule St.Gallen
- Pädagogische Hochschule Thurgau
- Pädagogische Hochschule Zug
- Università della Svizzera italiana
- Universität Basel
- Universität Bern
- Universität Fribourg
- Universität Luzern
- Universität St. Gallen
- Universität Zürich
- Université de Genève
- Université de Neuchâtel
- Zürcher Hochschule der Künste Zürich
- Zürcher Hochschule für Angewandte Wissenschaften
Aktionslinie Regulatory Framework
Ziel des Projekts Regulatory Framework war es, konkrete, messbare und erreichbare Lösungen vorzuschlagen, um Forscher:innen bei der Sicherung und Wahrung ihrer Rechte im Rahmen von OA-Publikationen zu unterstützen. Um dies zu erreichen, konzentrierte sich das Projekt auf zwei Schwerpunkte: das Recht auf Zweitveröffentlichung und Open Access als regulatorische Herausforderung. Der Projektauftrag war ausschließlich juristisch.
Ergebnisse der Aktionslinie Regulatory Framework

Ziel des Projekts Regulatory Framework war es, konkrete, messbare und erreichbare Lösungen vorzuschlagen, um Forscher:innen bei der Sicherung und Wahrung ihrer Rechte im Rahmen von OA-Publikationen zu unterstützen. Um dies zu erreichen, konzentrierte sich das Projekt auf zwei Schwerpunkte: das Recht auf Zweitveröffentlichung und Open Access als regulatorische Herausforderung.
Ein gemeinsames Projekt der Universität Zürich (ITSL) mit den Universitäten Genf und Basel, der Berner Fachhochschule, der Hochschule für Wirtschaft Fribourg, der Universitätsbibliothek der Universität Zürich und SWITCH hat einen Überblick über die heutige Rechtslage in der Schweiz und europäischen Ländern präsentiert und auf der Basis der Gemeinsamkeiten und Unterschiede mögliche Lösungsvorschläge für ein Zweitveröffentlichungsrecht in der Schweiz vorschlagen. Das Projektteam kommt zum Schluss, dass die Einführung eines zwingenden Zweitveröffentlichungsrechts in der Schweiz sinnvoll erscheint. Die Regelung könnte sich dabei an den bestehenden Regelungen in den Mitgliedstaaten der EU orientieren. Eine Regelung könnte im Verlagsvertragsrecht (Art. 380 ff. OR) eingefügt werden: Das Schweizer Verlagsvertragsrecht enthält eine Regelung, die es Autor:innen an sich ermöglicht, kleinere Beiträge in Zeitschriften jederzeit und Beiträge an Sammelwerke sowie grössere Beiträge an Zeitschriften drei Monate nach dem Erscheinen weiter zu veröffentlichen. Diese Regelung ist allerdings dispositiver Natur. Sie wird deshalb von den Verlagen in der Regel in Verlagsverträgen wegbedungen, mit der Folge, dass die Autor:innen alle Urheberrechte an die Verlage abtreten und damit nicht berechtigt sind, ihre Beiträge erneut zu veröffentlichen. Die Regelung eines Zweitveröffentlichungsrechts für wissenschaftliche Publikationen muss deshalb zwingend sein, wenn sie ihre Wirkung entfalten soll.
Neben dieser Frage wurden weitere regulatorische Herausforderungen im Zusammenhang mit Open Access untersucht: Neben den verfassungsrechtlichen Grundfragen von Open Access wurden die arbeits- und datenschutzrechtlichen Herausforderungen betrachtet. Weiter beleuchtete das Projektteam Fragen des Waren- und Gütertransportes bei Publikationen und bei der Weiterverwendung von Forschungsergebnissen sowie mit Beschaffungs- und kartellrechtlichen Herausforderungen. Die Ergebnisse wurden in einem Bericht zusammengefasst. Zusammenfassend lässt sich festhalten, dass es aus Sicht des Projektteams keine Rechtsgebiete gibt, welche für Open Access wesentliche Hürden darstellen. Vielmehr gibt es bspw. aus beschaffungs- und kartellrechtlicher Sicht gewichtige Gründe, die für die Verwirklichung von Open-Access-Ansätzen sprechen.
Aktionslinie Kommunikation und Sensibilisierung
Die Kommunikations- und Sensibilisierungskampagne ist darauf ausgerichtet, zunächst die Forschenden und in einem zweiten Schritt ein grösseres Zielpublikum über Open Access und dessen Vorteile zu informieren. Der Erfolg der Strategie hängt von der Unterstützung und Beteiligung der Forschenden ab. Dies setzt gleichzeitig voraus, dass die Forschenden korrekt informiert werden und die Umsetzung im Einklang mit ihren Bedürfnissen erfolgt.
SciComOA: Science communication for a lay audience in Switzerland
Project Description
This project was conducted by an interdisciplinary research team led by the Zurich University of Applied Sciences (ZHAW). Its main objective was to improve science communication for the general public through the use of so-called lay abstracts (plain language summaries)– short, accessible summaries (e.g. text, video, audio) of scientific articles designed to make publicly funded research more understandable.
In collaboration with four independent Swiss academic journals
(a) Swiss Medical Weekly,
(b) International Journal of Public Health,
(c) Public Health Reviews, and
(d) MedienPädagogik
the project explored how lay abstracts can be systematically integrated into editorial workflows.
In addition to developing a functional prototype, the project designed a strategic communication concept that accounts for Switzerland’s linguistic diversity. It thereby contributes to the advancement of Open Science by promoting transparency, accessibility, and public engagement with scientific knowledge.
Project Results
The project aimed to investigate and test how to raise awareness and improve access to Open Access lay abstracts in Switzerland by pursuing three key objectives:
(1) prototypical implementation and evaluation of a workflow for creating lay abstracts from highquality articles of four independent, non-profit Swiss journals;
(2) development of a strategic communication concept for addressing lay audiences in Switzerland’s multilingual context; and
(3) discussion of project findings with relevant scientific communities.
Over the course of the project, all three objectives were largely achieved. A structured workflow for the creation of lay abstracts was developed and complemented by a set of recommendations that will guide the implementation of a future project. Findings from the literature review on lay abstracts and science communication were compiled. Empirical findings from surveys conducted with journal managers and authors across the four participating journals for the acceptance and resources around lay abstracts were conducted. In addition, active communication efforts were maintained throughout the entire duration of the project. Team members participated in nine academic conferences, presenting the project and conducting workshops in several cases. The project’s goals – particularly the importance of science communication for lay audiences – were also disseminated through professional channels such as LinkedIn and through scholarly publications.
These dissemination activities played a key role in anchoring the topic within relevant scientific communities and fostering connections with other actors engaged in participatory science communication. There were no significant budgetary changes during the project. Overall, the project successfully delivered its intended outcomes and provided a robust foundation for future efforts in promoting Open Science through accessible research communication.
JOS24: Open Science Days 2024
Description du projet
L’Université de Lausanne (UNIL), en tant que Leading House, a organisé les Open Science Days 2024 du 2 au 5 septembre 2024. Cet événement a marqué une collaboration unique entre quatre types d’institutions d’enseignement supérieur : l’UNIL, l’École Polytechnique Fédérale de Lausanne (EPFL), la Haute École Pédagogique du canton de Vaud (HEP-Vaud) et la Haute École Spécialisée de Suisse Occidentale (HES-SO).
Avec l’Open Access comme point de départ, l’événement a exploré divers aspects de la science ouverte, notamment les données de recherche ouvertes, les ressources éducatives libres et la science participative. Les discussions ont également porté sur des thèmes transversaux majeurs tels que l’intelligence artificielle, la réforme de l’évaluation de la recherche et l’égalité, la diversité et l’inclusion (EDI). L’événement a mis en avant une approche participative et équitable de la connaissance, soulignant le rôle central de la science ouverte pour encourager l’inclusivité et la collaboration interdisciplinaire.
Résultats du projet
Le premier objectif, qui visait à ancrer l’Open Access dans le cadre plus large de la science ouverte, a été accompli grâce à un programme riche et varié qui a exploré les liens entre publication ouverte, données ouvertes et initiatives inclusives, participatives et accessibles. Les participants ont activement débattu des enjeux de l’Open Science et de ses impacts.
Le deuxième objectif, mobiliser la communauté académique, a également été atteint. La collaboration entre les quatre institutions (UNIL, EPFL, HEP-Vaud et HES-SO) a permis de rassembler une audience diversifiée, renforçant les échanges entre chercheurs, enseignants et praticien·nes.
Des bases solides pour une collaboration interinstitutionnelle durable ont été établies. Les institutions participantes ont partagé leurs expertises et identifié des synergies pour renforcer la science ouverte en Suisse romande et se sont accordées sur la pérennisation de l’événement à l’avenir.
Les principaux défis incluaient la coordination entre les institutions et l’absentéisme des personnes qui s’étaient inscrites. Quelques ajustements budgétaires mineurs ont été nécessaires, mais sans impacter les objectifs initiaux. Tout le contenu de la conférence a été rendu disponible en ligne, garantissant un accès pérenne aux idées et engagements générés lors de l’événement (http://opensciencedays.ch/fr/archives/).
OA-Tage
Projektbeschreibung
Die Open-Access-Tage sind die zentrale jährliche Konferenz zum Thema Open Access und Open Science im deutschsprachigen Raum mit jeweils 300-500 Teilnehmer:innen. 2022 hat die Tagung bereits zum 16. Mal stattgefunden und zum ersten Mal seit 2015 wieder (und zum zweiten Mal überhaupt) in der Schweiz. Inhaltlich kamen alle Themen im Zusammenhang mit Open Access zur Sprache. Das Publikum war divers und reichte von OA-Repository-Praktikern bis zu Entscheidungsträgerinnen grosser Institutionen. Dieser Breite wurde bei der Gestaltung des Programms ebenso Rechnung getragen wie der Dynamik der Entwicklungen im Bereich Open Access und zunehmend auch im Bereich Open Science.
Die Universitätsbibliothek Bern hat Personal für die lokale Organisation freigestellt und die Universität Bern hat sich mit einem hohen Beitrag an den Kosten der OA-Tage 2022 beteiligt. Zudem wurden der SNF, die SAGW und swissuniversities als Hauptsponsorinnen der Tagung angefragt. swissuniversities hat sich mit insgesamt 15'000 CHF aus der Aktionslinie Communication and Awareness Raising an den OA-Tagen 2022 beteiligt.
Projektresultate
Die Open-Access-Tage 2022 haben 19. bis 21. September 2022 in Bern stattgefunden. Sie wurden von der Universitätsbibliothek Bern durchgeführt und widmeten sich dem Thema Kollaboration. Neben Key-notes von internationalen Expert:innen fanden Sessions zu den Themen OA- bzw. Kostenmonitoring und Konsortialverträge, Diamond OA, Institutional Publishing, Zweitveröffentlichungen, Bibliodiversität, alternativen Finanzierungsmodellen, Langformpublikationen, Kollaboration von Förderorganisationen, Scholar-led Publishing, Metadaten, und mehr statt. Diverse vom PgB Open Science I, Phase A – Open Access geförderte Projekte konnten sich an den OA-Tagen einer breiten und internationalen Öffentlichkeit präsentieren und in frühen Projektphasen wichtiges Feedback erhalten. Die Videos der Keynotes und der Referate aus den Sessions sind online verfügbar: av.tib.eu/series/1336. Die Folien zu den Referaten sind auf Zenodo dokumentiert: zenodo.org/communities/oat22/records
Aktionslinie National Monitoring
Das nationale Monitoring hatte zum Ziel, die Daten zusammenzutragen, die erforderlich sind, um über die Entwicklung von Open Access in den Schweizer Hochschulen Rechenschaft abzulegen und um die Steuerung der Strategieumsetzung zu ermöglichen.
Vorstudie Kostenmonitor
Projektbeschreibung
Die Delegation Open Science (DelOS) mandatierte das Konsortium der Schweizer Hochschulbibliotheken (CSAL) mit der Durchführung einer Vorstudie im Rahmen der Action Line 3.2.5 «national Monitoring» des Open Science Programms I Phase A (Open Access).
Die Vorstudie soll die Möglichkeiten zur automatisierten Erhebung der Kosten von Open-Access-Publikationen in der Schweiz untersuchen und den Kontext zu internationalen Kostenmonitorprojekten herstellen. Die zu untersuchenden Varianten sind eine Automatisierung bestehender manueller Instrumente (Variante A) und eine Erhebung der Kosten durch die Institutionen (Variante B).
Für Variante A arbeitete das Konsortium mit zwei Experten des Instituts Public Sector Transformation der Berner Fachhochschule (BFH) zusammen.
Die Studie zielt darauf ab, die finanziellen Aspekte von Open Access besser zu verstehen und zu steuern, insbesondere im Kontext der kommenden Förderperiode 2025-2028.
Projektresultate
Das Ziel, die Vorstudie bis Ende 2024 zu finalisieren und der Delegation Open Science zur Verfügung zu stellen, wurde erreicht.
Aktionslinie National Fund
Im Rahmen der Aktionslinie OA National Fund haben 14 Hochschulen einen OA Fund eingerichtet.
OA Fund USI

Project Description
How to make the academic community more aware of the Open Access publishing opportunities? One way is to tackle it from a financial angle. This swissuniversities project, active from 2022 to 2024, aimed at promoting OA publishing by providing funding support for journal articles and books published by USI researchers in fully Gold Open Access venues.
Project Results
The project achieved its objectives and generated several positive outcomes. By offering dedicated funds, it enabled the publication of multiple OA works, thereby directly supporting researchers and encouraging broader engagement with OA models.
While the initiative focused primarily on financial support, it nevertheless played a key role in raising awareness about the different available OA roads, clarifying eligibility requirements, and informing the academic community about available publishing options.
The project also indirectly contributed to a greater use of the institutional repository, promoting the Green Open Access route along with the Gold one. In addition, it fostered closer collaboration between researchers and the University Library’s Open Access Service, helping to establish a centralized point of contact for all questions pertaining to Open Access publications.
A further significant outcome was the opportunity for the institution to reflect on and refine its open science strategy. As a result, a centralized Open Access policy was developed and implemented, laying the foundation for a more coordinated and strategic approach to OA publishing in the future.
OA Fund HSLU
Projektbeschreibung
Die Hochschule Luzern (HSLU) verfolgt mit dem Projekt "OA Fund HSLU" das Ziel, den Anteil an wissenschaftlichen Publikationen im Gold Open Access (OA) zu erhöhen. Gold OA bedeutet, dass Forschungsergebnisse frei und öffentlich zugänglich veröffentlicht werden – ein zentraler Aspekt der Open Science Bewegung. Zu Projektbeginn war OA in vielen Fachbereichen der HSLU noch wenig etabliert.
Um dies zu ändern, wurde ein interner Förderfonds für OA-Publikationen geschaffen und ausgebaut. Begleitend wurden gezielte Kommunikations- und Monitoring-Massnahmen umgesetzt, um die Sichtbarkeit und Nutzung des Fonds zu steigern. Ein besonderes Augenmerk lag auf der Sensibilisierung von Mitarbeitenden in Disziplinen, die bisher wenig Berührung mit OA hatten.
Das Projekt war Teil der nationalen Open Science Initiative und wurde vom Staatssekretariat für Bildung, Forschung und Innovation (SBFI) unterstützt. Es lief von Januar 2022 bis Juni 2025. Die Hochschule nutzte die letzte Projektphase, um den Fonds weiter zu bewerben, die Sensibilisierung der Forschenden für Gold OA zu erhöhen, die Prozesse zu vereinfachen und das institutionelle OA-Monitoring zu konsolidieren.
Projektresultate
Das Projekt "OA Fund HSLU" war erfolgreich: Der Anteil an Gold OA-Publikationen stieg von 28,5 % (2022) auf 33,3 % (2024). Gleichzeitig wurden die Fördermittel deutlich erhöht und der Gesamtaufwand für das Projekt stieg von CHF rund 71'000 im Jahr 2022 auf rund CHF 130'000 in der letzten Projektphase. Diese Zahlen zeigen, dass die Massnahmen wirksam waren und die Sichtbarkeit des Fonds gesteigert werden konnte.
Ein zentrales Ergebnis war die Initialisierung eines neuen, vereinfachten Workflows für die Beantragung von Fördermitteln. Dieser wird den Forschenden den Zugang zur OA-Förderung erleichtern und die Effizienz der internen Prozesse erhöhen. Auch das weitergeführte OA-Monitoring liefert belastbare Daten zur Wirkung des Projekts und dient als Grundlage für zukünftige Entscheidungen.
Die Erfahrungen aus dem Projekt zeigen, dass kontinuierliche Kommunikation und Prozesse, welche die finanzielle Planbarkeit von Publikationsvorhaben begünstigen, entscheidend sind, um Open Access nachhaltig zu fördern. Die HSLU wird den OA-Fonds mit aufgestockten Mitteln weiterführen und die gewonnenen Erkenntnisse als "Good Practice" auch in anderen Bereichen anwenden.
Insgesamt hat das Projekt nicht nur zur Erhöhung des OA-Anteils beigetragen, sondern auch strukturelle Verbesserungen angestossen, die langfristig die Open Science-Kultur an der HSLU stärken.
OA Fund EPFL
Description du projet
Dans le cadre de la stratégie nationale Open Access, swissuniversities a introduit une ligne d’action dédiée au financement de l’Open Access. Celle-ci vient compléter la ligne d’action consacrée aux négociations avec les éditeurs traditionnels.
Le projet financé dans ce contexte a permis de mettre en place des accords nationaux avec des éditeurs entièrement en Open Access. Les négociations ont été faites au niveau consortial : cette approche a permis aux institutions de bénéficier de réductions tarifaires (remises globales) ainsi que d’une simplification des processus administratifs. En outre, le projet a permis un soutien financier couvrant 50 % des coûts des contrats conclus avec ces éditeurs.
Résultats du projet
Tout au long du projet, les objectifs fixés ont été atteints au travers de la mise en place de contrats avec deux éditeurs entièrement en libre accès (Frontiers et PLOS), garantissant ainsi le financement intégral des frais de publication dans les revues de ces éditeurs pour la communauté de recherche de l’EPFL.
Ces contrats ont été largement appréciés et utilisés par les chercheuses et chercheurs de l’EPFL, permettant de plus la gestion simplifiée du soutien financier à l’Open Access par la Bibliothèque. Par ailleurs, ce soutien a contribué à la progression de la part des publications de l’EPFL disponibles en libre accès.
L’un des principaux défis rencontrés est le contexte de contraintes budgétaires auquel l’EPFL, comme de nombreuses autres institutions, doit se confronter.
Afin de garantir la continuité des engagements pris et de préserver les résultats obtenus, une extension exceptionnelle du fonds a pu être obtenue. Cette prolongation s’est révélée cruciale pour maintenir l’élan en faveur de la science ouverte et le soutien aux chercheurs et chercheuses.
OA Fund Uni Lausanne
Description du projet
L’Université de Lausanne (UNIL), fondée en 1537 se distingue par son engagement en faveur de la durabilité, de l’innovation et de l’interdisciplinarité, tout en promouvant l’accès ouvert et l’excellence académique.
Le Fonds national Open Access (OA) vise à concrétiser la stratégie nationale suisse d'accès ouvert, en garantissant que toutes les publications financées par des fonds publics soient librement accessibles en ligne d'ici 2024. Les objectifs du projet incluent l’établissement d’accords consortiaux avec des éditeurs Gold OA pour réduire les coûts et simplifier les processus administratifs, l’encouragement à la création de Fonds institutionnels en accès ouvert intégral, et le développement d’un suivi financier spécifique au Gold OA. Ce suivi est crucial en raison de la complexité des paiements liés à ce type de publication. Ces efforts soutiennent la bibliodiversité et renforcent l’accès ouvert, particulièrement dans les sciences sociales et humaines.
Résultats du projet
Au cours de l’année écoulée et durant toute la durée du projet, plusieurs objectifs clés ont été atteints, mais des défis importants ont également émergé.
Les accords consortiaux avec les éditeurs Gold OA ont permis une réduction des APCs. Cependant, leur gestion, sauf pour PLOS, s’est avérée plus complexe que prévu. La simplification des processus administratifs reste donc relative. Les interrogations concernant l’intégrité et la qualité des éditeurs comme Frontiers et MDPI ont conduit à la résiliation des contrats consortiaux à partir de 2025. Cette décision affectera l’éligibilité de certaines revues, qui dépasseront désormais le seuil de coût.
La promotion du Gold OA via le fonds a été globalement positive. Une majorité du fonds a soutenu des publications dans le domaine médical, tout en finançant des publications longues et plusieurs travaux en sciences sociales et humaines. Aucun retour négatif n’a été reçu concernant le fonds ou les critères d’éligibilité.
OA Fund Uni Basel
Projektbeschreibung
Der Publikationsfonds der Uni Baselwurde in einem Piloten vor Beginn der swissuniversities Förderung gestartet. Er richtet sich an Angehörige der Universität. Seit 2021 wird der Fond auf Forschende eingeschränkt, die den geistes- und sozialwissenschaftlichen Fakultäten angehören. Die Drittmittelfinanzierung von swissuniversities wird genutzt, um Bedarf und Profil der Gold OA Finanzierung an der Uni Basel zu erkennen und für die kommenden Jahre zu entwickeln. Am Ende der Förderperiode wird eine Finanzierung durch Betriebsmittel angestrebt.
Projektresultate
Das Projekt hatte 2023 eine gewisse Verzögerung und Unsicherheiten erfahren. Hintergrund war, dass im Vorfeld der Fond 2021 auf geistes- und sozialwissenschaftliche Fakultäten eingeschränkt worden war. 2022 wurden noch zugesagte Mittel an naturwissenschaftliche und medizinische Fakultäten gezahlt. Erst mit Ende 2023 zeichnete sich ab, für welche Fachbereiche in welcher Höhe Gold OA Finanzierung sinnvoll ist. Basierend auf dieser Beobachtung wurden für 2024 deutlich geringere OA Ausgaben kalkuliert. In Absprache mit swissuniversities wurden die eingangs beantragten Mittel für 2024 seitens der Universität Basel schliesslich nicht genutzt und angefragt, sondern die Mittel kamen der Umverteilung an andere HEI in der Schweiz zugute. 2024 nicht genutzte Mittel sowie noch zu leistende Matching Funds werden an swissuniversities zurückgezahlt. Ab 2025 sind nun Betriebsmittel für den Gold OA Fond für die geistes- und sozialwissenschaftlichen Fächer eingestellt worden. Damit wurden die Ziele, eine Einschätzung für den Umfang eines OA Fonds für die Geistes- und Sozialwissenschaften zu erhalten und die nachhaltige Einrichtung eines Fonds zu realisieren, zwar erreicht, aber eine implizierte umfassende Gold OA Finanzierung für alle Fachbereiche der Universität Basel konnte nicht erzielt werden. Zudem fallen die Bedürfnisse der geistes- und sozialwissenschaftlichen Fächer geringer bzw. anders aus, als erwartet. Für geistes- und sozialwissenschaftliche Fächer sind Buchpublikationen und /oder Diamond OA Publikationen fast wichtiger.
OA Fund Uni Neuchâtel
Description du projet
Le Fonds Gold Open Access UniNE a permis de répondre aux demandes de publication en Open Access de la communauté UniNE de manière adécuate, que ce soit pour des articles ou des monographies. Il n’était utilisé qu’en dernier ressort, c’est-à-dire quand aucun autre financement externe n’était disponible (notamment du FNS via ChronosHub). Il a aussi permis de couvrir les frais d’abonnement à PLOS Journals via l’offre du Consortium qui permet de publier de manière illimitée dans les journaux PLOS. Après un démarrage relativement modeste la première année, le Fonds Gold Open Access UniNE a gagné en notoriété au fil du temps et les demandes n’ont fait qu’augmenter d’année en année, ce qui a finalement permis de mettre à profit l’entiéreté du financement disponible.
OA Fund Uni Bern
Projektbeschreibung
Das Projekt Nationaler Open Access Fonds «Gold Open Access Fonds” 2022-2024 ist Teil des Programms “Open Science I, Phase A” Das Projekt ist unterteilt in Track A und Track B. Track A umfasst konsortiale Verhandlungen mit Gold Open Access Publishern, Track B die finanzielle Unterstützung von Forschenden über den institutionellen Gold Open Access Fonds.
Projektresultate
Das Projekt kann nach Plan abgeschlossen werden. Das Angebot des Fonds wurde universitätsweit genutzt. Im Jahr 2024 konnten 176 Publikationen gefördert und über die gesamte Projektdauer 519 Publikationen unterstützt werden. Die gesprochenen Mittel konnten fast vollständig ausgeschöpft werden. Die universitären Mittel und die Stelle für den Fonds wurden bereits 2023 verstetigt. Ab 2025 erhöht die Universität zudem den Eigenbetrag. Dadurch kann der Fonds nach Beendigung des Projekts zu den gleichen Bedingungen wie bisher weitergeführt werden.
OA Fund Uni Genève
Description du projet
Le projet OA Fund vise à soutenir la transition vers une publication scientifique entièrement en Open Access via la mise en place d'un mécanisme pérenne de financement des frais de publication dans des revues purement en Open Access, que ce soit par des accords consortiaux avec des éditeurs Gold (Track A) ou par des paiements au cas par cas via un Fonds institutionnel (Track B) pour couvrir les frais de publication non inclus dans les accords. L'Université de Genève participe à ces deux tracks.
Résultats du projet
Le projet s’est déroulé de manière satisfaisante, permettant de financer l’ensemble des demandes éli-gibles. Le Track A a atteint son objectif principal : négocier des licences consortiales avantageuses avec Frontiers, PLOS et MDPI en début de projet. Le Track B a pour sa part connu une croissance continue des demandes de soutien, témoignant d’un intérêt notable de la communauté.
Plusieurs ajustements ont été nécessaires en cours de projet. La licence MDPI a été transférée du Track A au Track B en 2023, et les fonds correspondants réalloués à la licence Frontiers. En 2024, sur décision de la Délégation Open Science de SU, le montant alloué au projet Fonds d’Aide a été di-minué de 50’000 CHF et un avenant au contrat a été signé.
Un défi notable a concerné le suivi budgétaire, compliqué par l’absence prolongée de la responsable financière et des projections initiales trop prudentes pour 2024.
Concernant l’objectif de promotion de la biblio-diversité, bien qu’il soit difficile à mesurer précisément, la diversité croissante des revues soutenues et l’augmentation des demandes suggèrent un impact positif.
L’objectif de soutien à la publication en OA dans les sciences humaines et sociales a été partiellement atteint: certaines disciplines ont utilisé les dispositifs, tandis que d’autres sont restées peu engagées.
OA Fund ZHAW
Projektbeschreibung
Die ZHAW betreibt einen Open Access Publikationsfonds für Gold Open-Access-Publikationen (Artikel, Buchbeiträge und Bücher) im Einklang mit den Förderleitlinien von swissuniversities.
Projektresultate
Das Projekt diente der Etablierung eines Förderinstruments für das goldene Modell des Open Access Publizierens an der Hochschule. Alle Mittel wurden verausgabt, weshalb wir die Etablierung des Fonds als erfolgreich bezeichnen können.
Zukünftig wird die ZHAW Zürcher Hochschule für Angewandte Wissenschaften einen Teil der Gelder des Publikationsfonds anderen Open Access Modelle widmen: vornehmlich «diamond», «scholarly-led» und «non-profit» Modelle sollen mit einem Teil des Budgets unterstützt werden. So soll die Bibliodiversität gefördert und dafür Sorge getragen werden, dass auch Verlage und Initiativen eine nachhaltige Perspektive haben, die sich ausserhalb der etablierten kommerziellen pay-to-publish Landschaft bewegen.
OA Fund PH Luzern
Projektbeschreibung
Projektinhalt ist die Finanzierung von Publikationskosten (Article, Processing Charges – APC, Book Processing Charges – BPC und/oder Book Chapter Processing Charges – BCPC) für Gold-OA-Veröffentlichungen, welche den Förderbedingungen gemäss den Spezifikationen der Massnahme OA Fund entsprechen. Das Projektziel der Unterstützung von Open-Access-Publikationen durch die Beteiligung am «Gold Open Access Fund» ist in die Open Access Richtlinien der PH Luzern eingebettet: «Der freie Zugang (Open Access) zu Forschungsresultaten basiert auf der Anerkennung des Wissens als Gemeingut und den sozialen und ökonomischen Vorteilen, die daraus gezogen werden können. Die erhöhte Sichtbarkeit von Forschungsresultaten durch Open Access führt zu einem grösseren Einfluss der Publikationen. Die PH Luzern will das mit öffentlichen Mitteln finanzierte und an ihrer Institution generierte Wissen an die Öffentlichkeit bringen und damit die freie Wissensbildung und die Weiterentwicklung der Bildungsfachleute, Forschenden und Interessierten ermöglichen. Insbesondere Lehrpersonen und die interessierte Öffentlichkeit sollen möglichst einfach an wissenschaftliche Erkenntnisse über das Berufsfeld gelangen.»
Projektresultate
Dank der PgB-Beiträge von swissuniversities konnten Mitarbeitende der PH Luzern bei Open-Access-Publikationen gezielt unterstützt werden. Die grösste Herausforderung ist die anhaltende Nachfrage nach Open Access bei sinkenden finanziellen Ressourcen.
OA Fund PH Bern
Projektbeschreibung
Mit dem Projekt «OA-Fund PHBern» wurde im Rahmen des Programms «Open Science I Phase A» die Einrichtung eines institutionellen Gold-OA-Fund zur Finanzierung von Gold-OA Zeitschriftenartikeln und Gold-OA-Büchern/-Buchbeiträgen an der PHBern initiiert. Mit dem Fund sollten Gold-OA-Publikationen gefördert und deren Finanzierung sichergestellt werden.
Projektresultate
Der Gold-OA-Fund wurde planmässig eingerichtet und in das bestehende Verfahren der internen Publikationsförderung der PHBern integriert. Die Förderbedingungen wurden in Übereinstimmung mit den Vorgaben von swissuniversities festgelegt. Parallel zur Einführung des Gold-OA-Fund traten 2022 die überarbeiteten «Open Access-Richtlinien» in Kraft, die im Sinne der OA-Strategie der PHBern auf eine verstärkte Förderung von OA im Allgemeinen und Gold OA im Besonderen zielen.
Über die Einführung der gezielten Gold-OA-Förderung durch den Gold-OA-Fund wurde über die internen Kanäle informiert und am Zentrum für Forschungsförderung (ZFF) wurde ein Beratungs- und Supportangebot für Fragen der OA-Publikation aufgebaut.
Die Zahl der geförderten Publikationen ist während der dreieinhalbjährigen Projektlaufzeit angestiegen. Während im ersten Berichtsjahr keine Publikationen gefördert werden konnten, waren es in der letzten Berichtsperiode acht Publikationen; insgesamt wurden elf Publikationen (3 Bücher und 8 Zeitschriftenartikel) gefördert. Die Zahl der durch den Gold-OA finanzierten Publikationen blieb damit unter den anfänglichen Erwartungen.
Der Gold-OA-Fund hat zur nachhaltigen Umsetzung der OA-Strategie der PHBern beigetragen. In diesem Sinn wird die Förderung von Gold OA über die Projektlaufzeit hinaus als fester Bestandteil der internen Publikationsförderung im bisherigen Rahmen weitergeführt und durch die PHBern finanziert.
OA Fund HEP-Vaud
Description du projet
Le projet National OA Fund encourage la création d’un fonds institutionnel Gold Open Access centralisé afin de prendre en charge les frais de publication (APCs) pour les auteur.e.s qui souhaitent publier en open access. Ceci a pour but de soutenir la stratégie nationale Open Access qui vise à rendre librement accessible l’ensemble des publications d’ici 2024. Par ailleurs, l’objectif est aussi d’obtenir de nouveaux accords avec des éditeurs Gold OA et ainsi négocier de meilleures conditions pour les auteur. e.s qui publient auprès d’eux et encourager cette voie vers l’Open Access.
Résultats du projet
Le projet a permis à la HEP de créer un fonds Gold OA institutionnel et de participer à des licences
avec des éditeurs Gold OA. Les défis ont porté sur la promotion de cette offre auprès de notre communauté.
La communication sur les conditions à respecter pour bénéficier d’un soutien par notre fonds institutionnel était un enjeu (rédaction d’une directive). En particulier, en ce qui concerne le respect de l’objectif sur la neutralité de coûts visé par le projet. Le respect de l’APC Cap (2'500 CHF) dans la track B du projet était un défi. Dans le domaine des HEPs, il n’est pas rare de recevoir des demandes de financement de publication avec des APCs plus élevés. Plusieurs demandes n’ont donc pas pu être acceptées pour cette raison. Il en va de même pour le financement de monographies en open access où les BPCs dépassent souvent les 8'000 CHF fixé par le cadre du projet.
Concernant le deuxième objectif, certaines négociations avec des éditeurs Gold OA n’ont finalement pas eu lieu, le Consortium ayant renoncé. De plus, aucun dépôt n’a finalement été fait auprès de l’éditeur MDPI car les négociations n’ont pas abouti à des conditions satisfaisantes. Cela a considérablement réduit les dépenses prévues initialement dans la track A.
OA Fund HEP-Valais
Description du projet
La HEP-VS est une institution qui a placé l’OA au cœur de sa stratégie institutionnelle. Le domaine R&D est chargé, au sein de la HEP-VS, de l’accompagnement des équipes de recherche en la matière. Le projet visait la poursuite de la mise à disposition d’un fonds Gold OA pour soutenir la publication en accès ouvert et immédiat des membres des équipes de recherche de la HEP-VS. Par là, le fonds devait servir à favoriser la publication en OA, reconnu comme nouveau standard dans la publication scientifique, et soutenir les chercheuses et chercheurs qui souhaitaient publier des articles scientifiques, chapitres et livres en OA. Le fonds Gold OA devait en cela servir d’outil au service de la stratégie OA institutionnelle favorisant l’ouverture et la transparence des résultats de recherche.
Résultats du projet
Quatre publications (deux articles scientifiques et deux monographies) ont bénéficié du fonds Gold OA. Ce volume modeste reflète néanmoins une évolution significative des pratiques de publication à la HEP-VS. Grâce à un accompagnement ciblé par le domaine R&D, les équipes de recherche manifestent un intérêt accru pour l’OA, perçu non seulement comme une exigence éthique mais aussi comme un levier de visibilité scientifique et académique.
Le principal défi reste d’inscrire durablement l’OA dans les habitudes de publication. Une acculturation est en cours, comme en témoignent les sollicitations plus précoces dans les projets, ainsi qu’une meilleure maîtrise des enjeux et opportunités liés à l’OA. Le fonds a ainsi joué un rôle déclencheur, en amorçant un changement culturel vers une plus grande ouverture des résultats de recherche.
OA Fund PH Zürich
Projektbeschreibung
iOA-Fonds PH Zürich (institutioneller Open Access Fonds iOAF der PHZH, der durch den National OA Fonds mitfinanziert wird von 2022-2024, verlängert bis 30.06.2025)
Projektresultate
Die Projektziele konnten in den vergangenen 1.5 Jahren sehr gut erreicht werden und damit auch über die gesamte Projektdauer. Über die ganze Projektdauer konnte das Prinzip Matching Fund (hälftige Kostenaufteilung HEI und swissuniversities) erfüllt werden.
Bottom-Up Aktionslinien zu vier Schwerpunkten
Im Rahmen der Aktionslinien Setting up of shared services and e-Infrastructures, Participation to international initiative, Alternative forms of publications and Research Assessment wurden insgesamt 18 Projekte gefördert.
SOAP2

Projektbeschreibung
Ziel des Projekts SOAP2 mit der Universität Freiburg als Leading House war die Erstellung einer Publikationsplattform für Diamond Open Access Zeitschriften. Die Plattform wird bei 4science gehostet, und das Projekt konzentrierte sich auf die Befüllung der Plattform mit Inhalten sowie die zur Verfügungstellung von Support für die Zeitschriften. In der letzten Projektphase ging es auch um die Überführung in eine nachhaltige Organisationsstruktur und die Erarbeitung eines tragfähigen Businessmodells.
Projektresultate
Im letzten Projekthalbjahr stand die Überführung in eine nachhaltige Organisationsstruktur, was mit der Gründung des Vereins SOAP2 bewerkstelligt werden konnte. Neben den ursprünglichen Projektpartnern konnte dank der letzten «Journal Load»-Phase, die auch Nicht-Projektpartnern offenstand, weitere Mitglieder gewonnen werden. Durch die Unterscheidung von institutionellen und Kunden-Mitgliedern konnte die Beitrittsschwelle zudem niedrig gehalten werden. Am Ende des Projekts waren schliesslich 23 Zeitschriften auf der Plattform zugänglich, was eigentlich viel mehr ist, als wir ursprünglich erwartet hatten. Mittlerweile sind es bereits 25 Zeitschriften. Einige Zeitschriften konnten leider nicht bis zum Projekt-Ende vollständig migriert werden. Dies lag jedoch nicht an der Unterstützung der Zeitschriften durch das Projekt, sondern an deren internen Organisation. Da die Plattform weitergeführt wird, werden diese Zeitschriften in der Folge auch noch auf der Plattform erscheinen.
Open-SPSP

Project Description
To respond efficiently to outbreaks and pandemics such as Covid-19, open and rapid access of researchers to sequencing data produced at clinical centers is essential, as exemplified by the UK mutation uncovered in December. Currently, national SARS-CoV-2 data hubs organise the flow of viral sequences coming from laboratories all over Europe to a central European portal via the European Nucleotide Archive (ENA). These open resources allow reusing and analyzing the data to researchers world-wide. Unfortunately, Switzerland does not have such a national data hub that facilitates Open sharing of data, likely explaining that less than 600 sequences were published on the Covid-19 portal so far. In order to enable Swiss clinical laboratories to submit in a few clicks, in real-time, their sequences to ENA, we propose to extend the existing "Swiss Pathogen Surveillance Platform", a secure online platform for pathogen sequencing data and their associated sensitive clinical/epidemiological metadata. This will not only allow incorporating Swiss data in research projects worldwide, it will also bring Switzerland within the network of national data hubs for future strategic developments. With this project, we will in particular (i) facilitate the data upload to SPSP to foster near real-time data submissions with optimized e-accessibility. (ii) Develop a module to automatically publish to ENA genomic data and their associated, non-sensitive, metadata. Reciprocally, we will also import into SPSP the genomes available on NCBI/ENA with their limited metadata to enable Swiss researchers to address research questions using the rich metadata on Swiss strains alongside strains collected elsewhere. (iii) Setup a secure computation server with analysis tools, for users with ethical approvals to address research questions on SPSP sensitive data that could not be published on ENA. Altogether, our project will make SPSP data Open when possible, and FAIR where patient-privacy issues apply.
Project Results
For the last reporting period of the project (January 2023), in addition to continuing the open data sharing of SARS-CoV-2 data, we have focused on ensuring longer-term sustainability of SPSP and developing new collaborations for additional data types.
SPSP started discussing in January with the groups involved in viral wastewater surveillance (EA-WAG, ETHZ, FOPH). As the time of this report, the project has officially started and raw genomic data from the viral wastewater surveillance program from 2022 onwards will soon be submitted to SPSP and then published openly on the ENA. This represents 4000 retrospective datasets from 2022 and 50-60 datasets per week for 2023. We have also joined a European working group on wastewater surveillance to ensure compliance with international community standards.
Following discussions started in 2022, SPSP was also now asked to host data from Influenza and RSV. Data should start flowing this Fall and will be published both on GISAID and ENA (contract to be signed soon). The amount of data that will flow through SPSP has not been fully clarified yet.
Lastly, we are also preparing a grant proposal on pathogens of public health interest for the FOPH and FSVO (following discussions started in 2022). This would cover food-borne pathogens and pathogens exhibiting antimicrobial resistance within a One Health perspective for the period 2024-2028. The grant will be submitted end of May.
As discussed above, we have been working intensively on identifying funding sources beyond the project. Currently, funding of SPSP is guaranteed for 2023 for SARS-CoV-2, Influenza/RSV (pending signature), and ESKAPE bacteria. The grant to be submitted to FOPH/FSVO aims to cover the period 2024-2028 for various pathogens. ESKAPE bacteria are covered for 2024. We are continuously seeking additional funding sources.
Due to the rapid scaling of SPSP in sharing thousands of SARS-CoV-2 genomes openly on the ENA, Aitana Neves (SIB) was invited to co-lead a European project on mobilizing SARS-CoV-2 surveillance genomic data into the EU Covid-19 Data Portal. The work consisted in establishing a network of data platform managers (in planning, development or production phases) within Europe and establish capacity building and common good practices in terms of data standards and technical developments, also aligning to international standards. This activity has given great visibility to Switzerland within ELIXIR and EBI/ENA.
DOI3: A new software environment for the registration of DOIs

Project Description
The DOI3 project was carried out between June 2022 and August 2023. The aim was to relaunch ETH Zurichs DOI system, providing an alternative to the usual DOI registration. The system is available to both existing and potential DOI-Desk customers.
Unlike direct DOI registration through agencies like DataCite or Crossref, our system requires data in the Dublin Core metadata format and as XML on an OAI-PMH interface—both widely recognized international standards. The DOI system harvests this data from the interface, converts it into the DataCite Metadata Schema and JSON, and then sends it to DataCite for registration.
The service of harvesting DOIs and their metadata (DOI Desk) versus sending the data to a registration agency (DataCite) is popular among our clients and simplifies the monitoring of errors.
Therefore, when the previous DOI registration software reached its end-of-life, ETH Zurich decided to renew the software environement instead of phasing it out. Within the project, a new software tool was developed and implemented, and all clients were migrated to the new environemont. This ensured that customers of ETH Zurich’s DOI Desk did not need to switch to another way of registering DOIs, which saved them both time and money.
Project Results
The user interface and dashboard are now simpler, more modern and easier to understand. The latest DataCite Metadata Schema was used for mapping metadata from Dublin Core for DOI registration. The DOI management system is more performant and now uses the DataCite REST API, the only interface recommended by DataCite for the future. Since DataCite does not support parallel import, a maximum request rate has been implemented in the new DOI system to prevent overloading the DataCite system. Records sent to DataCite that must wait due to the request rate are marked with the status "Export," indicating their registration status.
Error monitoring has been simplified based on the old system. A list of the most common errors is provided in the user manual, which is available online. The user manual has been updated and adapted for DOI Desk customers.
For the DOI Desk, the new DOI system ensures the continuation of the previous service. While the registration via DataCite is technically out of our hands, the registration via our own application is traceable at almost every step, making error monitoring easier to understand. Additionally, the new system offers significant improvements, including enhanced performance, a more user-friendly dashboard, and visibility of ongoing jobs.
inseri.swiss

Project Description
inseri.swiss aims to allow scholars to create and publish interactive and executable onlinecontent without requiring web development skills.
inseri core is a WordPress plugin developed as part of inseri.swiss project that introduces scientific and interactive components to facilitate open science.
inseri.swiss enables scholars to design and publish interactive and executable online content without requiring web development skills. So that they can publish with ease the research findings in an open, citable and interactive way for effortless reuse by any researcher or the general public. Through interactivity, everyone is encouraged to edit the parameters, use own data, or reuse publicly published data to explore the research findings.
inseri is targeting four use cases:
- Creation of own website for research output to complement traditional research output (PDF publication) with a Web format
- Interactive online tool via visualisation components that allow the reuse also with own data
- Data reuse and integration with data sources such that one can reuse open published data with the previously published online tools
- Data analysis and simulation without the need to set up the computational environment for runnable and reusable components without going into the details of the programming language used for the analysis
As a result, inseri facilitates open access and open science communication.
GOAL

Project Description
The project "GOAL – Unlocking the Green Open Access Potential in scholarly and professional journals in Switzerland" (2022 – 2024) was the common effort of five Swiss higher education institutions (ZHAW, HSLU, FHNW and PH Freiburg) with the support of twelve further ones who formed the Sounding Board.
Led by the ZHAW university library, GOAL had two entangled purposes:
- To expand Green Open Access (OA) among Swiss practice-oriented and professional journals
- To revitalize the so-called "Green Road"—the self-archiving of articles in repositories after they have been published in a journal.
The project specifically focused on Swiss publishers and journals that serve professional audiences. These journals are especially relevant for researchers at universities of applied sciences and teacher education, who often publish in these venues instead of — or alongside — international English-speaking scholarly journals. However, Open Access is less common in this context: small publishers and practice-oriented journals have limited resources and cannot implement costly pay-to-publish OA solutions, operate under diverse business models (e.g. associations, public institutions), and have not been central to OA initiatives, including the Swiss national OA strategy. Nevertheless, they play a vital role in connecting research and practice.
The Green Road offers a low-barrier, cost-effective path to Open Access. It enables researchers to self-archive articles in institutional repositories — infrastructure that already exists in Swiss academia. For small publishers, implementing a self-archiving policy involves no direct costs and requires only minimal adaptation. They can keep their business model and existing workflows while remaining attractive for academic authors.
Project Results
The results of the project fall in three categories:
- Increase the visibility and findability of journals and publications
- Produce helpful materials to foster Green OA
- Advance our knowledge on Green OA as a sustainable solution
We contributed to increase findability and visibility by creating the GOAL database (GOAL :: Home), documenting the outcomes of our negotiations with 106 publishers and journals: 38 new Green OA policies are listed. The database remains a service—new policies can be added by simply contacting us via goal-project@clutterzhaw.ch.
We also added 25 new journals to openpolicyfinder (formerly SHERPA/RoMEO). Likewise, we tested the potential and limits of a semiautomated solution to collect articles from journals with a Green OA policy. The scripts and the related dataset paper are in our Zenodo community: https://doi.org/10.5281/zenodo.10992164
For practical guidance, we published templates for creating customizable Green OA policies in English, German, and French. We also published a set of best practices to negotiate a Green OA policy with publishers. We created a long support guide and a quick one.
Finally, we advanced our knowledge about OA and Green OA by mapping the Swiss publication landscape for the period 2017-2021, and by discussing the potential and the challenges to our work and the limits of our bottom-up approach. We condensed these learnings in many materials such as two journal articles and different presentations. All the materials are available in our Zenodo community: Search GOAL - Unlocking the Green Open Access potentiaL in scholarly and professional journals in Switzerland.
NOAM - Swiss Open Access Monitor

Porject Description
The Swiss Open Access Monitor collects and visualises data on scientific publications written by scientific staff affiliated with a swissuniversities member. It was developed within the framework of the National Open Access Monitoring (NOAM) project, led by the Consortium of Swiss Academic Libraries. The project was half funded by the Open Science programme 2021-2024 and half by the Consortium.
The major aims of the project were:
- Collect data on publications to determine the Open Access share.
- Make Open Access shares visible and data accessible.
- Ensure the future provision of the Swiss Open Access Monitor
Project Results
The website oamonitor.ch is the platform to provide a view of the Open Access shares on scholarly publishing in Switzerland. The NOAM project has been successfully in operation since 2023. The Repository Monitor survey takes place annually with good participation of the swissuniversities community.
The Swiss Open Access Monitor makes it possible to measure and visualise the goal of the national open access strategy of achieving 100% open access. The project page (https://oamonitor.ch/) recorded 1’467 visits, 2.2 actions per visit (page views, downloads, outgoing links and internal searches), 2’949 page views and 68 downloads for the year 2024. For Switzerland, 744 visits were registered, with the Bern region leading the way with 139 visits. The Journal Monitor OAM-CH page (https://oam.oamonitor.ch/) recorded 2’168 visits, 4.2 actions per visit (page views, downloads, outgoing links and internal searches), 2’153 page views, 4’818 internal searches and 500 unique search terms for the year 2024.
The continuation of the Swiss Open Access Monitor is financially supported in equal parts by the consortium and swissuniversities for 2023 and 2024, according to the decision of the steering committee of the consortium and the Open Science delegation. From 2025, the running costs for the maintenance and operation of the Swiss Open Access Monitor will be covered by the Consortium of Swiss Academic Libraries.
AURORA - Automated research output retrieval and self-archiving notification service for authors

Project Description
Self-archiving publications in professionally managed institutional repositories is an effective way to ensure Open Access to scientific research output. Many publishers permit authors to upload a version of their work to such repositories in dedicated policies. Still, this potential has been underutilized so far.
This project aims to address key challenges researchers face with this "Green Route" to Open Access. These include the additional effort required to submit publication data to repositories and the complexity of finding and correctly assessing individual publisher policies.
To overcome these barriers, the university libraries from ZHAW Zurich University of Applied Sciences and FHNW University of Applied Sciences and Arts Northwestern Switzerland developed an innovative automated process. It identifies relevant publications in open bibliographic databases, creates a publication record in the repository and enriches the descriptive information with data on the specific self-archiving conditions from a well-established policy registry. Based on this information, authors are informed about their options.
This solution streamlines the workflow, encourages researchers to archive their work in institutional repositories, and ultimately increases the number of publications available through Open Access.
Project Results
The project focused on the conceptual design and technical development of the components for this automated workflow. As a result, we created two main tools – the Publication Finder and the Enricher – and added an extension to repository software called the Notifier.
The Publication Finder searches the open bibliographic databases OpenAlex and Crossref for works affiliated with the universities, using variations of their names to identify relevant publications. The collected data is harmonized to facilitate the import in the repository after a duplicate check. The Enricher adds information about self-archiving conditions to publication records. For scientific articles, the journal identifier is matched against the JISC open policy finder to determine the applicable policy using certain filter criteria. For book chapters and conference papers, an individually curated CSV file is searched by publisher name. The relevant information is saved in the repository record. Using the Notifier, repository managers can easily send out tailored e-mail notifications to affiliated authors directly from the repository during the routine quality checks.
To ensure versatility, the tools were designed to work independently of specific repository solutions, making them reusable by other institutions. They can also be scaled to meet varying demands by adding new data sources. All code and documentation are openly available on the ZHAW University Library GitHub page.
TOBI - Towards Open Bibliometric Indicators

Project Description
TOBI aimed to identify and to systematically evaluate open bibliometric data sources with the goal to use these open data sources in Switzerland for fair, transparent, and DORA-compliant bibliometric analyses in the future. Possible application could be in the context of research assessment or university management.
The project focused on investigating different quality aspects of open data sources. Amongst other things, the project intended to help identifying critical gaps in open data sources. In addition, the development of a starter kit for Swiss universities containing open-source code was proposed, which should make it easier for institutions to carry out their own bibliometric analyses. Furthermore, stakeholders in Switzerland dealing with open bibliometric data sources were identified and synergies with the “Swiss Year of Scientometrics” (SYoS) were initiated and matured.
TOBI was hosted by the team Research Analytics Service at the ETH Library, which has been providing bibliometric services for ETH Zurich since 2021. The group also delivered SYoS.
Project Results
The following project goals were met:
- Open bibliometric data sources were identified.
- The quality of the data sources was analysed and evaluated.
- Open-source code for bibliometric analyses was developed.
- Stakeholders in Switzerland were identified.
The results can be found on the TOBI website: https://eth-library.github.io/tobi/.
Highlights of the project include:
- The brochure Recommendations for Swiss Higher Education Institutions to enhance the visibility of their research output (https://doi.org/10.3929/ethz-b-000735240) containing practical tips and example cases was published.
- Dederke, J., Koch, M., & Willemin, S. (2024). The Representation of Swiss Higher Education Institutions in Five Bibliometric Databases. Quality in Science, 2024(4), 117-124, https://doi.org/10.3929/ethz-b-000726102
- TOBI Portfolio on GitHub along with an explanatory blog post
SYoS - Swiss Year of Scientometrics

Project Description
Scientometrics – when used in the right context – has great potential to provide important insights into (Swiss) research. The ETH Library has, therefore, launched the 'Swiss Year of Scientometrics' (SYoS), comprising lectures, workshops, and related blog posts.".
The project core aim was to encourage the responsible use of scientometric data and indicators in Switzerland. It specifically focused on the role of scientometric data and indicators in light of evolving demands for research assessment (DORA, CoARA) as well as the increasingly important role of Open Science. One key achievement was to bring stakeholders together to encourage in-depth discussions and engage a wider audience to reflect on the responsible use of scientometrics in the context of open science. In addition, the objective was to propose future measures and best practices.
Project Results
Four lectures and workshops were organised and held as proposed throughout the year. On the initiative of the University of Fribourg, the series was expanded to include a fifth lecture and workshop. The lectures covered numerous aspects of the responsible use of scientometrics. Distinguished speakers were successfully invited to deliver the lectures. The number of participants increased as the project moved along, underlining its success. Moreover, the workshops brought together stakeholders from various universities, federal bodies, and other research institutions, stimulating lively discussions. The SYoS blog helped disseminating the events and reports following the activities.
The diverse range of results can be found, read and revisited on the SYoS blog: https://yearofscientometrics.ethz.ch/.
Openness Score

Project Description
The Openness Score (OS) project, led by Fachhochschule Graubünden (FHGR) in collaboration with Switch and the University of Fribourg (UNIFR), aimed to provide a standardised measure of openness in scientific research. Openness is defined as the extent to which Open Access (OA) resources are used within individual digital objects, including publications, datasets, and software. The project thus addressed the growing demand from researchers, institutions, and policymakers for reliable metrics that assess and promote Open Science.
The core objective of the project was to develop a service and dashboard that enables stakeholders to evaluate the openness of their research outputs. The Openness Assistant provides insights into Open Science practices at individual, institutional, and national levels, supporting academic reporting, key performance indicators, and scientific communication. Alongside the technical implementation, the project also explored the feasibility of a sustainable business model to ensure the long-term viability of the Openness Score service.
Throughout the project, significant advancements in Artificial Intelligence (AI) and Natural Language Processing (NLP) reshaped initial technical plans. The adoption of OpenAlex as a primary data source, combined with the development of high-quality datasets and ad-hoc integration pipelines, allowed for a scalable and efficient solution. While state-of-the-art NLP tools were developed to extract data from research publications, they were not widely deployed due to concerns about costs, reliability, and copyright issues. Instead, the final system integrates OpenAlex data, local repositories such as Folia, and third-party services like OpenAPC, ensuring a robust and scalable approach.
Project Results
The project successfully developed and evaluated a fully functional Openness Assistant tool, which can be accessed at https://openness.switch.ch. The dashboard interface enables institutions to measure openness effectively, providing valuable insights into Open Science adoption. By extending the Openness Score beyond publications to include datasets and software, the project has created a more holistic and meaningful metric for research openness.
The project also conducted a survey within the Swiss research data community, as well as in-depth, semi-structured interviews with key Swiss institutions, e.g. ETH Zurich, the University of Lausanne, SNSF, and SLSP, to assess the proposed openness metrics. The feedback highlighted the importance of standardised openness and FAIR metrics at the national level, aligning e.g. with European Open Science Cloud (EOSC) interoperability standards. The Openness Score team supports this recommendation and proposes a follow-up initiative on standardised metrics, led by the ORD Strategy Council / Delegation Open Science.
The Openness Assistant tool is hosted at and handed over to Switch, with discussions ongoing about integrating it into the Switch Open Data API to further enhance its capabilities. The project team is open to consolidating efforts with other related initiatives, thus furthering their contribution to a coordinated national approach to Open Science monitoring, strengthening Switzerland’s digital sovereignty and research transparency.
HI-FRAME
Project Description
HI-FRAME is an innovative project that promotes Open Science (OS) culture change at the University of Zurich (UZH) and contributes to the implementation of UZH’s Open Science policy.
The overall aim of the project, namely to develop and pilot a tailormade and flexible framework for systematically evaluating candidates’ OS activities in professorial hiring processes, was achieved. The framework, published in German and English on the project website, takes the form of a catalogue of questions that hiring committees can incorporate into selection processes.
The project started on 1 September 2021 and was completed on 31 August 2023 (24 months).
This is the 3rd report that accounts for the period 1 January-31 August 2023, and represents the final report of the HI-FRAME project. Two intermediate reports were submitted on 4 February 2021 and 14 February 2022, respectively.
Project Results
The project represents the first deliberate articulation of the nexus between OS, reforming research assessment and EDI (equality, diversity, inclusion) in the Swiss higher education sector. Over time, this may turn out to be HI-FRAME’s greatest contribution, as the importance of this nexus as a driver of high-quality science with societal impact is gaining ever more recognition (see also question 2 on this point).
In contrast, the HI-FRAME catalogue of questions could not be used in as many real-life professorial hiring processes as the project managers had originally hoped. A significant reason for this appears to be the short project lifetime (24 months). Several faculties that demonstrated in-principle interest in HI-FRAME would not be conducting any professorial hiring processes they deemed suitable for piloting HI-FRAME during the relevant time period, or in one case any hirings at all.
Objectives, milestones and deliverables in the reporting period
The project reached all its objectives and milestones in the reporting period. The corresponding deliverables (in project application: D7-11) were:
D7: The second annual report was delivered to swissuniversities on 14 February 2023
D8, D11: Adaptation, finalization, publication (online) of HI-FRAME catalogue of questions on 28 June 2023 (see question 1)
D9: The project managers presented HI-FRAME at the following events:
«Community-building Workshop on Research Assessment in the transition to OS» 10 January 2023, SNSF (Bern).
This event was a collaboration between HI-FRAME (UZH), the University of Geneva and the SNSF. Input by Dr. Karen Stroobants, Vice Chair COARA (Coalition for Advancing Research Assessment)
«LERU-CE7 Seminar on Research(er) assessment» 16-17 March 2023, Charles University (Prague).
This invitational event for staff and senior leadership at the 23 LERU and its 7 Central- and Eastern European partner institutions served to address contemporary developments in research assessment in Europe, in particular in light of the highly regarded LERU paper «A Pathway towards Multidimensional Academic Careers - A LERU Framework for the Assessment of Researchers» (2022).
«Reforming Research Assessment in an OS environment» 15 May 2023, SNSF (Bern).
This event was a collaboration between HI-FRAME (UZH), the University of Geneva and the SNSF. Input by Dr. Kim Huijpen, program manager for Room for Everone’s Talent, Universities of the Netherlands. The event was also part of the global 10th anniversary celebrations of the San Francisco Declaration on Research Assessment (DORA, see link above).
The project managers participated in the following events (without presenting HI-FRAME):
«Recognition & Rewards Festival» 13 April 2023 (Utrecht, NL/online).
«Journées OS 2023» 8-9 May 2023 (Yverdon-les-Bains/online).
«R&I Community Roll Out of Résumé for Research and Innovation (R4RI)-like CVs: Reflective Gathering and Resources Launch» 21 June 2023 (London).
«OSC23 Conference» 27-29 June 2023 (online).
«Kick-off: CoARA Swiss National Chapter», 11 December 2023, SNSF (Bern).
Moreover, in August 2023 HI-FRAME was published as a case study in the prestigious DORA repository «Reimagining academic assessment: stories of innovation and change».
e-BioDiv
Description du projet
Le projet explore comment les specimens disponibles dans les collections suisse des musées d’histoires naturels et de jardins botaniques peuvent être rattachés à des contenus bibliographiques afin d’enrichir la FAIR-ification des données de biodiversité. Le lien sera piloté par les gestionaires de collection, soit depuis leurs catalogues institutionnels, ou dans la mesure où tous les musées n’ont pas de catalogues informatisée, depuis les notices que ceux ci déposent dans GBIF. En parallèle, les collections bibliographiques de journaux suisses (e.g., Candollea), et en particulier les traitements taxonomiques, dont la curation est effectuée par Plazi, seront déposé dans la bibliothèque «Biodiversity PMC», qui utilie les SIB Literature Services, que maintiennent conjointement la HES-SO et le SIB Swiss Institute of Bioinformatics.
Résultats du projet
L’ensemble des livrables prévus par le projets sont disponibles:
- l’interface de curation des relations specimen-citations est disponible en ligne (https://prod.ebiodiv.org/),
- les articles issus des journaux de biodiversité suisses sont disponible sur Biodiversity PMC (https://sibils.text-analytics.ch/search/),
- ces nouveaux contenus ont été transformés en fichiers JATS XML, le format de références des publications FAIR et BioC, le format d’exposition de la communauté d’analyse des données textuelles.
- ces contenus sont accessibles via nos interfaces graphiques et via les OpenAPI (https://sibils.text-analytics.ch/doc/api/fetch/).
Les services ont été présentés à TDWG 2023, see https://biss.pensoft.net/article/111647/list/8/.
OS-ADM
Project Description
Open Science for Arts, Design and Music (OS-ADM) supports the implementation of the swissuniversities Open Access action plan 2021-2024 in the disciplinary fields of arts, design and music. The implementation of Open Access in the disciplinary fields of ADM is particularly complex due to the use of third-parties content under copyright and the production of multimedia outputs. The project produces guidelines and solutions for a selection of case studies with the support of a legal team, it organizes webinars and training for researchers and administrative staff, it involves Swiss institutions in international networks and it triggers Green, Gold and Diamond Open Access among ADM publishers. OS-ADM involves a network of Swiss schools of ADM: the leading house SUPSI (Ticino) with HES-SO (ECAL, Lausanne; HEAD – Genève; EDHEA, Valais), ZHdK (Zurich), HSLU (Lucerne), BFH (Bern) and FHNW (Basel). It also collaborates with national and international stakeholders: Dariah-EU, Dariah-CH, Creative Commons, Swiss OpenGLAM.
Project Results
All project's objectives have been achieved, all project's activities have been implemented and more activities and results have been produced. The objectives have not been modified during the project. We made some changes to the project's calendar but this didn't effect the results. The budget provided by the partners and their commitment and work was more than expected and planned in the project description. Please find below a table report the project objectives and activities according to the project plan, the project's results and the variations. And please find on https://meta.wikimedia.org/wiki/Open_Science_for_Arts,_Design_and_Music all the documentation of the project and a DMP Data Management Plan providing more information about the project’s outputs.
PLATO
Projektbeschreibung
Das Projekt „Platinum Open Access Funding“ (PLATO) wurde von sechs Schweizer Universitäten
initiiert, mit der Universität Zürich als Leading House. Partnerinstitutionen waren die Universität Bern, ETH Zürich, Université de Genève, Université de Neuchâtel, die Zürcher Hochschule der Künste und die Schweizerische Akademie der Geistes- und Sozialwissenschaften. Als nationale Initiative, die sich der Förderung des wissenschaftsgeführten Open-Access-Publizierens in der Schweiz widmete, hatte das PLATO-Projekt zum Ziel, (1) einen Überblick über die Landschaft von Diamond-Open-Access-Zeitschriften zu schaffen und die Veröffentlichungspraktiken dieser Journals sowie ihre Chancen und Herausforderungen zu untersuchen, (2) die Community der Schweizer Hochschulbibliotheken, der Herausgeberschaften und Forschenden, auf deren Engagement die Realisierung und Weiterentwicklung von Diamond OA in der Schweiz ganz wesentlich beruht, zu aktivieren und (3) Strategien zur nachhaltigen Finanzierung und Unterstützung von Diamond Open Access in der Schweiz zu entwickeln.
Mit der Veröffentlichung der PLATO-Studie (2023; in Zusammenarbeit mit dem Institute for Applied
Data Science & Finance, BFH), die erstmals wichtige Einsichten in das Schweizer Diamond-OA-Ökosystem lieferte, entwickelte das Projekt Empfehlungen zur nachhaltigen Förderung von Diamond Open Access in der Schweiz, die im Juni 2025 publiziert wurden.
Über seine dreijährige Laufzeit konnte das Projekt zwei nationale Events (1. Diamond Open Access
Konferenz 2024; Diamond-Open-Access-Workshoptag 2025), eine Podiumsdiskussion, vier Webinare, drei Community-Events mit Herausgeberschaften und zehn Projektpräsentationen in verschiedenen Kontexten durchführen. Dadurch konnten Akteure sowohl auf Policy- als auch auf Praxis-Ebene zusammengebracht und – unterstützt durch internationale Diamond-OA-Initiativen, mit denen Arbeitskontakte etabliert wurden, – grössere Aufmerksamkeit für das Modell wissenschaftsgeführten Publizierens geschaffen werden. Die PLATO-Projektmanagerin nahm zudem an zahlreichen Workshops und Konferenzen zu Themen im Zusammenhang mit der Open-Access Transformation im Allgemeinen und zu Diamond Open Access im Besonderen teil, um das PLATO Projekt mit nationalen und internationalen Initiativen abzustimmen (z. B. CRAFT-OA, DIAMAS, ELADOAH, ENABLE-OA, OAI13, OPERAS, scholar-led plus, Science Europe).
Projektresultate
Zum Erreichen der Projektziele wurden acht Arbeitspakete definiert, die auf zwei Projektphasen aufgeteilt waren. Arbeitspaket 1 umfasste die Projektkoordination über die gesamte Projektlaufzeit.
Phase 1 (2022-2023):
Die Arbeitspakete 2 und 4 richteten sich auf die Durchführung und Ergebnisanalyse der Studie zur
Landschaft der Diamond OA-Journals in der Schweiz. Die Studienergebnisse wurden anschliessend
veröffentlicht (2023) und in verschiedenen Kontexten präsentiert und mit verschiedenen Stakeholdern (Forschende, Herausgeberschaften, Bibliotheksmitarbeitende, Vertreter:innen von Hochschulen und Forschungsförderern) diskutiert (Arbeitspaket 5).
Phase 2 (2023-2025):
Die Arbeitspakete 3 und 7 zur Aktivierung der Forschungscommunities zogen sich durch beide Projektphasen. In der ersten Projektphase wurde die Kommunikation mit relevanten Stakeholdern aufgenommen: Förderinstitutionen (swissuniversities, SNF), Akademien der Wissenschaften Schweiz, Hochschulbibliotheken (auch solche, die nicht im Projekt vertreten waren), Verlage und Herausgeberschaften von Diamond-OA-Zeitschriften und internationalen Diamond-OA-Projekten und -Initiativen. Die Kommunikation mit den Stakeholdern wurde in der zweiten Projektphase intensiviert, insbesondere im Hinblick auf die Revision der nationalen Open-Access-Strategie. Gleichzeitig konnten auch Kontakte zu drei anderen P-5-Projekten (GOAL, OS-ADM, SOAP2) und zum Konsortium der Schweizer Hochschulbibliotheken geknüpft werden. Insgesamt zeigte sich, dass die Aktivierung und Involvierung von Forschenden (ausser sie sind selbst in der Wissenschaftskommunikation tätig) eine besondere Herausforderung darstellt. Bei Projektvorstellungen im Rahmen von Informationsveranstaltungen für Forschende wurde deutlich, dass sich insbesondere Nachwuchswissenschaftler:innen vor allem an den Vorgaben ihrer wissenschaftlichen Mentor:innen, disziplinären Publikationskonventionen und Policies von Forschungsförderern orientieren. Dies deutet darauf, dass das Publikationsverhalten von Forschenden primär wissenschaftsintern bzw. auf Ebene institutioneller Policies verändert werden kann, während Open-Access-Projekte wie PLATO dabei unterstützen können, die Vorteile von Diamond OA hervorzuheben und wissenschaftsgeführten Zeitschriften mehr Sichtbarkeit zu verleihen.
Die Arbeitspakete 6 und 8 betrafen die Entwicklung von nachhaltigen Finanzierungs- und Unterstützungsoptionen für Diamond-OA-Journals in den Schweiz. Das ursprüngliche Ziel des Projekts, „innovative Finanzierungsströme“ zu entwickeln, wurde während der Projektlaufzeit präzisiert. Durch die Zusammenarbeit mit der Community von Diamond OA-Herausgeberschaften wurde Nachhaltigkeit als eine der grössten Herausforderungen für Zeitschriften bei der Sicherstellung ihres Betriebs identifiziert. Gleichzeitig wurde auch die Bedeutung institutioneller (Hosting-)Infrastrukturen deutlich, die das Diamond-OA-Publizieren unterstützen und Journals helfen, Kosten zu senken. Vor diesem Hintergrund wurde die Zielsetzung angepasst und auf Empfehlungen für nachhaltige Finanzierungs- und Unterstützungsstrategien für Diamond Open Access fokussiert. Nachhaltigkeit war daher auch das Thema der vom Projekt organisierten 1. Schweizer Diamond-Open-Access-Konferenz.
GLOBEQUITY
Project Descritption
The objective of this project was to provide LMIC+-based scientists with equitable access to OA publication of high-quality research papers in two Swiss scientific journals, IJPH and PHR. LMIC+ counties comprised all Research4life A and B category countries plus selected others with limited access to APC funding.
The objective was achieved by offering Article Processing Charge (APC) waivers and discounts to first authors based in qualifying LMIC+ countries. The project aimed to strengthen contributions to the journals from first authors in LMIC+ countries, where the biggest public health challenges lie.
The leading house for this project is the Swiss Tropical and Public Health Institute (Swiss TPH), an associated Institute of the University of Basel and the host institution of the two journals’ editorial office.
The project was undertaken in collaboration with the partner Organization, the Swiss School of Public Health (SSPH+), who own the journals.
Project Results
The project objectives were fully achieved in the past year and across the entire project duration.
At the close of the project period, the GLOBEQUITY program had delivered a total of 125 APC waivers and discounts to LMIC+ author teams. 104 of these waivers and discounts were delivered to authors of papers published in IJPH, and a further 21 were delivered to authors of papers published in PHR. The total value of APC waivers delivered was CHF 243,837.
The GLOBEQUITY program period saw a large increase in publications from LMIC+ authors, as shown in table 1. During 2021 – the first year that IJPH and PHR used a Gold Open Access model and prior to any manuscripts being published with GLOBEQUITY support - 19 LMIC+ manuscripts were published in IJPH and 7 in PHR, a total of 26. This is a relatively low number because authors from LMIC+ countries usually cannot afford to pay APCs. This figure rose to at least 50 LMIC+ publications for each of the years that GLOBEQUITY has been in operation.
For the final year of the project, we applied for and were granted an additional amount of funding. This application was made due to increasing demand for waivers from LMIC+ based authors. The additional funding was used to meet the increased demand for waivers. Demand was such that we had to stop approving waivers and discounts in December 2024.
OA History Education
Project Description
This project aimed to establish a new international, open access, peer-reviewed journal in history education with a particular focus on historical thinking, cultural contexts and educational agency. The journal “Historical Thinking, Culture, and Education” (HTCE) will publish empirical research papers in open access (OA) diamond standard. Three central objectives underlie the proposed journal: (1) the dissemination of high-quality academic productions; (2) a quick turnaround rate; and (3) the necessity of community building and promoting a transnational dialogue. The project uses a OJS tool hosted by Eterna from the library of University of Basel. A team of editors from University of Köln, University of Salzburg, University of Mur-cia, McGill University Montreal, and PH FHNW manage the editorial workflow. A broader editorial board and a board of reviewers accompany the new journal and ensure diversity. Starting in 2022, the HTCE journal will publish two journal issues per year. Main characteristics are Open Access diamond standard, doubleblind review by two reviewers, Early Access publications, and English language.
Project Results
The goals for establishing the new journal have been achieved (see the milestones below). In collaboration with Team Eterna of the University of Basel, we set up the OJS journal platform and developed the front-end content and back-end workflow. Issue 1 has been published, and issues 2 and 3 are on their way (issue 2 is almost finished). We will develop the call for papers for issue 4 with an external co-editor from South America who has expressed interest. As editors, we organized the peer-review process for research papers and provided feedback in the open forum section (miniatures). We successfully built a group of international reviewers, and we have met with our editorial board members twice.
To promote the journal and each issue, we organized three online lecture series, inviting scholars from around the world. An international discourse on history education gained visibility. The project proceeded according to plan, but it took more time than originally scheduled. In particular, the global positioning of the journal and the first call for papers took more time than planned. Additionally, the editorial processes for issues 2 and 3 required a longer turnaround time. We found that the peer review process and the authors' revision phase took more time than planned and that close supervision of the editing of the texts was required. Consequently, the indexing of the journal was postponed and will occur after the publication of issue two.
SMW Platinum OA
Projektbeschreibung
Ziel des Projekts war, für die Diamond-Open-Access-Zeitschrift Swiss Medical Weekly (SMW) eine zukunftsfähige Grundlage zu schaffen und gleichzeitig Lösungen zu erarbeiten, die auch für andere Open-Access-Publikationen anwendbar sind. Dazu wurden drei Arbeitspakete definiert:
(A) Die Entwicklung einer nachhaltigen Open-Access-Informationsplattform, bestehend aus einer neuen Open-Access-Website für das SMW, einem Preprint-Server für medizinische Fachartikel und der Einbindung von sozialen Medien.
(B) Die Entwicklung einer nachhaltigen und skalierbaren Peer-Review-/Publishing-Plattform durch Umstellung des Peer-Review-Prozesses von der bisher verwendeten proprietären Software «Editorial Manager» auf «Open Journal Systems» (OJS). Das SMW-Team mit seiner grossen Erfahrung in der Publikation einer Online-Zeitschrift sollte ausserdem eigenes Wissen über OJS aufbauen, um sich später aktiv im OJS-Netzwerk zu engagieren.
(C) Eine systematische Evaluierung und Optimierung von Open-Access-Workflows, die danach einer breiteren Open-Access-Gemeinschaft auf Wunsch zur Verfügung gestellt werden könnten.
Projektresultate
Das Projekt ist unter Einhaltung des Zeitplans und des Budgets abgeschlossen worden. Alle Projektziele konnten umgesetzt werden.
Ein wichtiger Aspekt dieses Projekts war seine Skalierbarkeit: Die erfolgte Umstellung einer grossen Zeitschrift mit einem umfangreichen Archiv, einer anspruchsvollen Website und komplexen redaktionellen Abläufen auf OJS dient nicht nur dem SMW selbst. Das im Projekt aufgebaute Wissen über die Möglichkeiten, aber auch über die Einschränkungen der verwendeten Tools kann nun anderen Zeitschriften zur Verfügung gestellt werden, die auf Diamond OA umstellen wollen oder die neu gegründet werden.
OAHealthPro
Description du projet
Le domaine Santé de la HES-SO regroupe les Hautes écoles de santé de Suisse occidentale, qui assurent la formation des futur·es professionnel·les de la santé, développent des activités de recherche appliquée et proposent des prestations étroitement articulées aux besoins du système de santé. Le projet porté par le domaine Santé avait pour point de départ la reprise de la revue Mains Libres en vue de sa transition vers une diffusion en open access. À partir de cette base, l’ambition était de créer une plateforme interdisciplinaire destinée à accueillir différentes publications scientifiques dans le champ de la santé. Ce dispositif vise à renforcer le transfert de connaissances vers les milieux professionnels, en facilitant l’accès aux résultats issus de la recherche appliquée. Il contribue ainsi à resserrer les liens entre recherche, enseignement et pratique, et soutient l’innovation, la qualité des soins ainsi que la reconnaissance des savoirs issus du terrain.
Résultats du projet
L’objectif de développer une plateforme Open Access Diamond est atteint depuis janvier 2025. L’accès aux archives de la revue Mains Libres est également désormais possible en Open Access. Les deux premiers numéros de l’année 2025 ont été publiés dans ce format, intégrant pour la première fois des articles en allemand, renforçant ainsi l’ouverture linguistique de la revue. La configuration technique a été réalisée conformément aux besoins identifiés, permettant à la plateforme d’héberger non seulement la revue Mains Libres, mais aussi, à terme, d’autres publications issues des Hautes écoles de santé. La collaboration entre les partenaires s’est avérée efficace, avec une répartition claire des rôles: la maison d’édition a assuré le développement technique selon le calendrier établi, tandis que le domaine Santé HES-SO a coordonné les besoins éditoriaux et institutionnels.
Le comité de rédaction de Mains Libres a été actualisé afin de refléter la nouvelle orientation de la revue. Par ailleurs, un comité de pilotage a été mis en place, intégrant des représentant·es du Comité Recherche et Innovation du domaine Santé ainsi que des associations partenaires.
Les principaux défis du projet ont porté sur sa pérennisation, notamment en raison de la suppression du modèle économique basé sur les abonnements, consécutive au passage en Open Access. Il a donc été nécessaire d’établir des conventions entre la HES-SO et les associations professionnelles partenaires, afin de garantir un soutien financier stable et durable.
Phase B – Open Research Data
Die ersten beiden Ziele der Phase B – Open Research Data haben sich auf die Entwicklung, Einführung und Konsolidierung von ORD-Praktiken, -Infrastrukturen und -Dienstleistungen bezogen. Das dritte Ziel bestand darin, innerhalb der wissenschaftlichen Gemeinschaft das Bewusstsein für die FAIR-Prinzipien und ORD zu fördern und Schulungen in den Bereichen Forschungsdatenmanagement (Research Data Management, RDM) und ORD gezielt voranzutreiben. Das vierte Ziel befasste sich mit Anreizen und Belohnungen für Forschende, den rechtlichen und ethischen Aspekten im Zusammenhang mit ORD sowie dem internationalen Abgleich.
Massnahme A1: Swiss Open Research Data Grants (CHORD)
swissuniversities und der ETH-Bereich organisierten gemeinsam das Programm «Swiss Open Research Data Grants» (CHORD). Diese Zusammenarbeit ermöglichte eine kohärente, breit abgestützte disziplinen- und hochschulübergreifende bottom-up-Unterstützung von ORD-Praktiken in der Schweiz und förderte somit Synergien und Komplementaritäten. Zudem stellte die Zusammenarbeit eine effiziente Verwendung der öffentlichen Mittel sicher.
Track A
Dieser Track umfasste die frühe Phase der Erkundung sowie das Testen und Prototyping für potenzielle ORD-Praktiken. Der Track sollte den Austausch unter Forschungsgemeinschaften fördern, ohne dass zwingend ein Endprodukt geschafft werden musste. Ziel war es, Forschende bei der Untersuchung, ob und wie ORD-Praktiken entwickelt werden können, zu unterstützen.
ORD-Xplore: Finding Commonalities Across Heterogeneous ORD Collections

Project Description
ORD-Xplore is a project led by the University of Zurich (leading house) that focuses on enhancing the FAIR principles in open-research data, particularly in digital editions from the digital humanities domain. This collaborative project involves the University of Zurich, the Center for Digital Edition and Edition Analytics (ZDE), the University Library, and Zentralbibliothek Zürich. It aims to address the issues of bridging heterogeneous and isolated digital editions. Often these editions undergo a massive manual curation to be digitalized, but not every edition adheres to the metadata standards, resulting in a lack of interoperability. ORD-Xplore aims to identify common features across editions, develop a web-based visual interactive tool, and establish future project guidelines. ORD-Xplore’s interface enables temporal, geographical, textual, and connectivity visualizations of digital editions to enhance Open Research Data practices by overcoming the challenges of a lack of standardization and heterogeneity.
Project Results
The progress of the ORD-Xplore project meets all expectations. Work packages WP1-WP3 have been successfully addressed in 2023. In 2024, we met significant milestones by addressing WP4 and WP5. We designed, developed, and deployed ORD-Xplore as a web-based tool, now publicly accessible at ordxplore-ivda.ifi.uzh.ch, making a notable advancement in the project’s dissemination efforts. Before deployment of ORD-Xplore, we ran two user studies (one formative, one summative), both of which revealed important insights and takeaways for the iterative design (WP4) and for the validation and reflection (WP5). The leading house and its collaborators have co-authored scientific articles (one long paper under review and three posters), demonstrating the project’s academic contributions, in line with the work packages. The only unexpected turn of events was a rejected submission of a conference paper with the WP2-4 result (EuroGraphics EuroVis conference). As a counter activity, we now include the results of WP2-5 in an encompassing journal publication (Transactions on Visualization and Computer Graphics) under review, the best journal in the visualization community, for maximum visibility and dissemination.
During the project, stakeholders within and beyond the consortium expressed multiple types of feedback, fostering the iterative design of ORD-Xplore, but also providing a valuable basis for WP5 “Validate, reflect, and form guidelines and requirements”. A notable concretization of the project has been to focus on all 6 out of 14 digital editions that fulfill both criteria: being publicly available and encoded in the TEI-XML standard. The 4th and final workshop on discussion of the results, interpretation, and findings for future work was a great success: We presented ORD-Xplore to the broader expert network, demonstrated its utility, and sparked discussion about possible generalizations, alternative forms of usage, and identified interesting aspects for interdisciplinary future work. Feedback on visual metaphors and unification aspects was positive, but with a desire for increased scalability in the future to integrate significantly more editions. Also, we presented ORD-Xplore at the Scientifica 2023 event, which also led to wider feedback from the public and generated curiosity and awareness of open research data in the digital humanities in the form of digital editions.
As proposed, we also studied the generalizability of ORD-Xplore, also for TEI editions beyond the ZDE Zurich. With the test integration of three external example editions (Arthur Schnitzler Briefedition, An exotic example of Papyri editions, Darwin Correspondence Edition), the project has finished with the confidence that in future work, support for significantly more editions (maybe 20, 40, 60, or even more) will become feasible.
CHORD-talk-in-interaction: Data-sharing skills in corpus-based research on talk-in-interaction

Project Description
Audio-video recorded and transcribed corpora of spoken language in interaction are compiled and used by a diversity of disciplines in the Social Sciences and Humanities. They are particularly complex and offer several challenges when it comes to practices that generate Open Research Data (ORD). This project, funded by the jointly organised Swiss Open Research Data Grants (CHORD) of swissuniversities and the ETH Domain, aimed at identifying the conditions that must be fulfilled in order to prepare and treat audio-video corpora of spoken language in interaction as ORD in a meaningful way.
On the basis of experiences and expertise in the fields of Interactional Linguistics, Conversation Analysis and dialogue-oriented Argumentation Studies, the project members from the Università della Svizzera italiana, Universität Basel, Université de Lausanne and Université de Neuchâtel described and assessed existing ORD practices related to audio-video interactional data. They explored possibilities of improvement with a particular focus on a) researchers’ data-sharing skills related to corpora of spoken language in interaction and b) the Swiss situation. The project members discussed the challenges that these data raise with regard to ORD and what this example reveals more generally about ORD practices as socio-technological practices in the scientific domain. They engaged with the concerned disciplines and communities in a series of workshops and evaluated procedures to disseminate relevant knowledge in these communities.
Project Results
This hybrid workshop closed the project “Data-sharing skills in corpus-based research on talk-in-interaction”. The aim of the event was to present the findings of the project, to assess current practices of sharing and reusing research data under consideration of their technical environments in various fields, to discuss the infrastructure needed in Switzerland to manage audio/video-recorded and transcribed data of naturally occurring interaction, and to address future training needs. The project members developed these topics together with Rita Gautschy (director of DaSCH) and Cristina Grisot (national coordinator of CLARIN-CH) as discussants and the workshop participants were invited to share their experience in several discussion rounds.
CoORDinates: Towards a Consensus-based ORD Standard for the Indoor Positioning Community

Project Description
The community of Indoor Positioning research has identified the need for a paradigm shift towards more reproducible and open research. Accompanying research results with ORD still constitutes the exception rather than the rule in publications of the field. Moreover, since there exist no relevant standards or suggested guidelines, important aspects regarding the data format, the metadata and the overall documentation are typically decided individually by authors. In this project, we map the existing landscape of ORD within the Indoor Positioning community, we collaboratively identify best ORD practices and provide guidelines, moving towards a community consensus on the ORD practices in Indoor Positioning. To achieve these goals, we engaged renowned researchers with extensive track records in ORD sharing and organized public events at the most prestigious forum of this community. The outcomes of the project have provided a tremendous push toward a consensus-based ORD standard for the Indoor Positioning community.
Project Results
The CoORDinates has successfully completed and exceeded its objectives, delivering significant contributions to the Indoor Positioning research community:
- We performed a systematic review of the landscape of ORD in the field, thoroughly analyzing more than 50 features of 119 identified relevant datasets.
- Published a set of ORD guidelines, co-authored by leading experts, which can serve as a reference for the creation of future ORD in the field.
- Achieved significant community engagement, including special sessions at IPIN2023 and IPIN2024 conferences, an oral presentation at the 1st Swiss Reproducibility Conference, and multiple invited talks across Europe.
- Received the 2nd place in the Best Papers Awards at the IPIN2024 conference, recognizing the impact of our work.
- Proposed a new evaluation criterion for the IPIN conference, integrating ORD and reproducibility into the review process (under consideration for adoption).
Looking ahead, we have secured a small follow-up funding (CoORDinance project) to develop a Code of Conduct for ORD in Indoor Positioning, ensuring the sustainability and long-term impact of our work.
ACCORD: Anti-Corruption Consultations on Open Research Data
Project Description
Open government data (OGD) encompasses non-private and non-confidential data produced with state resources and made publicly available without restrictions on use or dissemination. The definition of open research data (ORD) shares common ground with OGD, particularly regarding reuse of data. The Swiss National Strategy on ORD notes that "as a dimension of Open Science, ORD specifically deals with facilitating access to and reuse of research data".
The connection between open data and positive outcomes follows a three-step process: data access, reuse, and impact. Substantial research has been conducted in the public administration field regarding access to governmental-held data, but only recently has scholarship started examining the challenges of data use.
The ACCORD (Anti-Corruption Consultation on Open Research Data) research project fills this gap, particularly in the public integrity domain. We examined open government data reuse for corruption and anti-corruption studies, applying a supply and demand framework. Based on extensive “gray” and literature reviews and experts’ consultations, the project identifies HVDs (High-Value Datasets), understands expert experiences and perceptions regarding open data for public integrity, and determines conditions facilitating systematic OGD reuse. It also evaluates the maturity level of open research data practices within the anti-corruption communities, using a framework that categorizes them from "disordered" to "fully established" research communities.
Project Results
The ACCORD research project assessed how open government data (OGD) is utilized by researchers and practitioners in the field of public integrity. Through comprehensive literature reviews and expert consultations, eight high-value dataset (HVD) types were identified as crucial for anti-corruption research and practice: procurement data, budget information, company registers, asset disclosure, land ownership, extractive industries, lobbying activities, and political party funding. An emerging trend shows increasing interest in asset-related data, particularly beneficial ownership transparency, which provides information about ultimate company owners to help identify corruption and money laundering schemes.
Regarding experiences in data reuse, despite thousands of corruption studies mentioning the use of indicators, few scientific publications explicitly utilize specific open government datasets directly, with procurement data being a notable exception. In our experts’ survey, less than one-third of the respondents used open government data, citing supply-side challenges and contextual factors.
Experts agree that data standardization, enhanced skills, accountability mechanisms using data-driven analysis, government initiatives to promote data access and reuse, and institutional data-minded leadership would increase data use. In terms of open research data practices, most experts view their anti-corruption communities as immature, with a fragmented landscape complicating discussions on data standards and sharing practices.
FIWI: ON The FIWI Video Library Ontology

Project Description
The FIWI-ON project set out to modernize and make publicly accessible the film collection of the Department of Film Studies at the University of Zurich—one of the largest academic film archives in Europe, with over 55,000 titles. Previously stored in a proprietary and outdated database, the collection’s metadata was difficult to access and use for scholarly purposes.
FIWI-ON focused on cleaning, standardizing, and enriching this metadata according to international standards. Nearly 95% of the collection has now been assigned persistent identifiers (PIDs), greatly exceeding initial expectations. The data has also been transformed into a structured, interoperable format, following Linked Open Data and FAIR principles.
The use of PIDs has allowed for extensive data enrichment. In addition to core metadata, users can now access detailed information on directors, nearly 15,000 trailers, and more than 65,000 digitized film posters and DVD covers. This expanded metadata significantly enhances the research potential and discovery of materials.
Importantly, all enriched data is available through a dedicated web interface (https://www.ub.uzh.ch/de/literatur-suchen-nutzen/sammlungen-und-spezialbestaende/filmwissenschaft/katalog-video-und-audiothek.html), making the collection openly accessible to researchers, students, and the general public. This interface not only supports advanced search functions but also integrates with external data sources, providing a rich and user-friendly research environment.
FIWI-ON’s success ensures the long-term sustainability of the film database and serves as a best-practice model for managing and sharing audiovisual collections in academia. It has also laid the groundwork for future collaborations and infrastructure projects in audiovisual research and digital curation.
ORAAD: A Databank for animal allergic dermatitis Open research
Project Description
Many studies in veterinary medicine are conducted by research groups using their own limited patient data. This sometimes leads to partial or biased results. Above all, it deprives the scientific community of the means offered today by large-scale data analysis. The aim of this work was therefore to lay the foundations for a database accessible to the widest possible audience, which could be used for large-scale, multicenter, collaborative studies. The challenges were manifold: we had to develop tools that would enable us to collect objective information in several languages, both on the patient's past and on the development of the disease. We also had to find a host for the databank that could be used by as many research groups as possible. Finally, we wanted to motivate other groups to work with us. But the most ambitious goal was undoubtedly to make a modest contribution to changing research habits, and to encourage people to think in terms of communities rather than individual units. This is the meaning of the term “Open Data research”. The data collected by a group does not belong to it alone but should be available for use by as many people as possible.
Project Results
We have chosen the repository Openbis because this tool was developed for the management of large datasets and large-scale studies. Additionally, this tool was developed by the ETH Zürich what makes it sustainable. We have used our own databank of clinical cases at the basis of our future databank. As this current databank was mainly used internally to follow-up the patients of our unit, it contained relatively little information about the patient's history, lifestyle and diet - information that is fundamental to the study of the underlying causes of the disease. We then developed a questionnaire for owner of allergic patients to record information of the past history of the dog, the way of life, food, clinical signs and treatment before inclusion. This development process included participation of dogs’ owners to ensure that all questions are easily understandable and also the participation of experts to be sure that the questionnaire is comprehensive and valid. This work and the product of this work will be published in article, which will ensure the subsequent promotion and use of this questionnaire by the entire community. In order to ensure that owners will be able to provide updated information on the clinical status of the treated dogs, we are also developing an App. We have already contacted research groups in Europe and in the world to use these new tools at a larger scale.
OMRC: Open Metaverse Research Community

Project Description
The Openverse, launched at the University of Zurich’s Center for Leadership in the Future of Work, is an open, virtual research platform that connects scholars from a wide range of disciplines, including psychology, business, informatics, and communication. Its mission is to democratize access to virtual reality (VR) tools—immersive simulations that replace the physical world with interactive, computer-generated environments—enabling researchers around the world to conduct innovative studies without being held back by financial, technical, or institutional barriers. What motivated this initiative was a widespread issue in the field: many VR studies could not be replicated due to outdated hardware, proprietary or inaccessible applications, and a lack of shared research standards. On top of that, developing a single high-quality VR study from scratch can cost hundreds of thousands of Swiss francs—placing rigorous and innovative research far out of reach for many.
The Openverse removes these barriers and fosters a platform for open, collaborative science. Rather than starting from scratch, researchers can now build on shared resources, join forces with scholars across disciplines, and contribute to a growing ecosystem of immersive research tools. The image below showcases one example of the virtual simulations provided through the Openverse. These simulations are freely available to researchers and fully customizable, including the virtual environment, the appearance of avatars, and even their AI-powered behaviors. But the Openverse is more than just infrastructure; it is an active global community committed to advancing human-centered, interdisciplinary science that improves the lives of people. Together, we explore new ways to study human behavior, learning, and collaboration in digitally mediated contexts, shaping a more inclusive, transparent, and sustainable future for innovative research.
Project Results
What began as a small national initiative quickly grew into a thriving global community. The Openverse has currently brought together over 60 scholars from across the world, spanning leading Swiss institutions such as the University of Lausanne and the University of St. Gallen, as well as top foreign universities including Harvard Business School, INSEAD, and SKEMA Business School. Together, we contribute to a digital infrastructure that empowers scholars to design and run their own studies in VR, eliminating technical and financial barriers for new scholars looking to dive into VR.
A central achievement of our collaboration was the development of VR research protocols that lay the groundwork for more transparent, reusable, and impactful VR studies. These protocols address three critical challenges in the field: interoperability (making VR studies compatible across systems and platforms), procedural standardization (harmonizing how VR research is conducted and reported), and data sharing (enabling replication, extension, and global collaboration). By establishing shared standards, we help researchers replicate and scale their studies across labs, disciplines, and contexts. These protocols are openly accessible here: https://github.com/Openverse-OS/VR-Protocols.
The community’s efforts culminated in a jointly authored manuscript detailing these protocols, which is currently under consideration at a top interdisciplinary journal. Meanwhile, the Openverse continues to evolve as a structured community with dedicated leadership and active interdisciplinary projects that empower researchers to tackle ambitious research questions using cutting-edge immersive methods. Curious to learn more or get involved? Visit: www.leadthefuture.org/openverse
Proto4DigEd: Prototyping Workflows for Digital Editions

Project Description
The aim of the project was to test and further develop prototypical workflows in the conception phase of digital scholarly edition projects. Proto4DigEd tested and documented the use of proven tools (Transkribus, TEI Publisher) within the framework of the planned – and now launched – SNF-project PARES (digital platform of the Gaston Paris archives: https://pares.hypotheses.org/). The involvement of various stakeholders and the national and international ORD community was of great importance; this was achieved through community workshops and participation in relevant conferences.
The project team consisted of the core team of the Leading House UZH, i.e. the project manager Prof. Dr. Ursula Bähler and project coordinator Dr. Elias Zimmermann (both from the Romance Seminar) and the technical expert Reto Baumgartner (Science IT). Three other partner institutions were involved, namely the Centre for Digital Editions and Edition Analytics (Dr. Yann Stricker, UB/ZB), the Zurich Central Library ZB (Marcus Zerbst) and the Swiss National Data and Service Centre for the Humanities DaSCH (Prof. Dr. Rita Gautschy) in Basel.
Project Results
Proto4DigEd achieved all of its initial goals. Specifically, the project tested the functions of the two central tools, Transkribus and TEI Publisher, for the purpose of a digital letter edition, optimised their interaction and documented it. The results are the ‘Handbook for Creating a Digital Edition’ (https://digital-editions.pages.uzh.ch/proto4diged/handbook), an accompanying showcase edition (a separate publication within the framework of PARES, coming in 2026) and the integration of the edition data into the DaSCH database (https://ark.dasch.swiss/ark:/72163/1/0861)
The workflow developed and documented in the handbook contains seven detailed sections: 1. The transfer of image data to Transkribus. 2. The automatic transcription of image data by Transkribus in PAGE-XML format and its correction. 3. Layout markup of the text data in Transkribus using standardised layout rules (basic format of the German Text Archive DTA). 4. Transfer of the data to TEI Publisher, where it can be further processed in TEI XML format (standardised XML according to the specifications of the Text Encoding Initiative). 5. The core editorial work steps in the edition mode of TEI Publisher: content markup/coding of the data in TEI XML, index creation and linking of the indexes to standard databases. 6. Creation of the front end (visual presentation of the TEI XML data together/correlated with the image data) by generating a dynamic app in TEI Publisher. 7. Long-term storage of the data in DaSCH and linking it to the front end.
TechnoPortal: An ontology hosting portal for enhancing data sharing in wind energy

Project Description
The Wind Energy Innovation department at the University of Applied Sciences Eastern Switzerland launched the TechnoPortal project to advance open data and open science across technology disciplines. The initiative pursued two objectives: (1) create a public, production-ready Ontology Hosting Portal that supports discovery, versioning and reuse of information models; (2) cultivate an active community in the wind-energy sector that both uses and extends those models.
To meet the first goal, the team forked the OntoPortal Virtual Alliance codebase, deployed a new TechnoPortal instance, and pre-loaded it with key wind-energy ontologies—covering turbine status codes, structural monitoring, resource assessment and more. Community building was carried out inside the WeDoWind ecosystem. TechnoPortal underpinned hands-on “Challenges” where participants analysed open datasets with Jupyter notebooks that queried portal ontologies via SPARQL. A longer-term governance model was also put in place: domain experts and knowledge engineers collaborate in themed working groups to co-develop data models, schemas, taxonomies and ontologies. TechnoPortal acts as their standard repository, complete with open licensing, persistent identifiers and API endpoints. Together, the platform and its community aim to make high-quality, interoperable information models a routine part of wind energy research, operations and education.
Project Results
- Portal adoption: TechnoPortal went live in mid-202, and now hosts 23 ontologies and 4’082 classes.
- Demonstrated value: During the ASCE-EMI Structural Health Monitoring for Wind Energy Challenge, participants employed a supplied Python notebook to ingest measurement files and query SCADA alarm codes via the portal’s “Wind Turbine Status Alarms and Error Codes” ontology. A post-event survey found that 80% (4 of 5) of respondents reported noticeable time savings in their analyses.
- Community growth: In January 2025 WeDoWind launched an Information Modelling Community anchored by TechnoPortal. The community now counts 300+ members working within seven themed groups. Their flagship deliverable—the Wind Energy Domain Ontology—is under development.
- Knowledge pipeline: Published models are automatically versioned, assigned DOIs and exposed through open APIs, enabling downstream integration in digital twin platforms and education resources. Collectively, the figures, integrations and positive user feedback confirm that pairing a dedicated ontology portal with structured community engagement accelerates data interoperability and innovation within the wind-energy sector.
SIRRO
Project Description
The Center for Reproducible Science at the University of Zurich leads this project on rigorous design, transparent reporting, and reproducible workflows, which are major factors strengthening the interoperability and reusability of research data and are hence crucial to increase the value of research data and, more broadly, the value of research outputs. The Swiss Reproducibility Network (SwissRN) is a peer-led consortium aiming to promote and ensure exactly such rigorous research practices in Switzerland.
The aims of the current project are to 1) fortify SwissRN as an existing community engaging with ORD practices that have the goal of strengthening interoperability and reusability, and 2) intensify the efforts of SwissRN towards a systematic assessment of the impact and obstacles in the implementation of ORD practices. The focus of this proposal is on the ORD practices of preregistration and data management planning as measures to avoid bias and to increase quality.
Project Results
The systematic assessment of the impact and obstacles in the implementation of ORD practices, specifically for preregistration and data management planning, in the SIRRO project was divided into four parts:
Part | What? | How? |
|---|---|---|
| 1 | Assessment of researchers’ understanding and perception of ORD practices across disciplines and their perceived impact on careers | Large-scale, interdisciplinary survey in collaboration with FORS |
| 2 | Assessment of types of research outputs that are already produced and disciplinary differences herein | An exploratory data analysis with publicly available data from the SNSF |
| 3 | Assessment of hurdles and incentives for a community to adopt preregistration and data management practices | Feasibility study on the implementation of preregistration in the field of animal sciences (mandated by the Federal Food Safety and Veterinary Office) |
| 4 | Develop and dispense appropriate training activities on preregistration and data management practices | Cross-disciplinary courses, using the train-the-trainer model, creation of publicly available course materials |
The design of the studies/training events in each of the parts benefited extensively from the project collaboration. All goals have been achieved with some challenges due to hiring delays, technical problems and difficulties with ethical applications. The design of the feasibility study has been changed compared to the initial plans in view of experts’ input.
The SIRRO project was a very successful collaboration and has strengthened the SwissRN community considerably due to the common interest in the outcomes of the four parts.
Moving ORD practices into cancer care
Projektbeschreibung
Dieses Projekt mit Leading House UZH wird ORD-Prinzipien in der Onkologie erforschen Das Projekt zielt darauf ab, die Diskussion anzuregen und die technischen, ethischen und rechtlichen Herausforderungen von ORD im Krebsbereich durch Workshops und Treffen zu bewältigen. Zu den wichtigsten Teilnehmern gehören Onkologen, die Patientendaten in globale Archiven teilen möchten, Datenwissenschaftler, die datengestützte Algorithmen entwickeln, Bioinformatiker, die den ORD-Standards für den Datenaustausch implementieren, und Rechtswissenschaftler, die sich mit den rechtlichen und ethischen Anforderungen befassen. (Aim 1). Das Projekt wird auch eine Pilotinstallation eines etablierten ORD-Ansatzes (Beacon-Technologie) durchführen, um den Austausch von Krebsdaten zu testen. Damit untersucht das Projekt die technischen Herausforderungen bei der Implementierung einer internationalen ORD-Plattform für den Austausch molekularer Krebsdaten (Aim 2).
Projektresultate
Aim 1 Wir haben unsere Erkenntnisse über der Einsatz von ORD in der Krebsbehandlung in einem Workshop am 6 Juni 2024 an der Universität Zürich vertieft. Der Workshop zu offenen Forschungsdaten in der Krebsforschung behandelte zentrale Initiativen zur Verbesserung der Dateninteroperabilität, sicheren Datennutzung und Standardisierung. Andreas Wicki präsentierte das SPO-Projekt, das die Krebsbehandlung durch bessere Datenintegration verbessern soll. Sabine Oesterle stellte SPHN / TuneInsight vor, eine Initiative für sicheren Datenaustausch und personalisierte Gesundheitslösungen. Xose Fernandez sprach über OMOP / MEDOC / Digicore, die sich auf die Standardisierung von For-schungsdaten mit Common Data Models konzentrieren. Louis Fabregas-Ibanez erläuterte die Integra-tion von MCODE / FHIR, um die Erfassung von Krebsdaten durch Interoperabilitätsstandards zu opti-mieren. Michael Baudis präsentierte die Beacon-Technologie, die den globalen Austausch genomi-scher Daten fördert. Der Workshop betonte die Notwendigkeit der Zusammenarbeit und die Nutzung gemeinsamer Datenstandards zur Verbesserung der Krebsforschung.
Aim 2 Dieser Teil des Projektes implementierte eine Lösung für “Data Discovery” Szenarien für genomische und assoziierte Daten anhand des Beacon Protokoll Standards der Global Alliance for Genomics and Health (GA4GH). Hier wurden a) die Installation und Test einer selbstentwickelten, integrierten byconDatenbank auf der Leonhard Med Secure Scientific Platform durchgeführt; b) ein Zugangsmodell unter Berücksichtigung von Sicherheitsaspekten in gemischten Zugangszenarien entwickelt und c) Anpassungen an der bycon Software sowie Prototypisierung von Komponenten für Autentifizierungsfunktionen durchgeführt. Weitere Beiträge bestanden in der Entwicklung eines Workflows zur parametrisierten Generierung eines Testdatensatzes aus heterogenen Forschungsdaten zur Modellierung verschiedener Abfrageszenarien und in der Verbesserung von Daten Im- und Export Prozeduren für bycon sowie der entsprechenden Dokumentation (https://bycon.progenetix.org/).
OMeGA: Open Metadata Generator App
Projektbeschreibung
Mit dem Projekt OMeGA entwickelten die Berner Fachhochschule (Leading House) zusammen mit den Universitäten Bern und Freiburg den Prototypen einer Applikation, um Forschende durch die Erfassung und Beschreibung von Metadaten zu deren Forschungsdaten zu leiten. Ziel war es, fachliche und technische Hürden für das Teilen, Verstehen und Nutzen von Forschungsdaten abzubauen. Das Projekt konzentrierte sich dabei auf Anforderungen und Standards aus den Sozialwissenschaften, da hier sowohl qualitative als auch quantitative Forschungsdaten zu beschreiben sind und gleichzeitig fachliche Anforderungen (Metadatenstandards) weit entwickelt sind.
Die Entwicklung der Applikation erfolgte nach einem agilen, User-Centered Design-Ansatz; parallel zur Entwicklung wurden die Nutzbarkeit sowie die Haltung der Forschungscommunity hinsichtlich deren Verwendung der Applikation erhoben.
Projektresultate
Das Projekt startete mit dem Erstellen einer Übersicht über gängige Metadatenstandards und Forschungsdatenrepositorien in den Sozialwissenschaften. Diese Expert*innen-Sicht wurde durch eine Umfrage bei Forschenden der Berner Fachhochschule (BFH) sowie der Universitäten Bern und Freiburg kontrastiert. Wichtigste Erkenntnis dabei war, dass vor allem ein Bedürfnis nach Informationen zu Sinn und Verwendung erhobener Metadaten besteht; aus technischer Sicht kristallisierte sich heraus, dass Kompatibilität/Integration mit dem Open Science Framework (OSF) anzustreben sei.
In einem zweiten Schritt wurde ein visueller Prototyp in Figma erstellt. Anstelle der im Projektantrag geplanten Validierungsrunde (Fokusgruppen) auf Basis des visuellen Prototyps wurde entschieden, die Validierung in die Entwicklung des funktionalen Prototyps einzubinden. Gründe dafür waren einerseits klare Tendenzen in der Umfrage, die Qualität des visuellen Prototyps sowie Verzögerungen, die sich im Falle einer zusätzlichen Validierungsrunde vor der eigentlichen Entwicklung des Prototyps verschärft hätten.
Entgegen dem ursprünglichen Projektantrag startete die eigentliche Entwicklung des Prototyps erst Ende 2023. Dabei wurde erst ein Prototyp auf Basis von Dspace 7 CRIS entwickelt. Aufgrund der grossen technischen Komplexität und fehlenden Expertise innerhalb des Projektteams, wurde im Frühjahr 2024 der Ansatz verworfen und stattdessen auf eine Stand-alone-Webapp auf Basis von Angular umgeschwenkt. Der Prototyp wurde ab Mai 2024 in mehreren Testrunden durch Forschende der Universitäten Bern und Fribourg sowie der BFH getestet. Auf Basis des erhaltenen Feedbacks wurden diverse Anpassungen und Weiterentwicklungen vorgenommen.
Durch den verzögerten Start in die eigentliche Entwicklungsphase sowie den Abbruch des Ansatzes über Dspace verzögerte sich das Projekt von einem geplanten Abschluss per Ende April auf Ende September 2024.
ORDVET: Open Research Data in Veterinary Medicine
Projektbeschreibung
Mit dem Projekt ORDVET sollte das Bewusstsein für «Open Science» an der Vetsuisse-Fakultät gefördert werden. ORDVET wurde von den beiden an der Vetsuisse-Fakultät beteiligen Universitäten Bern und Zürich getragen. Bern war das Leading House.
Das Projekt hatte zwei inhaltliche Arbeitspakete. Einerseits wurde die Vermittlung von Informationen zu Open Science an Angehörige der Vetsuisse-Fakultät in den verschiedenen Instituten und Kliniken angestrebt. Veterinärmedizinische, naturwissenschaftlich-technische, rechtliche und ethische Fragestellungen wurden adressiert. In der Veterinärmedizin gibt es ein Spannungsfeld zwischen Datenschutz (z.B. in Bezug auf personenbezogene Daten von TierbesitzerInnen) sowie dem Ziel, Forschungsdaten möglichst umfassend und offen zur Verfügung zu stellen. Für dieses Arbeitspaket wurden verschiedene Workshops und Weiterbildungsangebote mit ExpertInnen zum Thema organisiert.
In einem weiteren Arbeitspaket sollte ein Konzept für die Einführung einer standardisierten Nomenklatur für Gewebeproben in der Vetsuisse-Biobank entwickelt werden. Diese standardisierte und einheitliche Nomenklatur soll den Austausch und die Nutzung von biologischen Proben innerhalb und ausserhalb der Vetsuisse-Fakultät fördern.
CF-ORD: Critical FAIRness. An Exploratory Study on Open Research Data in Art and Design
Projektbeschreibung
Das Projekt beschäftigte sich mit Fragen des Zugangs zu und der Nachnutzung von Forschungsdaten in den Bereichen von Kunst und Design. Mit der Hochschule für Gestaltung und Kunst Basel FHNW als Leading House leistete das Projekt, Grundlagenarbeit für den Bereich der anwendungsorientierten Forschung. Anhand von Fallstudien wurde im Rahmen von Workshops die Fragen behandelt, was im Kontext von Kunst- und Designforschung unter Daten verstanden wird und welche Methoden für die Erstellung von Open Research Data (ORD) angewandt werden sollen. Im Projekt wurden zudem existierende ORD-Praktiken und die Anwendung der FAIR-Prinzipien in verwandten und schon weiterentwickelten wissenschaftlichen Feldern aufgearbeitet und auf ihre Übertragbarkeit auf die Bereiche von Kunst und Design geprüft. Das Projekt zielte darauf ab, eine Gemeinschaft an Forscher:innen und Forschungsdatenmanager:innen an Schweizer Kunsthochschulen zu festigen. Eine Website dokumentierte die Projektergebnisse und vermittelte sie an Peer Communities in Kunst und Design.
Projektresultate
Dank einer fünfmonatigen Verschiebung des Projektstarts vom 1.2.2023 auf den 1.6.2023 konnten die Projektziele unter Berücksichtigung der Förderauflagen angepasst und das Projektteam mit Expert:innen aus der Informationswissenschaft und dem Forschungsdatenmanagement sowie Projektpartner:innen anderer Hochschulen ergänzt werden.
Nachdem im ersten halben Jahr die Definition von Daten in Kunst- und Designforschung und die Lancierung von Austauschformaten zu ORD-Praktiken im Vordergrund stand, diente die zweite Projekthälfte der Weiterführung, Festigung und dem Ausbau der Formate – Lesegruppe, Workshops und Symposium – und dem damit verknüpften Ziel des Community-Building. Darüber hinaus investierte das Projekt auch in den Austausch mit anderen bereits existierenden Communities an Universitäten und Hochschulen in Form von Inputvorträgen, Workshopteilnahmen und Peer Review Tätigkeit. Die Projektaktivtäten wurden laufend auf der Website https://critical-fairness.net dokumentiert und an die Peer-Communities in Kunst und Design vermittelt.
Die austauschorientierten Formate des Projekts zielten darauf ab, Forscher:innen und Forschungsdatenmanager:innen an Schweizer Kunsthochschulen zu vernetzen und in ihren ORD-Praktiken zu fördern. Eine Herausforderung bestand in den unterschiedlichen Bedürfnissen von Forscher:innen und Forschungsdatenmanager:innen, ORD-Praktiken entweder aus der Logik der anwendungsorientierten Forschung zu denken oder aus der Logik der existierenden Forschungsdateninfrastrukturen. Diese Herausforderung erforderte ein sorgsames Brückenschlagen und das Schaffen unterschiedlicher Räume, die verschiedene Zugänge erlaubten.
Durch die heterogenen Formate, die den Dialog zwischen unterschiedlichen Anspruchsgruppen aufgebaut und gestärkt haben und als Plattform für die Erarbeitung und Präsentation von ORD-Praktiken dienten, konnten die zwei Projektziele des Community Building und der Förderung von ORD-Praktiken im Projektrahmen erreicht werden.
ord47: Open Research Data for the 7th Art
Project Description
The project acknowledges that archives have evolved from dusty storage spaces to active knowledge repositories in the digital age. Big Data makes them more manageable and accessible, contributing to global cultural discourse. The project focusses on the Locarno Film Festival archives, an exemplary case of cinematographic material archives, particularly critical reviews and related documentation.
These archives, along with those of RSI Radiotelevisione Svizzera in Lugano and Cinémathèque Suisse in Lausanne, hold a significant yet under explored legacy linked to the festival. The project aims to awaken this dormant heritage using open research data, liberating it from traditional archiving. An interdisciplinary, intermedia, and interconnected approach, employing a shared ontology, provides access to archive contents as linked open data (LOD), enhancing their availability and cultural impact.
Project Results
The project reviewed the state-of-the-art of techniques and tools for the organisation of archive data, like the ones that are the objective of the project. This enabled to identify that the best approach involved the use of an ontology. We looked at different ontologies that are currently available and decided to design our own purpose-built ontology using the CIDOC-CRM framework. We also looked and the requirements that were gathered in consultation with the Locarno Film Festival and the RSI Radiotelevisione Svizzera and developed a formal ontology called Ontofest that was populated with data from the Locarno Film Festival archives. An interface for the querying and browsing of the archive was built on top of the ontology enabling access to the data even with vague queries. In this context, we developed a novel approach enlarging the results of an initial query with approximate results, to facilitate finding the starting point of the browsing of all the information contained in the archive. This approach not only enables a user to find the content sought, but also to explore the collection in the process. This mixed approach facilitates the discovery of the vast amount of information hidden in the archives that would otherwise be left there unexplored, as it has been for long time. Finally, we planned a user evaluation of the interface both with simulated users (USI students) and real users from the Locarno Film Festival. Unfortunately, this was only partially completed.
OMNIBENCHMARK: Fostering open continuous method assessment
Project Description
In an increasingly data-centric world, there is an explosion of competing methods to process and model datasets, and it is important to know the relative merits (e.g., performance) of them. By introducing broader patterns of open science practices, including open data and especially open research code, we aim to make method performance assessments (benchmarks) more accessible and impactful to the community. Our initiative, OMNIBENCHMARK, initiated at the University of Zurich, provides a clear path forward to drastically improve all scientific aspects of benchmarking via the "open continuous benchmarkization" concept. The aim of this ‘Explore’ project is to understand how exactly to use and roll out an open benchmarkization strategy primarily in computational biology: we will explore how to best implement ORD practices, linking open code, open data, and metadata, while having benchmarks run in a continuous way.
Project Results
OMNIBENCHMARK needed consider technical development, some of which is still ongoing, before we roll it out to the larger community. For example, even though we have a preprint about the novel OMNIBENCHMARK framework (https://arxiv.org/abs/2409.17038 ), we have not widely advertised its public release because we want to finetune some technical aspects. The scale of the system we are trying to build is unprecedented and extremely ambitious, and we believe the fundamentals of our OMNIBENCHMARK system are now sound. The first release of the software took place in late 2024 (https://github.com/omnibenchmark/omnibenchmark/releases) and we are planning the first major publication in Q2 of 2025. Full community rollout will follow.
VORD
Project Description
The Digital Visual Studies center (DVS) at the University of Zurich leads the Visual Open Research Data (VORD) project, which aims to enhance our understanding of cultural heritage through innovative computational approaches. The project focuses on extracting quantitative information from vast artistic and visual cultural heritage databases, utilizing diverse machine learning models to automatically extract visual features. While these features may not directly connect to iconographic interpretative readings of images' intended meanings, they prove invaluable in bridging distant viewing approaches with in-depth qualitative commentary.
Project Results
Over the past year, the project has made substantial progress in both technical development and community engagement. A significant milestone was reached with our first workshop, held on November 29, 2024, at the University of Zurich. This full-day event brought together key stakeholders and featured comprehensive demonstrations of the VORD platform, followed by focused discussions on applications in art history and museums. The workshop's structure, moving from technical demonstrations to practical applications and concluding with broader discussions about approaches for Digital Visual Studies, helped validate our development direction while gathering valuable community input. The team, led by Dr. Darío Negueruela del Castillo and including specialists in both computational and art historical approaches, has successfully developed an initial pipeline for extracting multiple layers of information from cultural heritage databases. This achievement represents a crucial step toward our goal of creating more accessible and interoperable systems for visual art research. Looking ahead, we have secured a presentation slot at the upcoming XI International Conference on the Histories of Media Art, Science and Technology in May 2025, where we will showcase our platform's capabilities to a broader audience. Additionally, we have scheduled our second workshop for March, which will build on the insights gained from our first event and focus on practical implementations of our developing tools.
OSIReS
Project Description
The project addresses reproducibility challenges in geospatial research based on data accessed via geoservices. Current standards used to publish geospatial data on the Web (such as OGC standards) lack functionalities to retrieve persistently and immutably a dataset as it existed at a specific point in time. This prevents researchers from ensuring that analyses can be replicated with the exact same dataset. The project investigates and proposes an extension to these standards to enable time-versioned access to data and implements a prototype demonstrating the solution. The consortium is coordinated by SUPSI (Leading House), which focuses on time-series and sensor data. HEIG-VD contributed expertise on vector and cadastral datasets, while UNIGE focused on raster and satellite data. By developing an open, interoperable and containerised infrastructure, the project lays the groundwork for reproducible research based on FAIR geospatial data services.
Project Results
The project defined three main objectives, addressed in two operational work packages, each of which has been successfully addressed:
1- Engagement with communities and stakeholders
This objective has been achieved. Through the establishment of surveys and interviews, the project actively involved a wide range of stakeholders and user communities. Their contributions were essential in identifying specific requirements and proposed solutions.
2- Proposal of standard extensions and best practices
This objective has been achieved. Based on the results of the engagement activities the project identified different solutions to cope with non-guaranteed persistence of OGC web services for the three geodata types (vector, raster, sensor). For sensors a new standard extension has been proposed, while for raster and vector a best practice has been suggested. These contributions have been shared with relevant communities for further adoption.
3- Implementation of a containerized prototype solution
Partially achieved. A new containerized solution for FAIR data management has been fully implemented for sensor data only. For vector and raster data types UNIGE and HEIGH-VD defined respectively best practices to apply to existing software and standards.
Challenges was related to stakeholder engagement but no major change to objectives has been necessary.
E-Specimens
Projektbeschreibung
E-Specimens unterstützt Forschende bei der Anwendung von Open Research Data (ORD)-Praktiken im Umfeld von Naturhistorischen Sammlungen. Dieses Projekt E-Specimens untersucht und thematisiert die integrierte und vernetzte Verwaltung von Forschungsdaten unterschiedlicher Form, welche aus vergleichenden organismischen Projektstudien stammen und bisher in getrennten Portalen und Archiven dokumentiert wurden. Das Projekt zielt darauf ab, diese Lücke in den Praktiken in Open Science zu schliessen:
- Erstellen einer Bedarfsanalyse mit Befragung von Forschenden sowie Verwaltenden von Portalen und Archiven verschiedener Disziplinen, und Diskussion von möglichen Verfahrensprotokollen.
- Sensibilisierung von Forschenden aus verschiedenen Disziplinen für die integrierte ORD-Agenda durch strukturierte Interviews mit einer Auswahl von Interessensgruppen, sowie durchführen von einem Symposium mit Forschenden und Datenportal-Verwaltenden.
- Symposium zum Thema von ORD im Umfeld von Naturhistorischen Sammlungen.
- Implementierung einer proof-of-concept Lösung zur Anwendung durch Implementierung, basierend auf einer Auswahl von realen Projekten im angesprochenen Forschungsgebiet, umgesetzt.
Projektresultate
Die Projektziele fokussierten sich schlussendlich auf (1) Präsentationen und die Durchführung von zwei Symposien mit vielfältigen Beiträgen einer breiten Palette von eingeladenen Beitragenden (die Programme der beiden Symposien sind nach wie vor nicht auf http://www.e-specimina.ch/ aufgeschaltet, was in den nächsten Wochen nachgeholt wird) und (2) aus den durch diesen Austausch gewonnenen Erkenntnissen der Implementierung eines Arbeitsprotokolls für die nachhaltige Dokumentation der Beprobungsereignisse in Naturhistorischen Sammlungen und Publikation auf entsprechenden Portalen (i.e., Zenodo.org). Mit diesen Diskussionen unter verschiedenen Vertretern der «stakeholder representatives» wurde deutlich, dass an einer wirkungsvollen Umsetzung der ORD Agenda im Bereich der Naturhistorischen Sammlungen sowohl die Sammlungshaltenden (Dienstleistende) wie auch die Forschenden (NutzerInnen) gefordert sind und ihren Beitrag leisten müssen. Das ausgearbeitete Arbeitsprotokoll und die angestrebten konkreten Fallstudien zu deren Illustration sind noch in Arbeit und werden unter www.e-specimina.ch publiziert. Bedingt durch Nichtverfügbarkeit von Mitarbeitenden und unterschiedlicher Schwerpunktlegung der Arbeiten besteht noch ein Bedarf für Nacharbeiten.
Auf die Implementierung eines weiteren Rechercheportals, wie ursprünglich Projektantrag beschrieben, wurde verzichtet. Stattdessen wurde ein Jupyter Notebook in der Programmiersprache Python implementiert mit dessen spezifischen Adaptation für die individuelle Forschungsfrage eine nachhaltige Dokumentation der Recherchearbeit im Sinne von ORD protokolliert werden kann. Die Akzeptanz der Nutzung von Python als Skriptsprache für eine solide Dokumentation von Forschungsrecherchen muss weiter gefördert werden.
Wegen personellen Engpässen bei unserer Finanzverwaltung konnte der Finanzrahmen für dieses Projekt nicht ausgeschöpft werden. Die Rekrutierung von geeigneten Fachpersonen erwies sich für dieses Projekt als schwierig, Die noch zu leistenden Arbeiten für eine nachhaltige Umsetzung der Projektziele liegt nun am mir und einem noch zu bestimmenden Progammierer. Diese Arbeiten werden aus eigenen Mitteln weiter vorangebracht.
ORoDaPT: Open Rock Glacier Data Production Tools
Project Description
The ORoDaPT project aimed to promote ORD practices in the field of rock glacier studies and more specifically to produce Rock Glacier Inventories (RoGI) and Rock Glacier Velocity (RGV) products. The main objectives of the ORoDaPT project are 1) the development of prototype tools tailored for the collection, processing and analysis of rock glacier data products, 2) the set-up of a data management structure (DMS) beta version for archiving, visualisation and dissemination of rock glacier data products and 3) the compilation of training and outreach material for the development of rock glacier data products. Those actions are embedded within several research initiatives and communities (the International Permafrost Association IPA, the Rock Glacier Inventories and Kinematics standing committee RGIK, the global terrestrial network for permafrost GTN-P and the Swiss Permafrost Monitoring Network PERMOS) in which the University of Fribourg, leading house of the project, has been actively involved for many years.
Project Results
The project objectives have been mostly successfully completed. Due to the short duration of the project, one big challenge was to set up the project team quickly and to be efficient from the start. This was facilitated by the existing collaboration amongst the project team. Another important challenge was the interdependence of the objectives (1 and 2), which meant that any delay was reported to the following task.
Objective 1 (development of tool for RoGI and RGV) was fully completed. An operational tool for RoGI compilation was finalized and tested by experts during the ORoDaPT project. It is available online on the RGIK community website https://www.rgik.org/wp-content/uploads/2025/02/RoGI_template_gpkg_QGIS.zip. For RGV, a prototype tool was developed and tested by expert and students during the project. A beta version is available on a Git platform https://renkulab.io/p/cecile.pellet/rock-glacier-velocity
Objective 2 (development of data management system for RoGI and RGV) was partially completed. A prototype database was setup on the UNIFR server directly linked to the RoGI tool.
Objective 3 (compilation of training material) was fully completed. The ORoDaPT project supported the development of the RGIK community website and funded the RGIK office, which coordinated the RGIK activities, organised monthly seminars and supported the community. For RoGI, a test exercise and corresponding data set were published (accepted) and the guidelines have been submitted as research paper (in review). For RGV, the prototype tool is complemented by a thorough documentation and guidelines are currently in development.
DAMOCLES: Data Management Concept for Underground Laboratories
Project Description
The BedrettoLab is a world-class research infrastructure of ETH Zurich with unique geological condi-tions. This deep underground laboratory is an unparalleled resource to investigate, test and demonstrate intricate processes of the subsurface. Such field-scale laboratories are needed to advance scientific knowledge in domains such as geothermal energy, earthquake physics, and geobiology. Equipped with state-of-the-art monitoring systems, BedrettoLab produces large data streams, which requires a data management strategy to handle near-real time monitoring. The objective of this proposal is to develop a data management concept tailored to the needs and requirements of under-ground laboratories. This includes establishing a systematic data flow, from acquisition, transfer, and storage to documentation and dissemination, to produce FAIR data from large-scale experiments. Key aspects are a data governance framework for how data is acquired, stored, processed, and shared among underground labs, as well as identifying tools, procedures, and methods for data management tasks.
Project Results
Underground laboratories produce data streams, which are continuous flows of data generated by di-verse sensors and processed in real time. Data streams, unlike traditional research data, are neither discrete nor static data sets, and this poses several challenges. The first challenge was to streamline data and metadata acquisition, because some data types have no community-approved standards. Therefore, we focused on seismic data for which well-accepted data and metadata standards exist; we are now assessing to what extent those standards were applicable to other data for future implemen-tations. One more challenge was the data transfer from the lab to ETH Zurich data centre, which re-quired a reliable network and a strategy to process data before transfer. Another important challenge is that underground labs require a large storage capacity (about Petabyte per year). Such costs must be considered in the data management plan.
PCaMiner
Project Description
The goal of this project was to update a harmonized RNA sequencing atlas and establish a user-friendly web tool for researchers and clinicians in academia and health care to accurately investigate gene expression changes related to prostate cancer progression and therapy resistance in a customized and multidimensional manner. Indeed, we achieved both goals, the updated atlas with 1365 samples is browsable under: https://prostatecanceratlas.org/app/home. Apart from the bulk RNA sequencing atlas, we have also started to engineer a single-cell atlas culled from 183 patients. The latter is also displayed under the same URL.
OpenSWICE
Description du projet
Dans le contexte du consortium interdisciplinaire SWICE du programme SWEET, l’institut Human-IST de Université de Fribourg, en collaboration avec l’EPFL, a piloté le projet OpenSWICE. L’objectif principal du projet était d’explorer, développer et instaurer sur le long terme des pratiques de gestion et diffusion de données de recherche ouvertes (ORD) dans un contexte très hétérogène et interinstitutionnel.
Le projet a suivi une approche en quatre étapes:
- analyse des besoins des partenaires;
- élaboration de pratiques ORD respectant les besoins des partenaires et basés sur des principes FAIR;
- développement d’un outil pour la simplification du traitement et de la diffusion des données;
- consolidation des pratiques ORD pour assurer leur utilisation au sein du consortium SWICE sur le long terme.
La publication des ORD en ce contexte est essentielle, car les résultats du projet SWICE peuvent influencer des décisions politiques; il est donc important que ces résultats soient transparents.
Résultats du projet
La majorité des objectifs fixés ont été atteints pendant la durée du projet. Les besoins d’une partie des partenaires de SWICE en termes de ORD ont été identifiés via un workshop sur les données et une enquête. L’établissement d’une première version de lignes directrices pour l’anonymisation, le traitement et la publication a permis de structurer une démarche commune, facilitant la publication en ORD. Cette approche visait à surmonter des obstacles fréquents, comme la difficulté de garantir l’anonymisation ou la qualité des données. Un outil a été intégré dans un système de collecte de données du projet SWICE, pour standardiser et simplifier l’anonymisation automatique, la structuration, et la diffusion. Bien que cette preuve de faisabilité ne couvre pas tous les types de données du consortium, elle est utile pour une large partie des partenaires concernés. Un “data officer” a été mobilisé pour consolider ces pratiques jusqu’à la fin du projet. Il rappelle l’importance des ORD et accompagne les partenaires de SWICE à chaque nouvelle publication. Un des principaux défis a été de convaincre les partenaires de l’importance des ORD. Une bonne communication et la proposition d’une enquête (en alternative à un workshop avec peu de participants), ont permis une participation plus réussie. Aucun changement significatif n’a été apporté au budget ni aux objectifs initiaux. Une extension de quatre mois a été obtenue pour la fin du projet afin de permettre une collecte de donnée hétérogène pour tester l’outil d’exportation ORD.
Semantic TEI: Semantic Text Publishing as Open Research Data
Project Description
Semantic TEI Project has improved the potential for open research data practices in the field of digital editions and other humanities specialisations dealing with text. It has worked with the de-facto standard for scholarly text – the Text Encoding Initiative (TEI) – to create a data model that allows researchers to publish their textual data in the context of the Semantic Web. This permits the data that digital editions create to be published as Linked Open Data – resources on the web that can be referenced by others for the purposes of enrichment. This capability allows research data in the humanities to become more connected where datasets can be leveraged in the process of exploration that generates new research, and as part of reference resources for scholars.
The data model has been published and can be accessed here: https://zellij.pythonanywhere.com/docs/list/appsyBKDmummlKLOr?flag=0 and here (as part of the AAAo ontology): https://ontome.net/namespace/120
The project has also developed a data transformation pipeline which will be published in the coming weeks.
Semantic TEI project was conducted with the USI as the leading house, Dr Elena Chestnova having been the main responsible grantee. The partnership included the Swiss Art Research Infrastructure at the University of Zurich, gta Digital at the ETH Zurich, Walter Benjamin Kolleg at the University of Bern, the Swiss National Centre for Data and Services in the Humanities, and the Academy of Sciences and Literature in Mainz. The work was funded by Swissuniversities in addition to own contributions of participating institutions.
Project Results
The achievements of the work packages 3, 4, and 5 have exceeded the originally stated aims. We have developed and published the ontological framework for scholarly edited text based on the TEI standard (here and here as part of the AAAo ontology). In the course of the project it became clear that the content of the work package 5 would profit from being extended to development and publica-tion of a complete and re-usable ETL pipeline. This work went beyond the scope of the originally de-fined project and has been financed by funds from the Semper Edition project funded by the SNSF. It is anticipated that the ETL pipeline will be published in the coming weeks. Staffin challenges meant that the work on the ontological framework could not be completed before October 2024. This meant that the final stages work package 2 (community consultation) had to be postponed. Community feed-back on the published ontological framework and the ETL pipeline will be collected during the DARIAH Editions Working Group Event on 26 June in Bern. The costs of this will be covered by the partner institutions. The publication of results (work package 6) has begun in the form on online publications and conference presentation at the CIDOC conference in Amsterdam (November 2024). This will con-tinue in the coming year, with costs being covered by partner institutions.
OHiS: Oral Health in Switzerland
Projektbeschreibung
Die Mundgesundheit ist ein wichtiger Indikator für die systemische Gesundheit und die Lebensqualität. Die kausalen Zusammenhänge sind jedoch erst wenig bekannt. Um diese Wissenslücke zu schliessen, schlägt das Projekt "Oral Health in Swit-zerland" [OHiS] eine innovative Forschungsstrategie zur Mundgesundheit vor, die auf den Prinzipien offener Forschungsdaten basiert und die Schweizer Universitätszahnkliniken in Zürich, Basel und Bern miteinander verbindet. Ziel ist es, eine universitäre Forschungsplattform mit einer webbasierten Netzwerklösung zu entwickeln, um epidemiologische Bevölkerungsstatistiken zur Mundgesundheit in der Schweiz zu erstellen, zahnmedizinische Risikofaktoren zu identifizieren, die Korrelation zwischen oraler und systemischer Gesundheit zu bestimmen und somit schliesslich personalisierte Gesundheitsprognosen zu ermöglichen.
Projektresultate
Track-A "Explore-Projects" war für das Team aus Zürich-Basel-Bern die Basis für die Planung zum Management digitaler Gesundheitsdaten in der zahnmedizinischen Forschung. Initial hat das Team die Standards der Gesundheitsdaten definiert, gefolgt von der Diskussion zu den IT-Anforderungen für Sammlung, Speicherung, Nutzung dieser Daten. Hierbei wurden ebenso die Schnittstellen innerhalb der Universitätszahnkliniken bestimmt sowie zu anderen Stakeholdern im Gesundheitssektor. Eine bestmögliche Plattform scheint hierfür die in Zürich-Basel-Bern bereits etablierte Software REDCap zu sein. Dieses ist eine lizensierte web-basierte Lösung für elektronische Case-Report-Forms in der klinsichen Forschung. Der Zugang aus den einzelnen Zentren, die Frage nach der Datensicherheit, und die Speicherkapazität sind durch die Software selber gesichert.
Im Gegensatz zu punktuellen Datenerhebungen einer klassischer epidemiologischen Untersuchung liegt der Fokus beim OHiS-Projekt auf die kontinuierliche Datengenerierung bei einer festen Kohorte (9 Jahre). Dieses ist eine grosse Herausforderung für die Implementierung: (1) Bereitstellung/Finanzierung von Fachpersonal für die Untersuchungen; (2) Motivation/Incentives für die Studienpopulation; und damit verbunden (3) Lokalisation der Unterschungen (zentral/dezentral).
Das Team sieht insbesondere Herausforderungen in der Dauer der Studie und in der Grössenordnung: Gemäss statistischen Berechnungen wäre eine Kohorte von 6'000 Studienteilnehmern die Mindestteilnehmerzahl. Eine zahnärztliche Untersuchung (klinisch/digitale Abformungen/Fragebögen) würde pro Teilnehmer:in 30min in Anspruch nehmen. Kalkuliert man wiederholende Untersuchungen alle 3 Jahre mit Drop-out Quoten von 20%/30%/40% nach 3/6/9 Jahren, ergibt das in toto 9'300 Arbetsstunden (4.5 Jahre 100%-Anstellung).
Das Projektziel war die Analyse zur Machbarkeit. Dieses Ziel wurde erreicht. Es wurden keine Veränderungen am Budget vorgenommen. Im Anschluss an diese Konzeptphase ist nun die Implementierung des Projekts inklusive Drittmittelfinanzierung geplant.
Exploring ORD Practices in the Context of Collections as Data
Project Description
The project is a collaboration between Prof. Dr. Elliott Ash (ETHZ, Center for Law & Economics) and ETH Library. The project contributed to the promotion of ORD practices that foster access to and (re-)use of highly valuable digitized collections for the demands of modern, innovative digital research in the 21st century. To this end, the project focused on the general topic of collections as data and contributed to i) strengthening interdisciplinary ORD communities around collections as FAIR data, ii) prototyping of relevant tools to improve data literacy and iii) discussions about potential legal and ethical challenges.
Project Results
During the duration of the project, it became highly apparent that the project addresses a topical issue that will continue to gain importance in the future. With the rapid development of AI, discussions about access to high-quality data, community building, strengthening data literacy, and legal and ethical issues have become increasingly important. In its specific context at the intersection between GLAM institutions and research the project successfully increased the ORD related interdisciplinary awareness and co-operation of the target stakeholders:
Community building:
- creation of a project website as central information hub
- contributions to community relevant conferences and continuous education programs
- contributions to the successful establishment of a GLAM focused working group within DARIAH-CH
- co-operation with SwissAI initiative
- public closing workshop with >40 participants from different fields and from all parts of Switzerland
Data literacy:
- conceptualization and realization (2 rounds) of a six-day course “Introduction to programming and natural language processing (NLP) for the Humanities” (total >30 participants at different career levels and different background (MA/PhD students, GLAM experts), excellent evaluation results)
- conceptualization, realization and publication of interactive data stories
Legal and ethical issues:
Legal and ethical issues were addressed as part of the community building and data literacy activities. However, due to the still complex situation regarding AI and data reuse, we had to refrain from the planned use case based legal opinions (see below). Freed-up resources were allocated to further develop the course content as well as the data stories.
Track B
Track B unterstützte die Etablierung von bestehenden ORD-Praktiken, die auf einer Forschungsagenda und einem gemeinsamen Verständnis der ORD-Prinzipien basieren. Track B bot die Möglichkeit, solche Praktiken auf die nächste Stufe zu heben, ihre Reichweite auszubauen und Projekte zu entwickeln, die das Potenzial haben als de-facto-Standards innerhalb einer Gemeinschaft die Qualität der Forschung zu fördern.
enviPathPlus – Fostering Interdisciplinary Sharing and Usage of Chemical Biodegradation Data

Project Description
enviPath is an online platform dedicated to the biodegradation of chemicals in the environment. enviPath not only stores information on how microbes degrade chemical pollutants, but can also predict such biodegradation pathways using computational models.
In the enviPathPlus project, we are making enviPath more user-friendly and improving its connection to other resources for biochemical and genomic data. These enhancements will make it easier for researchers to share biodegradation data, provide stakeholders with important information to make decisions about the safety of chemicals, and help educate the next generation of scientists. With these enhancements, the knowledge and computational models in enviPath will hopefully contribute to the future development of chemicals that are safe and sustainable by design.
Project Results
To launch the enviPathPlus project, we organized a workshop on enviPath at the 2023 ICCE conference in Venice to promote enviPath as a resource to the environmental chemistry community, followed by a scoping workshop to gather the needs and ideas of key users and contributors. Through regular enviPath newsletters and social media updates, we encourage the scientific community to stay involved.
On a technical level, we have linked all compounds and reactions in enviPath to external key databases, and we now provide biodegradation pathways for download in an established standard format for data exchange in systems biology. We have also linked enviPath reactions to protein and gene sequences, which will facilitate the study and engineering of microbial communities capable of removing micropollutants.
To facilitate the interaction of analytical chemists with enviPath, we have developed an Excel spreadsheet containing all data elements to be reported for biodegradation studies in soil, activated sludge, and water-sediment systems, and we are promoting the use of this spreadsheet for data reporting in other projects (e.g., collection of PFAS degradation data). We have further improved the prediction of potential transformation products (TPs) by implementing a greedy search algorithm as the new default pathway search algorithm, and redesigned the user interface to facilitate the generation of predicted TPs for suspect screening in environmental samples.
Finally, we have redesigned the wiki of the enviPath website and documented the enviPath-python Application Programming Interface (API), which allows the seamless integration of enviPath into data analysis and modeling workflows.
AstroORDAS: Online Open Research Data Analysis Services for Astrophysics and Multi-Messenger Astronomy

Project Description
The project Astro-ORDAS stands for Open Research Data Analysis Services (ORDAS) for the Astronomical, Astro-Particle, and Multi-Mesenger communities (mainly). In all science domains, there is a general request to accompany research with data sets that are Findable-Accessible-Interoperable-Reusable (FAIR). In astronomy, there is a long tradition of publicly available data from space and ground-based observatories, but this projects aims to go beyond that by providing the possibility of formatting data transformation tools, such as workflow or algorithms, in a format that can be easily translated into a web service. This project has taken the approach of starting from data sets and analysis tools in which University of Geneva, Ecole Polytechnique Federale de Lausanne (EPFL) and Fachhochshule Nord-West Schweiz (FHNW) have an expertise to provide valuable services and developing the needed tools. This projects is in the path of the INTEGRAL Science Data Centre (ISDC) and the Common Data Centre Infrastructure (CDCI), long-lasting projects through which the University of Geneva has provided access to space data from various missions during the past two decades, such as INTEGRAL, Gaia, Euclid. EPFL and FHNW coordinate the Swiss Off-site Data Center for the Cherenkov Telescope Array Observatory (CTAO), a next-generation gamma-ray telescope, and the Swiss Regional Center for the Square Kilometer Array Observatory (SKAO), a next-generation radio telescope. This knowledge has been fundamental in choosing and shaping the services to provide.
Project Results
To achieve our goals, it has been necessary to develop ad-hoc tools based on existing technology and leveraging on existing services as the Renku platform of the Swiss Science Data Center. Our project has also benefited from the unplanned collaboration with the Galaxy Platform, a tool widely used in bioinformatics to build web-accessible reproducible workflows. We have developed our own “ontology” a dictionary of terms used to map input and output parameters into wider classes from which characteristics for the web representation can be inferred and exploited. We have published a guide (https://odahub.io/docs/guide-development/) to explain how to encode a workflow into a jupyter notebook with proper annotations so that this can be understood as a web service to be deployed both on the Multi-Messenger Online Data Analysis (MMODA, https://www.astro.unige.ch/mmoda/) platform and on one instance of the Galaxy platform.
Our experts have developed several workflows that have been published and several other that are still under development. The services to provide high-level products for the INTEGRAL mission are part of a wider initiative and use the computing power of the University of Geneva, hosting the ISDC and come from the legacy CDCI project. These have been maintained and enhanced as part of the Astro-ORDAS project, for instance by combining the pre-computed products available in the MMODA gallery (https://www.astro.unige.ch/mmoda/gallery). Leveraging on the available expertise, we provided services for MWA radio telescope, a theoretical tool to compute the Spectral Energy Distribution of some celestial objects, to visualize results from gravitation-wave observatories and model GW signals, to simulate the CTAO LST telescope performance, to access public MAGIC data etc. The MMODA platform is now supported by the ACME European infra-Serv project and is being integrated in the European Science Cloud.
ODTPR: SMS An Open Digital Twin Platform for Research on the Swiss Mobility System

Project Descirpiton
The project aims to develop a platform of integrative character to be deployed and used for all transporation research community to facilitate and promote the exchange of mobility data and analytical tools. The platform aims to support research, collaboration, and outreach activities with emphasis on open-source, accessibility and discoverability of data sets and tools and repeatability of results.
The Platform was built within the framework of the collaborative project with the Swiss Data Science Center (SDSC) funded by the ORD program of swissuniversities.
Project Results
The platform consists of modular open software that allows users to connect basic functional (core) modules and specific additional modules created to access, process, and analyze mobility-related datasets. Each user can create their modules by adopting some basic guidelines. These modules may allow users to analyze data, simulate scenarios, or transform data to extract information and gain insights. These modules can then be connected within the platform and combined with other modules.
The new modules can also be shared with the community, for example, to allow the reproduction of published results or comparison of different tools or datasets. Therefore, this platform promotes FAIR principles among the Mobility Research community.
The first version of this platform was released in March 2024 and is publicly accessible at https://github.com/odtp-org/odtp. The documentation, tutorials, and manuals can be found at https://odtp-org.github.io/odtp-manuals/. A graphical user interface simplifies the interaction with the platform, and we are working on making this Interface as straightforward to use as possible
Additionally, to use the platform locally on your machine, it has been deployed on a server in ETH Zurich and can be accessed remotely.
OBELIS: Open Elite Data Project
Project Description
L'Observatoire suisse des élites (OBELIS) entretient une base de données en unique au monde, qui rassemble des informations détaillées sur plus de 40 000 membres des élites politiques, économiques, culturelles et universitaires suisses entre 1890 et 2020. Elle comprend des données sur les origines sociales, la formation, la carrière, les grades militaires, les fonctions au sein de comités et d'associations, les distinctions et les relations familiales des élites suisses. Elle est reliée à d'autres plateformes de données nationales et internationales (Dodis, Dictionnaire historique de la Suisse, metagrid.ch) et sert de base à un grand nombre de projets de recherche internationaux et diversifiés. L'objectif du «Open Elite Data Project» était de 1) rendre la base des données OBELIS compatible avec les principes FAIR et ORD; de 2) renforcer la communauté scientifique, journalistique et citoyenne qui étudie les élites et de 3) déployer son architecture de données sur un projet international - la World Elite Database (WED). Dans le cadre du projet nous avons établit les normes relatives à la gestion et à l'utilisation des données ODR dans les grandes bases de données prosopographiques en sciences sociales. Cela permet à une vaste communauté internationale de chercheurs de comprendre les défis politiques, économiques et environnementaux en étudiant les élites, leurs décisions et leur influence, et deviendra une ressource essentielle pour de nombreuses initiatives journalistiques et organisations non gouvernementales.
Project Results
Grâce au «Open Elite Data Project» nous avons fait d'importants progrès dans la mise en conformité de la base de données OBELIS aux principes FAIR. Sur le site de consultation nous avons mis en place des identifiants uniques des pages internet et un versioning. Les données ouvertes (ORD) sont désormais accessibles à la communauté scientifique sur le répertoire SWISSUbase. Ces deux vitrines de données ont fait l’objet d’une campagne de communication digitale et nous mettons désormais à disposition des outils de visualisation des données pour les journalistes et citoyen.ne.s. Nous avons également contribué à renforcer la communauté scientifique étudiant les élites. En 2024, nous avons organisé une summerschool à Lausanne avec la participation de 27 doctorant-es internationales. Dans le cadre de la World Elite Database, deux workshops internationaux ont eu lieu à Londres en 2023 et à Paris en 2024 et de nombreuses réunions zoom ont suivies. En mars 2025 un «article fondateur» de WED (avec 65 auteur-es) a été publié au British Journal of Sociology et a connu un écho médiatique mondial. Finalement, nous avons mis en place un système de data management Open Source (Heurist) suivant les principes FAIR. Parallèlement nous avons mis en route un processus d’institutionnalisation de la communauté qui permettra d’intégrer de nouveau pays-membres à l’avenir. Nous avons aussi amorcé, aidé par le service juridique de l’UNIL, un contrat de consortium et formulé une stratégie d’utilisation des données conforme aux différents régimes de protection de données.
AFFORD: A framework for Avoiding the Open Research Data Dump
Project Description
Unless tools and infrastructure for proper data curation and structuring are provided, the requirement for open research data is bound to produce data dumps where data are freely accessible, but of limited utility. Led by the Interface Group at the University of Zurich, AFFORD aims to establish a sustainable support framework that lowers the barriers to publishing data and other forms of research output in an accessible form by bundling know-how, workflows, and tools under the umbrella of one organizational entity of the respective Swiss university. To field-test the framework and quantify the required resources, we accompany a complex reference project through the full cycle of experiment planning, research output creation, analysis, curation and publishing. This project-based approach will improve the sustainability of the support framework by providing reliable resource requirements to decision makers and accelerate its acceptance by ensuring it has reached sufficient maturity before it is made available.
Project Results
AFFORD was approved on April 6th, 2023, with contractual agreement entering in action as of May 1st. Carry over funds from the first period, imparted by the delayed project start, were invested to recruit two additional post-doctoral researchers in the second period, allowing for the successful completion of the project goals and milestones. In the first period, we focused on work packages (WP) 2 and 3, with the establishment of provisional guidelines (deliverable 2.2.3) and infrastructure (deliverable 2.3.2) required to support the production of re-usable open research data (ORD), and several iteration cycles with the reference project (deliverables 3.2.2 and 3.2.3).
In this second period, focus was set on ensuring transferability of the developed guidelines and infrastructure to other research projects (WP 2 and 3) and defining a sustainable ORD support model (WP4). We successfully implemented a central ORD Index (deliverable 2.3.4), including the ORD of the reference project (deliverable 3.2.9). The ORD guidelines and recommendations were published in Scientific Data (deliverable 4.4.4), and the workflow for creating a central ORD Index was published as preprint in MetaArXiv. In parallel, we reviewed the Swiss ORD support landscape. Based on this analysis, we defined four different support scaffolds (deliverable 4.1.3) and engaged stakeholders across the University of Zurich and the larger Swiss ORD community to identify which services would best serve as sustainable enablers. Recommendations for a sustainable ORD support framework were summarized in white paper submitted to Data & Policy and a two-page executive summary for stakeholders.
ModelArchive
Project Description
Proteins and their interactions with other molecules are vital for biological processes, and their function relies on their 3D structures. While structures were traditionally determined via experimental methods, computational methods have made impressive progress. The structural biology community has pioneered open research data (ORD) principles, as exemplified by the Protein Data Bank (PDB), but the PDB does not store computationally modelled structures, leading to scattered models lacking metadata and uniformity. Addressing this gap, our group developed ModelArchive (https://modelarchive.org), accompanied by the ModelCIF format for metadata storage. However, standards for complex computational models involving molecular interactions, different conformational states, and designed proteins are not yet established. The aim of this project is to advance ORD practices by defining and promoting best practices for data and metadata standards, improving usefulness of structure models with validation metrics, and connecting to other resources to make models easily findable, accessible and reusable.
Project Results
A key achievement was the continued development and adoption of ModelArchive (https://modelarchive.org) and the ModelCIF format. During the project, over 550,000 models were deposited, including 16 large datasets. ModelArchive has become a recognised deposition resource, with an associated publication (DOI: 10.1016/j.jmb.2025.168996) and models linked to publications in 239 journals. Outreach efforts included tutorials and posters at major conferences (ISMB/ECCB, 3D-BioInfo, SIB Days, European RosettaCon) to raise awareness and adoption. Data standards and validation criteria were defined for complex modelling scenarios, including molecular interactions, conformational states and designed proteins. These efforts will culminate in a forthcoming publication in the annual "Computation Resources for Molecular Biology" special issue of the Journal of Molecular Biology, accompanied by a final update to the ModelCIF dictionary and ModelArchive documentation. The functionality of ModelArchive was enhanced with new features, and models were distributed to ViralZone and Foldseek to improve the findability of the models. We also developed a prototype data harvesting system which is currently undergoing internal testing to streamline metadata integration. The project faced two main challenges: a delayed start due to recruitment difficulties and the need to postpone manuscript submission in order to align with the special issue timeline (the submission window is in September 2025). These were addressed through a no-cost extension, without altering the project’s goals or budget. Overall, the project met its objectives by advancing ORD practices in computational structural biology and promoting standards for modelled protein structures.
LOD4HSS
Project Description
LOD4HSS is based at the University of Bern within the Digital Humanities/Walter Benjamin Kolleg and implements the Geovistory environment as the platform to produce and consume Linked Open Data (LOD). The modular system allows for:
- data reuse (import of existing data sets),
- the FAIRification (producing truly interoperable data according to Linked Open Data standards with a domain-specific ontology),
- documentation and presentation
- prepare analysis and visualization
Geovistory is being used in research and teaching in the Humanities and Social Sciences, relying on a CIDOC-CRM-based ontology (SDHSS) that is openly published and constantly adapted to the needs of the users.
LOD4HSS worked on three use cases, «Existing Data», «RDF», and «Teaching», as well as on the sustainability of the environment, showcasing that the Geovistory platform can efficiently and handy be used for a variety of data needs in the SSH domain. The involved institutions supported a broadened and strengthened Geovistory environment, making for a very positive outlook.
Project Results
The LOD4HSS project has concluded after a fruitful 2024 year with three primary goals:
1. The first goal of the LOD4HSS project was to better identify the needs of researchers in three use cases (natively producing LOD, importing data, and teaching) and improve the associated workflows. The wide range of needs was successfully identified by working with different projects for each use case (see section A.1.a). It led to many adjustments not only to the workflows (creation of ontological profiles, alignment with SARI models, etc.) but also to the tools and infrastructure of Geovistory (POC for new and more straightforward import tools, creation of distributed graphs, etc.).
2. The second goal was to build and strengthen the community around Geovistory. This was achieved with the creation of many communication platforms (a Discord channel, a newsletter, and GitHub discussions) as well as participation in many DH and Humanities events (DH conferences, workshops, etc.). This can be measured by the number of new projects joining Geovistory, as well as the inclusion in up-and-coming infrastructures, such as DARIAH-CH ENABLE, and by being mentioned in the report of the ORD TF SSH. Geovistory is also closely aligned with SSHOC-CH and was asked to be documented for the infrastructure Road Map process by the University of Bern.
3. The third goal was to build a sound administrative and organizational structure for the whole environment that proves sustainable in the middle and long term. While the Swiss landscape of Digital Humanities remains unstable, with multiple stakeholder groups recently formed (SSHOC-CH, DARIAH-CH) and a common ORD strategy still in definition, the sustainability of the Geovistory environment has been secured by making the whole environment public by strengthening collaboration with national and international institutions and by instituting paid services for research projects.
CRISPR4ALL
Project Description
Phenotypic CRISPR screens are instrumental in the research of many fundamental biological phenomena, and arrayed CRISPR libraries extend the screening territory to cell-nonautonomous, biochemical and morphological phenotypes. Our lab (Aguzzi lab – UZH) has generated two human genome-wide arrayed plasmid libraries termed “T.spiezzo” (gene ablation, 19,936 plasmids) and “T.gonfio” (gene activation and epigenetic silencing, 22,442 plasmids). These tools allow for the individual manipulation of every human gene, are broadly applicable to all human biology, and are attracting strong interest from biological and medical researchers worldwide. With this project, we enable the access of the global research community to these toolsets and to the research data generated therefrom by 1) generating lentiviruses from our library plasmids and providing them to the research community; 2) providing practical training, protocols and standards to interested users, and 3) creating a community of users adopting robust FAIR-compliant computational tools for collaborative research and data sharing.
Project Results
Project Deliverables & Milestones – Completed
- Established SOPs for the project management, coordination, and involvement of the internal and external stakeholders
- Recruited a Scientific Advisory Board (SAB)
- Published a website for the project (more information below)
- Conducted a call for project proposals for the dissemination of our libraries, from which we selected four partners (Ardem Patapoutian, Roger Geiger, Konstantinos Lefkimmiatis, Lefteris Michailidis)
- Generated lentiviruses from the T.gonfio and T.spiezzo libraries (lentiviral packaging)
- Sequenced all 42’000 plasmids
- Trained visiting researchers and students in ALPA cloning method and in high-throughput genomic screening
- Fulfilled additional requests for reagents
- Dissemination of CRISPR4ALL: Prof. Aguzzi, Dr. Yin, and other researchers in our lab have conducted and continue to conduct dissemination activities through visits to other labs (list available on demand due to space constraints in this report).
- CRISPR4ALL Retreat in St. Gallenkirch, Austria (September 2024)
Project Deliverables & Milestones – Ongoing
- CRISPR4ALL Website update – Interactive features, additional protocols and resources will be added in Q1 2025
- Publishing of detailed protocol for large-scale arrayed library generation and screens – two technical papers are being prepared, one nanopore sequencing to bioinformatically solve lentiviral template switching issues and one on detailed protocols for library generation and screens) and they will be submitted in Q1 2025.
Project Deliverables & Milestones – Not applicable
- Depositing 100 highly-characterised plasmids to Addgene – the materials were offered to Addgene but were not accepted because of their polyclonal nature. We have deposited 6 plasmids to Addgene, and we have provided all the needed material for interested parties to clone 4-sg plasmids.
OpenEM: Open EM Data Network
Project Description
The OpenEM project enables open and FAIR data management for the Swiss electron microscopy (EM) community. Electron microscopes generate substantial amounts of image data with applications in structural biology, cell biology, and materials science. OpenEM provides access to this data in a standardized, open and interoperable repository. This benefits research through more streamlined data collection and publication workflows, tighter integration with established repositories, reproducibility, verifiability, and reuse of datasets for novel scientific results.
The project received funding from both swissuniversities (lead Prof Loewith, UNIGE) and ETH-ORD (Prof Stahlberg, EPFL) to provide services across Switzerland at UNIGE, UNIBAS, UNIBE, ETHZ, EPFL, PSI, and EMPA.
The SciCat data catalog, established at PSI, was expanded into the central repository for all open EM datasets. Work package 2 focused on collecting EM data and metadata efficiently from all participating facilities and depositing it in SciCat according to international standards. These data are then made available to collaborators and the public. WP3 further improves access through easy deposition of data into international repositories (EMPIAR, EMDB, PDB).
Project Results
Over the full project duration, the majority of OpenEM’s objectives were successfully achieved. Core technical infrastructure has been implemented, and the foundation for long-term FAIR data management in electron microscopy across Switzerland is established.
Key accomplishments include the publication of the OSC-EM metadata standard, supporting multiple techniques (single-particle analysis, tomography, and materials science), and the deployment of cross-institutional authentication in SciCat. This enables researchers from all participating institutions to access the SciCat data catalog, with microscope managers able to manage user access rights.
Metadata extractor tools were developed for major EM instruments, and a user-friendly web ingestor was built to support dataset selection, metadata preview, and data transfer monitoring. The ingestor has been deployed in test environments at all facilities. Integration with EMDB and PDB was completed for biological datasets. The project also delivered a public website (openem.ch) and hosted two community workshops to promote outreach and engagement.
Some user-facing features, including full rollout and training for routine users, are not yet complete. These will be addressed in the final project phase, enabled by the remaining 6-months of funding from ETH-ORD. Publications on OSC-EM and OpenEM are also planned during this period.
Challenges included the technical heterogeneity across facilities, which required more effort than expected for harmonization. Nevertheless, no major changes to project goals were needed.
Funding was originally allocated for UNIL’s participation. This was unneeded, as the DCI Lausanne facility also participates through EPFL. Overall, the budget was underspent around 31 kCHF, and the excess will be returned.
ORDEA: Open Research Data Environments for the Arts
Project Description
ORDEA provides a robust framework for Open Research Data in Art History and the Humanities and Social Sciences at large, taking into account and leveraging the potential of a rapidly growing number of digital resources from archives, collections, and museums (data and visual artefacts) on one side, and the research potential of knowledge graph analytics and computer vision methods for cultural heritage resources on the other. This urgent scholarly demand is being addressed by i) providing a shared ontological framework for research and collection data, ii) developing tooling and practices for referencing and interlinking research and collection data, and iii) developing tooling and practices for semantic data analysis in cultural heritage and interlinking semantic data with computer-vision and machine-learning data. The mission is to leverage the fast-growing number of publicly available cultural heritage data, both manually curated and AI or machine learning generated, for future research in the ORD context.
Project Results
Over the course of the ORDEA project – particularly its second half – all key goals and milestones were achieved or exceeded, with all deliverables published as planned. The design of the Ontological Foundation, the Reference Data Framework, the Zellij Modelling Framework, and the implementation of reference data pipelines (WP A+B) for modelling and publishing semantic data in cultural heritage constitute key goals and the bulk of the deliverables. Components were developed and documented during the first half of the project and revised and published in their final form during the second half. Thus, all aspects have been extensively tested on real-world community use cases by several partners (from HEI and GLAM institutions) to verify the interoperability and reusability and to ensure community acceptance. Where testing revealed issues or additional requirements, these have been integrated into the deliverables.
Data Integration and Visualisation (WP C+D) has been the focus of the last year, including the development of data pipelines (alignment and enrichment, validation, documentation), IIIF conversion pipelines (LOD-based manifests), and the integration of machine-learning data and cultural-heritage data within the ORD context (formalisation of ontological mapping, practices for data visualizing and data analysis). These aspects have also been developed on real-world use cases, providing valuable insights into complex requirements.
A major challenge has been the recruitment of qualified personnel for WP C+D. Thanks to the successful hiring of two Research Data Engineers, a redesign of the WPs, and a (cost-neutral) project extension, the project was able to overcome the challenge.
RE2VITAL
Project Description
Despite being at the forefront of in vivo imaging, intravital microscopy data (IVM), metadata, and tracks typically remain stored in private servers with restricted access. This hampers data reusability, reproducibility, and further analyses to answer additional questions outside the original goal. Moreover, the application of data mining methods to the data generated by this type of microscopy is particularly affected, as large datasets are typically required. To overcome these limitations, we created IMMUNEMAP, an Open Data platform for IVM data dedicated to immunological processes. IMMUNEMAP has been created thanks to the effort of an international network of 21 world-class imaging laboratories, which uploaded their intravital 2-photon datasets to the database.
Here, we aim at advancing and fully anchoring Open Data practices with IMMUNEMAP by:
a) Consolidating the functionalities of IMMUNEMAP, including findability and interoperability.
b) Promoting data exchange between immunology and computer vision communities, thus expanding the network of partners.
c) Educating researchers to adopt open protocols that safeguard reproducibility.
These projects will foster the availability of IVM data under the FAIR principles.
Project Results
The project, started in 2022, was successfully concluded during 2024, contributing to the dissemination of ORD practices in Switzerland and abroad. These included the curation of intravital microscopy data, which were made available through the IMMUNEMAP platform. Such a databank to date sums more than 1M+ single cell annotations and 400 unique experiments.
Through the project, IMMUNEMAP was upgraded to better comply with the FAIR principles, ensuring a better findability and accessibility of data and development of interfaces for interoperability with other Open Science projects. Additionally, reusage was promoted through educational workshops and the organization of a challenge to attract both data and biomedical scientists. This allowed an exchange of knowledge between two distinct scientific communities, computational sciences and immunology. Main challenges encountered were related to the acquisition and curation of data from different laboratories, which is a very time-consuming process and the long-term maintenance of the infrastructure.
scFAIR
Project Description
The Leading House is the Evolutionary Bioinformatics group at the University of Lausanne, notably developing the database Bgee (https://www.bgee.org/). Bgee is an infrastructure allowing the retrieval and comparison of gene expression data in animal species, using multiple transcriptomics technologies, e.g., single-cell along with bulk RNA-Seq.
scFAIR is a collaboration with the Deplancke lab at EPFL, developing the infrastructure ASAP (https://asap.epfl.ch). ASAP allows users to perform single-cell RNA-Seq analyses online, and to provide highly reproducible workflows.
The aim of this project was to build a collaborative platform disseminating ORD practices for the single-cell genomics community. Single-cell data are poorly standardized in primary repositories, and have been curated in isolation in secondary repositories, with no coordination. We improved sharing of single-cell datasets, defining a common metadata schema agreed upon with other major infrastructures, and coordinated curation efforts. We demonstrated the capability of integrating multiple single-cell datasets, thanks to this standardization work.
Project Results
The main objectives of the project were achieved, aided by a six-month no-cost extension.
In the first year, the key goal was to engage major infrastructures managing single-cell data, define widely adopted community standards, and position Switzerland as a leader in single-cell data standardization. This was accomplished early with the involvement of CELLxGENE (a key source of curated human and mouse single-cell data), FlyBase (the reference database for fly biology, which annotated the Fly single Cell Atlas), and the ontology group at the Wellcome Trust Sanger Institute (working on the Cell Ontology). Later, we also onboarded the EMBL-EBI Single Cell Expression Atlas and integrated datasets from the Broad Institute Single Cell Portal. As a result, nearly all major single-cell data resources are now part of scFAIR, led by ASAP and Bgee.
Together, we developed a shared metadata schema for annotating single-cell data across animal species and launched a portal (https://www.sc-fair.org) to federate datasets from these infrastructures, enabling metadata-based parsing and queries. Multiple workshops at conferences helped gather user feedback. A key challenge identified was ensuring reproducible analysis workflows; we issued recommendations to address this.
Our data stewardship goals evolved: initially, we aimed to help data producers standardize their datasets via a deposition portal. However, this proved too ambitious for the project’s scope. Instead, we focused on coordinating curation efforts within the scFAIR consortium to standardize public datasets, contacting authors when necessary.
SIMBioData: Standardized integration of multi-omics biomedical data
Project Description
Omics data have become pervasive, including in clinics. While data analysis methods generally lag behind data production, the scale of data generation and its implication for human health result in an acute need for standardized, sustainable and evolvable method infrastructure to support robust and reproducible inferences. We argued that these are only possible when data analysis yields quantities with clear biophysical meaning, so that genome, transcriptome, proteome etc. measurements can be compared and integrated across different studies and experimental approaches. Towards this end we proposed to focus on a few commonly obtained data types aiming to (1) identify and provide standard-ized analysis methods that yield biophysically-meaningful quantities; (2) provide easy-to-use methods to infer regulatory information from high-throughput datasets; (3) time permitting, move beyond steady-state analysis, to the analysis of temporal datasets. The data types were chosen according to our fields of expertise – epigenetic, transcriptional and post-transcriptional regulation of gene expression.
Project Results
Our approach was multi-pronged: organizing workshops to discuss principles of omics data analysis with local and international experts; catalog and analyze the performance of tools currently used for data modalities of interest: epigenome, transcriptome and translatome.
Regarding the first aspect, we held two workshops: 15/9/2023 at EPFL on ChIP-seq and ATAC-seq analysis, and 24/6/2024 around the annual Swiss bioinformatics meeting, on single-cell RNA sequencing (scRNA-seq) analysis. In 2025, Erik van Nimwegen presented our project’s manifesto and proposed solutions at the Ascona workshop on Modern Benchmarking, and further expanded our international reach through exchanges with top scientists at the Berlin Institute for Medical Systems Biology.
scRNA-seq data are affected by biological and technical noise, whose correct treatment is paramount for downstream inferences. While we already proposed a principled method, new studies continue to contain methodological errors. We performed a rigorous analysis of a recent benchmark, finding that even on simulated datasets, consistency and accuracy were anticorrelated. We are therefore working on a tutorial paper to help scRNA-seq researchers evade the identified pitfalls. We conducted a similar analysis of tools for translatome analysis (ribo-seq data), also focusing on the key step – identification of the ribosome decoding site position in each read. We have collected independent measurements (mass spectrometry) to finalize this benchmark this summer. We expect to submit both manuscripts by the end of 2025. Thus, we have contributed towards standardization, proposing methods that yield bi-ophysically-meaningful, translatable summaries of omics measurements.
OBELIS: Open Elite Data Project
Description du projet
L’Observatoire des élites suisses (OBELIS) de l’Université de Lausanne étudie les acteurs/rices en position de pouvoir dans les sphères politique, économique, administrative et académique suisses. Il développe une base de données prosopographiques (40'000 entrées) qui comprend de nombreuses informations sur les membres des élites en Suisse de 1890 à nos jours.
Le projet avait pour objectifs :
- De rendre la base de données existante compatible avec les principes FAIR et ORD
- De renforcer la communauté scientifique, journalistique et citoyenne qui étudie les élites par une gestion active de la communauté et des offres de formation
- De déployer son architecture de données sur un projet international - la World Elite Database (WED)
Nous avons «FAIRisé» notre base (consultation, archivage sur SwissUbase), nous avons renforcé la communauté scientifique (conférences, école d’été, consortium WED) et nous avons développé une infrastructure de données WED (Heurist, site Web WED).
Résultats du projet
Les objectifs généraux du projet Open Elite Data ont été largement atteints.
1) D'importants progrès ont été faits dans la mise en conformité de la base de données OBELIS aux principes FAIR. Notamment nous avons complètement refait notre site de consultation (avec versioning) et nous avons archivé les données OBELIS sur SwissUbase. 2) Nous avons contribué à renforcer la communauté scientifique étudiant les élites, notamment avec une summerschool, l’organisation de deux conférences WED et la publication d’un « article fondateur » de WED. 3) Nous avons mis en place un système de data management Open Source (Heurist) suivant les principes FAIR. Ce système est accompagné d’un processus d’institutionnalisation de la communauté. Nous avons aussi amorcé un contrat de consortium et formulé une stratégie d’utilisation des données conforme aux différents régimes de protection de données.
Deux défis principaux ont été à relever: premièrement, nous avons dû faire un ajustement vis-à-vis des objectifs initiaux concerne la migration de notre base de données OBELIS sur un logiciel DMS Open Source. Pour le moment notre base OBELIS reste sur Filemaker. Deuxièmement, les données WED sont actuellement disponibles à la communauté WED (65+ chercheur-es), mais pas encore à la communauté scientifique générale.
Dans l’ensemble nous avons très peu modifié nos objectifs, nous espérons les atteindre avec les prochaines étapes de notre projet à long-terme. Notre budget n’a pas subi de changement majeur, nous avons demandé (et obtenu) le droit de consacrer une partie du budget au site web de WED.
UpLORD
Project Description
UpLORD is a project hosted by the University of Zurich, with the support of the Zurich University Library and the CLARIN-CH Consortium. Since 2018, a consortium of partners has been building a national ecosystem of infrastructures for linguistic data, covering the entire data lifecycle in line with ORD requirements and FAIR principles (Findable, Accessible, Interoperable, Reusable). This includes the national technology platform LiRI, the repository LaRS@SWISSUbase, a database of Swiss media texts, and a platform for hosting and searching in large textual and audiovisual corpora. The goal of UpLORD is to upgrade these services to facilitate access to and reuse of linguistic research data in Switzerland and beyond. It contributes to increasing the FAIR-ness of Swiss language resources, enables the harvesting of LaRS by the CLARIN harvester, and works towards the certification of LiRI and LaRS@SWISSUbase as CLARIN B-centers.
Project Results
During the past year and throughout the project duration, the UpLORD project has successfully achieved its objectives.
1. Significant technical implementations have been completed, including the development and launch of the LiRI Corpus Platform, creation of data converters, implementation of complex annotation representations, and development of the DQD language query system. The LCP has been populated with a series of public corpora (French, German, English, Swiss German), but also with private corpora (which cannot be made public due to data protection and/or copyright issues). This work will continue beyond the borders of the UpLORD project (e.g. Rumantsch datasets, other French, German and Swiss German corpora). The project has enhanced SWISSUbase's metadata schema for specific language data types and successfully implemented the CLARIN federated authentication system and harvesting capabilities. The work on the API connecting LiRI and SWISSUbase resulted in the building of a minimal viable product allowing a series of highly frequent data formats. The current approach uses LCP as an intermediary, allowing users to convert corpora before archiving them on SWISSUbase. While a working CoNLL-U/CoNLL-U Plus converter has been created, users currently must use CoNLL-U or convert their corpora directly to LCP format.
2. Community engagement has been robust, with personal support provided to Swiss corpus owners to increase FAIR-compliance of their corpora. National working groups have been established to address sensitive data management, copyright issues, and intellectual property concerns. The project has formulated important workflows for metadata curation and version control, while also creating a concept for registering corpus platforms in SWISSUbase.
3. Training and documentation efforts have included organizing webinars and online training sessions, publishing open educational resources in the CLARIN-CH Zenodo community, and creating comprehensive documentation platforms and guides about language data management.
Track C
Track C ermöglichte es Forschenden, zu bestehenden und auf ORD-Prinzipien basierenden Open Communities beizutragen, deren Integration in bestehende Infrastrukturen (auch auf internationaler Ebene) zu prüfen und sich dabei auf die Verbesserung der wissenschaftlichen Tragweite und der technischen Qualität zu fokussieren.
EyeStore – A FAIR Data Platform for Eye-Tracking-While-Reading Research

Project Description
EyeStore is a dedicated data sharing and preservation platform for eye-tracking-while-reading research. Funded by swissuniversities through the EyeStore and EyeStore+ projects, it was developed to address the lack of standardized, FAIR-compliant infrastructure for this specific research domain. The platform enables researchers to publish, access, and reuse eye-tracking-while-reading data in a transparent and sustainable way.
Developed in close collaboration with COST Action 21131(“MultiplEYE)” - a European research network focused on eye-tracking in reading - EyeStore supports the sharing of datasets that follow a standardized experiment design and data processing pipeline. The platform includes a graphical user interface (GUI) that allows for metadata-driven search, filtering, and selection of data at various levels (e.g., study, session, trial), facilitating targeted access to relevant datasets.
EyeStore is openly accessible and designed to support community-driven contributions, serving as a reference platform for the implementation of Open Research Data (ORD) standards in eye-tracking and reading research.
Project Results
The primary outcome of the EyeStore and EyeStore+ projects is the development and launch of the EyeStore platform (https://rdc-psychology.org/en/eyestore) — a FAIR-compliant repository for eye-tracking-while-reading data. As an initial contribution, the platform hosts the MultiplEYE data collection, a multilingual dataset collected in an international mulit-lab initiative using a standardized reading experiment across testing sites.
Each dataset in EyeStore includes raw and processed eye-tracking data from the original recordings, to gaze event data (scanpaths) and word-level reading measures, detailed metadata, data quality reports, linguistic stimulus annotations, and documentation describing the lab setup and data collection process. All data go through a standardized open source preprocessing pipeline to ensure consistency and transparency.
The platform’s search and filtering functions allow users to preview and download datasets based on specific metadata criteria. EyeStore is built to ensure the long-term accessibility, interoperability, and reusability of data, in line with FAIR principles.
By combining user-friendly infrastructure with a strong focus on standardization and openness, EyeStore lays the groundwork for establishing ORD best practices in eye-tracking-while-reading research and fosters a more collaborative and transparent research culture.
tag-Xplore – a tool and method for the assessment of tag usage within and across multiple digital editions

Project Description
The University of Zurich (UZH), as the Leading House, drives efforts to enhance standardization and connectivity among digital editions in Switzerland. Many editions use TEI-XML with up to 585 pre-defined tags for annotating thousands of documents, yet often remain isolated, limiting their interoperability and reuse. To address these challenges, tag-Xplore aims to analyze and assess TEI tag usage across editions systematically. This project will develop an interactive dashboard to explore tag patterns, inconsistencies, and usage trends, supporting researchers in improving workflows, standardization, and long-term archiving. The project also seeks to establish a new culture of Open Research Data (ORD) within the digital edition community by organizing workshops and creating best practices for integrating and reusing data. With tag-Xplore, UZH and its partners will unlock the potential of digital editions, fostering a connected, standardized, and sustainable research ecosystem.
Project Results
The tag-Xplore project has progressed as planned, meeting all expectations for 2024. The work packages WP1-WP3, explicitly scheduled for this period, have been successfully addressed. A key milestone was reached by the end of 2024 with the completion of the tag-Xplore demonstrator, a web-based tool, marking a significant step in dissemination efforts. Additionally, the project has made notable academic contributions, with the leading house and its collaborators co-authoring scientific publications, including one long paper and one workshop paper, with more submissions in progress.
Feedback from stakeholders, gathered primarily through WP2, has played a crucial role in the iterative design of tag-Xplore (WP1). This process led to a focused effort on six out of fourteen digital editions meeting two key criteria: being publicly available and encoded in the TEI-XML standard. These editions provided a solid foundation for WP3, which centered on abstraction, conceptualization, and methodology. The outcomes of WP3 have been published and are currently under review.
The project’s scientific publications and user studies underscore tag-Xplore’s value, particularly for digital librarians and metadata content creators, highlighting its utility and impact within the digital edition community
EyeStore+ – Opening EyeStore for exploration: Providing a secure, searchable, well-documented and easy-to-use platform for scientific

Project Description
EyeStore is a dedicated data sharing and preservation platform for eye-tracking-while-reading research. Funded by swissuniversities through the EyeStore and EyeStore+ projects, it was developed to address the lack of standardized, FAIR-compliant infrastructure for this specific research domain. The platform enables researchers to publish, access, and reuse eye-tracking-while-reading data in a transparent and sustainable way.
Developed in close collaboration with COST Action 21131(“MultiplEYE)” - a European research network focused on eye-tracking in reading - EyeStore supports the sharing of datasets that follow a standardized experiment design and data processing pipeline. The platform includes a graphical user interface (GUI) that allows for metadata-driven search, filtering, and selection of data at various levels (e.g., study, session, trial), facilitating targeted access to relevant datasets.
EyeStore is openly accessible and designed to support community-driven contributions, serving as a reference platform for the implementation of Open Research Data (ORD) standards in eye-tracking and reading research.
Project Results
The primary outcome of the EyeStore and EyeStore+ projects is the development and launch of the EyeStore platform (https://rdc-psychology.org/en/eyestore) — a FAIR-compliant repository for eye-tracking-while-reading data. As an initial contribution, the platform hosts the MultiplEYE data collection, a multilingual dataset collected in an international mulit-lab initiative using a standardized reading experiment across testing sites.
Each dataset in EyeStore includes raw and processed eye-tracking data from the original recordings, to gaze event data (scanpaths) and word-level reading measures, detailed metadata, data quality reports, linguistic stimulus annotations, and documentation describing the lab setup and data collection process. All data go through a standardized open source preprocessing pipeline to ensure consistency and transparency.
The platform’s search and filtering functions allow users to preview and download datasets based on specific metadata criteria. EyeStore is built to ensure the long-term accessibility, interoperability, and reusability of data, in line with FAIR principles.
By combining user-friendly infrastructure with a strong focus on standardization and openness, EyeStore lays the groundwork for establishing ORD best practices in eye-tracking-while-reading research and fosters a more collaborative and transparent research culture.
SleePyLand: A python library to analyse the large amount of NSRR sleep data via deep learning algorithms

Project Description
SLEEPYLAND is an open-source software solution designed to standardize, automate, and enhance the analysis of large-scale sleep data. Designed to simplify and standardize the evaluation of algorithms that automatically classify sleep stages from overnight recordings. In sleep medicine, specialists often review data from a polysomnography (PSG) – i.e., measuring brain waves, eye movements, and muscle activity throughout the night – to diagnose sleep disorders. Manually analysing these data is time-consuming, so researchers have developed automated methods to speed up the process. However, these tools can be difficult to compare because they rely on different data formats, evaluation techniques, and are not always widely accessible.
SLEEPYLAND addresses these challenges. It integrates multiple high-performing machine learnings approaches into a single containerized platform it exploits large-harmonized datasets from the National Sleep Research Resource (NSRR), the world’s largest open repository of PSG recordings, also ensuring compatibility with existing NSRR tools.
SLEEPYLAND promotes collaboration and reproducibility, ensuring easy adoption within the sleep research community. Researchers and clinicians can benefit from automated ensembled sleep scoring, which aggregates the strengths of multiple high-performing algorithms in a single place. It ensures a transparent way for scientists and clinicians to compare methods, combine insights from multiple approaches/algorithms, and possibly make better-informed decisions whilst studying sleep. By offering a containerized and user-friendly solution, SLEEPYLAND aims to promote collaboration, reproducibility, and innovation in the field of automated sleep analysis.
Project Results
SLEEPYLAND python-based toolkit is packaged in Docker containers, making it easy to install and run on diverse computing environments. The code and comprehensive documentation are freely available on GitHub and DockerHub.
A key strength of SLEEPYLAND is its easy integration with the NSRR large data repository. Supported formats include EDF and HDF5 files, which are automatically converted into a consistent representation. The toolkit applies processing steps, i.e., harmonizing the data, removing the need for extensive manual preprocessing. It incorporates several state-of-the-art deep learning models (e.g., U-Sleep, DeepResNet, SleepTransformer, and L-SeqSleepNet) trained under a unified protocol. This approach requires consistent data splits and data sampling across all models. The framework supports single- or multi-channel setups, mainly exploiting all the possible combinations of electroencephalography (EEG) and electrooculography (EOG) derivations/signals. Basic ensemble-based strategies (e.g., majority voting, weighted averaging) further boost performance, combining the strengths of individual models.
The outcome is an automated, structured report detailing sleep-stage classifications (hypnograms), recently introduced hypnodensity graphs, and key clinical metrics such as total sleep time (TST), wake after sleep onset (WASO), sleep efficiency (SE) among the others. SLEEPYLAND also expose a browser-based GUI, running locally, to simplify the user experience. It allows non-technical researchers to use their own PSG data, triggering automated analyses and visualizing results interactively. A dedicated Jupyter notebook container offers advanced users flexibility for custom analyses or data exploration.
SLEEPYLAND empowers researchers to identify/evaluate robust, generalizable models, potentially improving diagnostic workflows, facilitating the analysis of large-scale sleep studies, and enabling personalized medicine approaches in sleep medicine.
EASI-SPSP
Project Description
Understanding how bacteria develop resistance to antibiotics and where different types of resistant bacteria are found is crucial for both public health and scientific research. The EASI-SPSP project, involving the Institute for Infectious Diseases (IFIK) at the University of Bern, the University of Zurich, the University Hospitals of Geneva, Lausanne and Basel, and the Swiss Institute of Bioinformatics (SIB) aimed to improve how bacterial genome data, protein data, and antibiotic resistance information are shared across different institutions in Switzerland.
A key part of the project was developing automated systems that allows microbiology laboratories to efficiently submit bacterial genome data and protein data (MALDI-TOF) to the Swiss Pathogen Surveillance Platform (SPSP). At the same time, a data-sharing system between ANRESIS, the Swiss Centre for Antibiotic Resistance, and SPSP was initiated. This connection ensures that genomic data and antibiotic resistance information from different sources can be combined and analysed together, providing a more comprehensive understanding of bacterial resistance. To enable this, data had to be standardized to be shared and interpreted consistently across platforms.
By improving how bacterial data is collected, processed and shared the project enhances Switzerland’s ability to monitor antibiotic resistance. These advancements not only support scientific research but also help public health authorities track and respond to new resistance patterns more effectively, ultimately leading to better patient care and stronger disease prevention strategies.
Pseudomonas aeruginosa bacteria are cultured on a nutrient medium to assess their sensitivity to different antibiotics, with clear zones indicating susceptibility.
Swiss-AL: Linguistic ORD Practices for Applied Sciences
Projektbeschreibung
Das Projekt «Swiss-AL: Linguistic ORD Practices for Applied Sciences» wurde am ZHAW Departement Angewandte Linguistik durchgeführt. Ziel des Projektes war es, die linguistische Korpusfamilie «Swiss-AL» zu einer FAIR-konformen Plattform für Sprachdaten in den Angewandten Wissenschaften weiterzuentwickeln. Swiss-AL erfasst eine breite Palette an Schweizer Quellen der öffentlichen Kommunikation (z.B. journalistische Quellen, Parlamentsdebatten, Medienmitteilungen von politischen Akteuren und Behörden) und ist damit für viele Fachdisziplinen, insbesondere in den Angewandten Wissenschaften, von hohem Interesse, da es eine transparente Datenbasis für die Analyse gesellschaftlich relevanter Diskurse darstellt. Im Projekt wurden die Bedürfnisse und Forschungspraktiken ausgewählter Disziplinen im Umgang mit Sprachdaten erfasst (durch Interviews, Fragebögen, Workshops), um auf dieser Basis einen bedarfsgerechten Zugang zu Swiss-AL in Form einer browserbasierten Benutzeroberfläche zu entwickeln, die FAIR-Prinzipien berücksichtigt sowie gegenwärtigen Bestimmungen des Daten- und Urheberrechtsschutzes genügt. Schliesslich wurde im Projekt das Ziel verfolgt, Swiss-AL in der Schweizer und europäischen Landschaft linguistischer Infrastrukturen fest zu verankern (insbesondere CLARIN-CH, aber auch SSHOC-CH).
Projektresultate
Die oben beschriebenen Projektziele wurden erreicht. Dazu gehört insbesondere: (1) das Erfassen von Bedürfnissen und Praktiken von Wissenschaftler:innen ausserhalb der Linguistik, die mit Sprachdaten arbeiten, (2) der Release der Swiss-AL-Workbench, die es Forschenden in und ausserhalb der Schweiz ermöglicht, Swiss-AL als Forschungsressource für eigene Fragestellungen zu nutzen und (3) die Verankerung von Swiss-AL in der Schweizer Landschaft linguistischer Infrastrukturen.
Die Swiss-AL-Workbench steht seit Mai 2025 in einer Beta-Version unter www.swiss-al.zhaw.ch zur Verfügung, ergänzt durch eine umfangreiche Dokumentation. Ebenfalls erreicht wurde das Ziel, eine juristische Einschätzung zu Datenschutz und Urheberrechtschutz zu erhalten. In diesem Bereich lagen gleichzeitig die grössten Herausforderungen des Projektes, da sich das gegenwärtige Datenschutz- und Urheberrechtsschutzgesetz der Schweiz nur bedingt mit den Zielen von Open Science decken und dadurch pragmatische Lösungen für die Publikation von Sprachdaten erforderlich sind. Bei der Implementierung der Swiss-AL-Workbench wurde auf die Empfehlungen der juristischen Einschätzung entsprechend Rücksicht genommen, indem der Zugang nur mit einer Switch-EDU-ID und einem begründeten Forschungsanliegen ermöglicht wird; ebenso besteht keine Möglichkeit, unmittelbar auf der Workbench auf Volltexte zuzugreifen. Stattdessen wurde die Verlinkung zu den externen Originalquellen implementiert.
Eine weitere Herausforderung bestand in der Erhöhung der Auffindbarkeit (findability) von Swiss-AL, da das Repositorium SWISSUbase/LaRS ebenfalls noch in der Entwicklung befindlich ist, insbesondere hinsichtlich der Darstellung und Metadatenstruktur von grösseren Korpusprojekten wie Swiss-AL. Als ein weiteres Ergebnis des Projektes ist deshalb die Erkenntnis zu nennen, dass Sprachdaten in Form von linguistischen Korpora nur bedingt mit dem FAIR Data Maturity Model kompatibel sind, da eine ganze Reihe der zu evaluierenden Kriterien auf Korpora nicht zutreffen. Stattdessen bedürfen linguistische Korpora spezifischen FAIRness-Kriterien, die bisher wenig explizit ausgearbeitet sind.
DERMAI
Projektbeschreibung
Das Leading House „DERMAi“ an der Universität Basel hat das Ziel, die digitale Dermatologie durch offene Forschungsdaten (Open Research Data, ORD) weiterzuentwickeln. Dazu werden bestehende und neu erhobene dermatologische Bilddatensätze harmonisiert und aufbereitet, um einerseits Interoperabilität sicherzustellen und andererseits Künstliche-Intelligenz-Modelle zu trainieren. Ein besonderer Fokus liegt auf repräsentativen Datensätzen für stark pigmentierte Hauttypen, um die gesundheitliche Chancengleichheit zu fördern. Hierfür werden etwa 80% der weltweit durch das PASSION-Projekt gesammelten Bilder offen zur Verfügung gestellt; die restlichen 20% dienen als Testdatensatz zur objektiven Qualitätsprüfung. Durch die Umwandlung aller Diagnosen in ICD-Codes und eine systematische Datenreinigung schafft DERMAi eine qualitativ hochwertige und einheitliche Datenbasis. Als weiteres Resultat wird ein vortrainiertes KI-Modell öffentlich bereitgestellt, das Forschende für ihre eigenen Studien adaptieren können. So stärkt das Projekt den offenen Austausch und fördert nachhaltige Innovation in der Dermatologie.
Projektresultate
Im vergangenen Jahr hat DERMAi erfolgreich die geplanten Teilziele erfüllt. Wir haben mehrere bestehende Bilddatensätze zusammengeführt, im Hinblick auf Diagnosekonsistenz vereinheitlicht und in ICD-Codes umgewandelt. Parallel wurden über das PASSION-Projekt Bilddaten mit besonderem Fokus auf hochpigmentierte Hauttypen erhoben. Die Integration dieser Daten in das Gesamtkonzept gelang planmässig und ohne grössere Verzögerungen. Eine zentrale Herausforderung war die Anonymisierung und Qualitätskontrolle der sensiblen medizinischen Bilddaten. Insbesondere bei Datensätzen aus verschiedenen Quellen war die einheitliche technische Aufbereitung komplex. Dennoch konnten durch enge Abstimmung mit Expertinnen und Experten sowie automatisierte Prüfverfahren (z. B. Erkennung von Dubletten) alle Datensätze harmonisiert werden. Budgets und Meilensteine wurden regelmässig evaluiert. Es ergab sich keine grundlegende Verschiebung der Projektziele; der Budgetrahmen blieb stabil. Lediglich die Ressourcen für Qualitätskontrollen wurden leicht erhöht, um die strengen Datenschutzanforderungen zuverlässig zu erfüllen und gleichzeitig eine hohe Datenqualität zu gewährleisten.
SUOHSA: SUPSI Open Heritage Samples Archive
Project Description
The objective of SUOHSA project was to establish a unified, open-access catalogue of the cultural heritage samples collected during various research projects at SUPSI (Scuola Universitaria Professionale della Svizzera Italiana). The Conservation-restoration sector at SUPSI, as many cultural heritage research institutions, held this type of collections in separate groups, not in a common archive and therefore difficult to be shared and to be accessed. In the long term this situation would have been a challenge for the sample’s preservation and for their further use.
The SUOHSA initiative focused on making a digital catalogue of the samples at SUPSI and a physical storage location archive. This enhances accessibility, preservation, and collaborative opportunities for SUPSI researchers and for the scientific community. The catalogue provides information on the samples which are a finite resource, as material from works of art and heritage in general and therefore emphasized their value and provides opportunity for the samples to be further used for research and education. The project has made the SUPSI Heritage samples collection available, by physically organizing the samples in dedicated spaces and by creating a digital open-access catalogue according to ORD best practices that will allow FAIR management of the archive. The digital catalogue will be linked to the "International Registry of Heritage Samples Archives" ICCROM-led initiative of which SUPSI is the only Swiss partner.
Project Results
The project was one year long, and it has successfully met its goals for the reporting period. One challenge encountered was the choice of information to be included for each sample in the digital catalogue. The type of data and categories to be made available were initially discussed among the team members so that the catalogue could be compiled for all selected samples. The digital catalogue for SUPSI cultural heritage samples includes the geographic information of the sampled buildings and/or monuments. The catalogue will be available in several formats: text (.csv), table (.xlsx, .ods), and GIS (.gpkg). The physical reorganization involved approximately 1300 samples and was carried out following the RE-ORG methodology (ICCROM) to allow a rapid identification and localization of the samples with the creation of a dedicated space for storage and archiving of the collection. In addition, an access, acquisition and storage protocol were developed for samples that will be collected in the future. To ensure the long-term sustainability of the results, SUPSI has appointed a person to be the archive manager who will be responsible for the control, maintenance and care of the archive, the updating of the database and the implementation of the protocol for the acquisition of new samples. This person will also ensure that the access protocol is respected by SUPSI staff and will interact with external researchers who request consultation. The digital catalogue will be regularly published on open access archive Zenodo alongside with contact information of archive’s responsible (this will be done by March 2025). The catalogue will also be included as a link in ICCROM’s “International Registry of Heritage Samples Archives” and to SUPSI website.
OMAHA: Open measurement hardware for scanning probe microscopy
Projektbeschreibung
Das Institut of Embedded Systems an der ZHAW in Winterthur hat eine neue Interface Hardware entwickelt, welche speziell für Scanning Probe Microscopy (SPM) Anwendungen wie beispielsweise AFM, SICM, oder AFSEM geeignet ist. Dieser neue Analog/Digital Converter (ADC) zeichnet sich vor allem durch seine hohe Geschwindigkeit und ultra-kurze Latenz aus. In Zusammenarbeit mit dem Laboratory for Bio- and Nano-Instrumentation (LBNI) an der EPFL konnte damit eine modulare Schnittstelle zwischen der analogen und digitalen Domäne entwickelt werden, mit welcher der bereits bestehende Open Source SPM-Controller der EPFL für Hochgeschwindigkeitsmessungen nachgerüstet werden kann. Der neue ADC wird als Open Source Projekt veröffentlicht, wodurch auch anderen Laboren eine performante und kostengünstige Hardware zur Verfügung gestellt wird. Diese kann teure und unflexible Laborgeräte komplett ersetzen. Durch diese Erweiterung ist der bestehende SPM-Controller der EPFL bestens geeignet für Experimente mit neuen Scannern, welche viel höhere Geschwindigkeitsanforderungen haben. Durch das modulare Design kann weitere Hardware nachgerüstet werden, was zusätzliche Kosten erspart.
Projektresultate
Das Projekt wurde erfolgreich in der geplanten Zeit beendet und die dabei entstandene Hardware entspricht den definierten Anforderungen.
Die aus einem Vorprojekt bestehende Hardware wurde gemäss den Anforderungen von modernen SPM-Scannern überarbeitet und das Interface zum SPM-Controller wurde neu definiert. Dabei wurde speziell auf eine schnelle Analog-Digital Wandlungszeit, hohe Bandbreite und Qualität des Signals geachtet. Dies wird das Entwickeln von schnelleren Regelungskreisen in zukünftigen SPM-Projekten im Labor ermöglichen. Zudem wird dadurch die Geschwindigkeit und die die Genauigkeit der Messungen positiv beeinflusst. Das Interface des bestehenden SPM-Controllers der EPFL konnte wiederverwendet werden, wodurch die neue Hardware modular zur bestehenden Hardware hinzugefügt werden kann.
Die neue Hardware wurde vorerst in einer kleinen Stückzahl produziert. Die entprechenden digitalen Filter als auch Softwareanpassungen im SPM-Controller der EPFL wurden vorgenommen und das Gesamtsystem wurde getestet. Diese Tests haben gezeigt, dass mindestens eine doppelt so schnelle Messung für SPM-Anwendungen zu erwarten ist.
Das aus diesem Projekt entstandene Hardware- und Softwaredesign wurde auf Github veröffentlicht, wodurch es für andere Labore verfügbar ist. Für die einfache Inbetriebnahme wurde eine Schritt für Schritt Anleitung erstellt. Siehe https://github.com/InES-HPMM/ADC_for_Scanning_Probe_Microscopy_OMAHA
STORIAEDU-CH
Projektbeschreibung
Das Projekt wurde vor dem Hintergrund eingereicht, dass das für die Schweizer bildungshistorische Community bedeutende Metaportal www.bildungsgeschichte.ch neu aufgestellt werden musste. Projektpartner war dabei selbstverständlich der das Portal betreibende Förderverein Bildungsgeschichte Schweiz, dem die SUPSI ebenso wie andere Schweizer Hochschulen, Schulmuseen und Archive als institutionelles Mitglied angehört.
Spezifisches Ziel des hier zu dokumentierenden Projektes war es, die notwendige Neuaufstellung des Portals zu benutzen, um das Portal mit neuen Suchfunktionen sowie neuen Schnittstellen zu neuen Fonds auszustatten. Daneben sollte ermöglicht werden, durch das Hinzufügen neuer Funktionen auch das manuelle Einspeisen kleinerer (z.B. von Schulmuseen digitalisierter) Dokumenten- und Quellenfonds zu ermöglichen.
Auch die Einspeisung neuer Dokumententypen sollte durch die Neuaufstellung möglich werden. Insbesondere sollten neue Dokumententypen (Fotos, Kinderzeichnungen usw.) ebenso wie Forschungsdaten wie statistische Langzeitreihen, Kurzbiographien u.ä. mit der Suchmaschine vernetzt werden, was eine Neuausrichtung der Funktionen auf der Suchoberfläche nötig machte.
Projektresultate
Das Projekt fand in einer komplexen Konstellation von Akteuren statt. Der Projektleiter wählte zu Projektbeginn zusammen mit dem Projektpartner einen Durchführungspartner für die Neuausrichtung des Portals, wobei die Wahl auf die IT-Abteilung der Universitätsbibliothek Basel fiel, welche zusammen mit zwei weiteren IT-Firmen (Outermedia GmbH in Berlin und arbim IT in Genf) das Projekt verwirklichte, dies nicht zuletzt deswegen, weil so mit Genehmigung des Vereins Swisscollections die Oberfläche des Dokumentenportals Swisscollections als Matrix für die Neuausrichtung verwendet werden konnte. Als wissenschaftliche Begleitungsgruppe wirkte im Hintergrund ausserdem die AG Historische Bildungsforschung der SGBF (Vorsitzender Prof. Dr. Sahlfeld) mit. Die Herausforderung bestand also darin, durch regelmässige Projekttreffen die Anforderungen der auftraggebenden wissenschaftlichen Community zu sichern, ohne zugleich die Machbarkeit des Projektes mit nicht realisierbaren Anforderungen zu belasten.
Dies alles konnte dank intensiver Zusammenarbeit aller Beteiligten im vorgesehenen Zeitraum durchgeführt werden. Einige der ursprünglich gesteckten Ziele konnten sogar übertroffen werden (z.B. bei der Integration serieller Quellen, von denen eine höhere Anzahl als vorgesehen vernetzt werden konnte).
Aktionslinie B3.2: ORD-Förderung für bestehende Forschungsinfrastrukturen von strategischer Relevanz
Ziel der Massnahme B3 war es, kosteneffiziente, langfristige Förderung für ORD-Dienste und -Infrastrukturen von übergeordneter nationaler Bedeutung bereitzustellen. Im Rahmen der Ausschreibung B3.2 wurden Projekte umgesetzt, die darauf abzielten, ORD entweder durch die Einführung eines neuen ORD-Elements oder durch die Weiterentwicklung einer ORD-Komponente in Forschungsinfrastrukturen zu fördern. Um Doppelspurigkeiten zu vermeiden, wurden Synergien mit anderen bestehenden Infrastrukturen angestrebt.
FAIR-FI-LD Moving towards a national FAIR-compliant ecosystem of Federated Infrastructure for Language Data

Project Description
FAIR-FI-LD (Federated Infrastructure for Language Data) is a one-year project (July 2024–June 2025) funded by swissuniversities and hosted by the University of Zurich. It brings together key partners including CLARIN-CH, the Linguistic Research Infrastructure (LiRI), the Zurich University of Applied Sciences (ZHAW), and the Università della Svizzera italiana (USI). The project aims to move Switzerland closer to a nationally coordinated, FAIR-compliant ecosystem for language data—one that is Federated, Interoperable, and Sustainable.
Over the past decade, Swiss higher education institutions have developed valuable services and platforms for working with language data. These include LiRI at the University of Zurich, the Swiss-AL platform for applied linguistics at ZHAW, and the LaRS@SWISSUbase repository for publishing and preserving language data. Despite these achievements, these services often operate in isolation, with limited interoperability, making collaboration and data reuse challenging. Moreover, specific research fields like interactional linguistics or second language acquisition still lack sufficient infrastructure.
Since the creation of the CLARIN-CH consortium in 2020—uniting nine universities and the Swiss Academy of Humanities and Social Sciences—efforts have shifted toward greater national coordination. FAIR-FI-LD builds on this momentum, aiming to establish a cohesive, FAIR-aligned infrastructure that supports researchers and professionals in Switzerland and connects seamlessly with European efforts through CLARIN ERIC. Ultimately, FAIR-FI-LD lays the groundwork for a sustainable language data infrastructure that benefits both academic and applied research communities.
Project Results
The FAIR-FI-LD project has made important progress in advancing a federated, FAIR-compliant infrastructure for language data in Switzerland. Through close collaboration among key national partners—including CLARIN-CH, LiRI, ZHAW, and USI—the project delivered both technical and organizational outcomes that strengthened the foundation for sustainable language data services.
Adaptation of CLARIN technologies to Swiss platforms
- Implementation of Federated Content Search (FCS)
- Creation of a multilingual FCS landing page
- API deployment by LiRI and Swiss-AL for platform interoperability
Community Engagement & Collaborationmai
- Regular alignment meetings across the project
- Collaborative planning for future development
- Final stakeholder workshop
Data Management & Metadata
- Working solution for metadata-only registration in SWISSUbase
- Increased discoverability of Swiss language resources
- Focus on interactional and multimodal language data
Capacity building & User support
- Creation of comprehensive documentation
- Distribution of training materials across institutions
- Enabling researchers to navigate tools and standards
ORDFORHETCAT
Project Description
ETHZ SwissCAT+ is an ETH Domain technology platform that performs services for the Swiss scientific community and beyond by providing state-of-the-art tools to perform data-driven high-throughput experimentation in the field of catalysis and thereby generating large amounts of data. The goal and content of the project ORDFORHETCAT is to leverage the interdisciplinary userbase at ETHZ SwissCAT+ to establish good practices for data management and to develop tools for the community. The outcome of the project aims at promoting the creation and use of open research data (ORD) complying with the FAIR principles. The main goals are to (i) develop streamlined FAIR data management strategies, (ii) deploy data visualization tools, and (iii) perform outreach to promote points (i), (ii), and ORD in the field of catalysis.
Project Results
A data management strategy to process catalysis data in a FAIR and ORD compatible way has been designed and implemented. The data management strategy includes codes that fetch data from an electronic laboratory notebook, handle general data sets and process them reproducibly. The codes can handle diverse raw data sets originating from a wide range of machines that are used in the field of catalysis. The data processing pipeline can be traced thanks to a configuration file to provide instructions to the code while also acting as metadata describing the data processing workflow. Data are easily reprocessed or renormalized and combined with multiple data sets from different electronic sources, therefore promoting data reusability and standardization. The project activities were published in a peer-reviewed scientific journal and the developed codes are publicly accessible on a git repository under a MIT License. ETHZ SwissCAT+ has developed various interactive visualization tools and established a collaboration with the Swiss Data Science Center to deploy them on their platform for data sharing. Large amounts of data can be easily shared and visualized and therefore promote the reuse of existing data. The overall project led to two publications in peer-reviewed scientific journals, ten conference/workshop contributions and public git repositories to promote and engage the broader scientific community with the tools developed within this project.
Advancing Surgical Data Science with Open Research Data Repositories in the OR-X
Project Description
The project is led by the University of Zurich (UZH), specifically by the Research in Orthopedic Computer Science (ROCS) group in collaboration with the Translational Center for Surgery, OR-X and Zurich University of Applied Sciences (ZHAW). It leverages the OR-X infrastructure to establish scalable and standardized processes for surgical data collection, curation, and processing. The general goal was to develop and integrate ORD components into the OR-X to enable the generation and dissemination of large-scale multimodal surgical datasets. The three core objectives were: (1) integration of surgical devices into the OR-X high-performance network, (2) automatic fusion and structuring of multimodal data to create surgical data models, and (3) efficient population of these models as public datasets. The primary outcome of the ORD project was the establishment of a novel Data Collection Framework, automating the collection, structuring, and standardization of surgical data.
Project Results
All core objectives of the project were successfully achieved within the planned timeframe. The ORD components, including Data Hubs (DHs), Middleware, and Cloud Platform, were developed, tested, and deployed in the OR-X. These elements enabled synchronized multimodal data acquisition, real-time fusion, and structured storage of surgical data.
An international workshop on surgical data science took place in March 2025, resulting in a preliminary roadmap for semantic structuring and dataset publication strategy in alignment with community standards. In April 2025, the first comprehensive dataset was acquired during a dedicated ex-vivo session focused on robotic ultrasound, integrating robotic, tracking, camera, and ultrasound data. By June 2025, ten fully functional DHs were manufactured, and the initial datasets were integrated into the Surgical Data Cloud Platform.
Despite smooth technical collaboration among institutions, several challenges arose. Administratively, the short lead time between project approval and start date affected recruitment and onboarding. Hardware procurement experienced delays, though all DHs were completed on time. Technically, integration of proprietary systems proved difficult due to the absence of standardized ROS2 interfaces, requiring custom SDKs and firmware. Moreover, as surgical data modeling remains a developing field, the platform was designed with modularity to support evolving ontologies and semantic layers.
There were no significant deviations from the project plan. One engineer left the project two months before the end of the project for personal reasons; an intern was recruited to support the remaining development and validation work. No adjustments to the budget structure were needed. The project concluded with all deliverables completed as planned.
FAIR-CPB: FAIRification of pathogen bioinformatics resources under the Centre for Pathogen Bioinformatics
Project Description
The Leading House for the project “FAIRification of pathogen bioinformatics resources under the Centre for Pathogen Bioinformatics” is ETH Zurich, in collaboration with the University of Basel, Swiss TPH, and SIB Swiss Institute of Bioinformatics.
All involved groups are steering the Swiss Center for Pathogen Bioinformatics and thereby share the common objective of enhancing the interoperability and FAIR (Findable, Accessible, Interoperable, Reusable) compliance of their resources to strengthen both national and global pathogen genomics surveillance and data sharing.
The project integrates key Swiss-developed tools (SPSP, Nextstrain, Nextclade, GenSpectrum, CoVariants, V-pipe, COJAC, LolliPop) and focuses on tool integration and data sharing around Loculus to foster an interoperable Swiss ecosystem of resources and catalyse genomic epidemiology globally.
Project Results
WP1: Progressed as planned. Regular consortium meetings were held. A public event in January in Bern received broad media coverage. In June, we organized a technical meeting in Basel, gathering over 20 Swiss bioinformaticians to discuss our tools.
WP2: To enable machine-discoverability of data on the SPSP public portal, we published and documented the API (https://spsp.ch/documentation/data-users/public-portal/api/) and deployed a SPARQL endpoint (https://spsp.sib.swiss/sparql), as planned.
WP3: We added support for sharing and querying raw read data and curations. Consensus sequences can now be shared with ENA. Based on user feedback after launch, we prioritized user experience, enhancing the interface for data submission, editing, searching, and downloading. The development of the command-line interface and API documentation have thereby been postponed.
WP4: As planned, we produced new Nextclade datasets (WNV, CCHF, H5 avian influenza—in collaboration with external partners—and HMPV) and updated existing ones (RSV, SARS-CoV-2, seasonal influenza viruses, mpox). Nextclade is now integrated with Loculus and serves as its preprocessing engine.
WP5: GenSpectrum was further integrated with other tools:
- Fully compatible with Loculus, retrieving data from any instance.
- Supports storing/loading phylogenetic data (e.g., Nextstrain trees).
- Prototype dashboard enables querying Swiss wastewater reads.
WP6: CoVariants improved website stability, adding interactive graphs, backend testing, stable data structures, switchable nomenclature, and comprehensive defining mutations page.
WP7: V-Pipe development progressed as planned. We expanded virus support, added tools for raw read preprocessing and variant deconvolution, and ensured outputs remain openly available under the GPL.
Bgee-access
Project Description
The Leading House is the Evolutionary Bioinformatics group at the University of Lausanne, notably developing the database Bgee (https://www.bgee.org/). Bgee is an infrastructure allowing the retrieval and comparison of gene expression data in animal species, using multiple transcriptomics technologies, e.g., single-cell along with bulk RNA-Seq. Bgee is recognized internationally and has a large user base.
The leading house led another Swissuniversities-funded project, “scFAIR”, to create a consortium of transcriptomics resources to agree on the metadata schemas and tools to make single-cell data FAIR. This project’s objectives were to enhance single-cell data integration in Bgee by implementing the conclusions of scFAIR, and to provide biologist users with powerful tools to identify, retrieve and reuse single-cell data. This would position the Swiss resource Bgee at the forefront of transcriptomics data FAIRification and knowledge graph construction, such as used in pharmacology, and Machine-Learning algorithm training for, e.g., discovering cell identity.
Project Results
During the project, we updated our data pipelines and access tools to align with scFAIR conclusions. We remained within budget, and updated how we matched funds, in line with reviewers’ comments.
Our first objective was to make Bgee’s data fully compliant with the scFAIR metadata schema, enabling integration with other single-cell resources such as CELLxGENE. This required revising our curation workflow to adopt new ontologies, remapping existing data, and updating our database structure.
The second objective focused on curating new single-cell datasets and making them available in a FAIR manner. We annotated dozens of experiments across 29 animal species, encompassing millions of cells and hundreds of distinct cell types.
We then aimed to update our access tools. The Bgee website now includes improved visualizations tailored for biologists, alongside new downloadable formats such as H5AD for integrated experiments. A new version of our Bioconductor package, BgeeDB, was released with a focus on single-cell data access. Our JSON API was expanded to provide additional information about single-cell data, and support integration with other scFAIR consortium members.
We faced challenges regarding integration of datasets from other resources and dissemination of structured RDF data. As single-cell datasets now routinely include millions of cells, our RDF triple-store grew to tens of billions of triples, exceeding current performance capabilities. To address this, we implemented new data representation, with the RDF data to be released in 2025 with the next Bgee update.
BioMoQA : Biodiversity Monitoring with Question-Answering
Project Description
The main objectives of the BioMoQA projects were the following: 1. Increase the question-answering skills of the SIBiLS/Biodiversity PMC services to extend the user base to ecological & environmental sciences (provide satisfying answers to questions such as «what soils are available in Indonesia ?»); 2. Annotate a growing corpus of publications with relevant vocabularies for ecological and environmental sciences; 3. Communicate about achievements of the project via presentation, blogs or scientific articles.
Project Results
La totalité des objectifs a été atteinte selon les indicateurs suivants: une liste de questions exemple (N=50) a été créée et testée sur le moteur de question-réponse, cf. Figure 1; 2. l’univers des publications s’est développé en direction de disciplines telles que l’écologie et les sciences environmentales (e.g., +40'000 documents de la Biodiversity Heritage Library, +12 journaux moissonés) avec des annotations incluant des vocabulaires tels que AgroVoc, utiles pour l’agro-écologie (+11 159 638 annotations, 01.05.2025). 3. deux nouveaux articles sont publiés ou en cours de publication: a) Unlocking the potential of PubMed Central Supplementary Data Files, Gobeill et al. (https://doi.org/10.1093/bioadv/vbaf155), b) Enhancing the SIB Literature Services (SIBiLS) with annotations to support biocuration, Caucheteur et al. (Database, accepted with minor modification).
Aktionslinie B5.1: Etablierung und Aufrechthaltung/Aktualisierung schweizweiter Best Practices von ORD-Fachwissen
Aktionslinie B5.1, “Establish and maintain/update Swiss-wide best practices of ORD expertise”, hatte zum Ziel, die Entwicklung von Best Practices im Bereich Data Stewardship zu unterstützen, die für alle Schweizer Hochschul- und Forschungsinstitutionen gelten könnten.
Establish and maintain/update Swisswide best practices of ORD expertise
Projektbeschreibung
Das Mandat sollte eine erste Analyse durchführen und einen darauf basierenden Plan entwickeln, wie Best Practices im Bereich Open Research Data (ORD) in der Schweiz in der nächsten Finanzierungsperiode (2025-28) systematisch erfasst, implementiert und aktuell gehalten werden können. Bestandteile waren eine Analyse der Ist-Situation (national und international) sowie die Entwicklung eines konkreten Plans, wie diese Best Practices unter Einbezug aller relevanten Stakeholder (z.B. Swiss Research Data Support Network SRDSN, Hochschulen, Forschungseinrichtungen etc.) implementiert werden können. Zum Auftrag zählte auch die Abstimmung mit den parallel vergebenen Mandaten B5.4 und C2.3. Erwartete Ergebnisse waren ein detaillierter Arbeitsplan für die Implementierung der Best Practices sowie ein Vorschlag bezüglich einer Organisationsweise oder Methode, mit der alle Stakeholder in die dauerhafte Pflege der Best Practices einbezogen werden können. Alle Erkenntnisse und Vorschläge sollten in einem Abschlussbericht zusammengefasst werden. Das Mandat wurde der Universität als Leading House übergeben, die Projektarbeit wurde einer Gruppe verschiedener Schweizer Institutionen unter Leitung der Universität Bern geleistet.
Projektresultate
Die Projektziele wurden erreicht. Als Herausforderung erwies sich der in Relation zur verfügbaren Zeit zu grosse Zuschnitt des Mandats. Eine Erhebung von ORD Best Practices in allen Wissenschaftsdisziplinen und von entsprechenden Support-Dienstleistungen im nationalen und internationalen Rahmen sowie die Kondensation dieser Erkenntnisse in praktische Schlussfolgerungen waren im gegebenen Zuschnitt nicht möglich. Aus inhaltlichen Gründen und solchen der Machbarkeit wurde daher auf den Aspekt des ORDSupports fokussiert (Details dazu siehe unten unter A.1.a und im Abschlussbericht). Auf diese Weise konnten dennoch detaillierte Empfehlungen erarbeitet werden, die konkrete Vorschläge für die Weiterentwicklung der ORD Landschaft in der Schweiz enthalten und zugleich für Entwicklungen, die in der Zukunft auf komplementären Handlungsfeldern angestossen werden können, anschlussfähig sind. Weitere Herausforderungen bestanden unter diesen Bedingungen bei der Zeitplanung, zumal auf begrenzte Verfügbarkeiten der Projektbeteiligten zu achten war.
Aktionslinie B5.2: Massnahmepläne zu Data Stewardship
Die Aktionslinie B5.2 des ORD-Aktionsplans hatte die Förderung von Data Stewardship und ORD Specialists an allen Hochschulen und Forschungsinstitutionen zum Ziel. Data Stewardship stand dabei in einem ersten Umsetzungsschritt im Fokus. Data Stewardship umfasste die Verwaltung und Überwachung der Datenbestände einer Organisation mit dem Ziel, den Zugang zu Forschungsdaten zu ermöglichen. Als solche war sie das Bindeglied zwischen Forschenden und Support-Einheiten in Form von IT, Bibliotheken und Infrastrukturanbietern. Data Stewards hatte eine aktive Beratungsrolle für Forschende übernommen und dienten als erste Anlaufstelle für alle Fragen zu (offenen) Forschungsdaten, z. B. zur Datensicherung, zur Langzeitaufbewahrung oder zum Datenmanagement.
Data-Steward-Programm der Universität Basel

Project Description
Since 2017, there has been a Research Data Management Network at the University of Basel, which initially consisted mainly of central service and infrastructure providers. The aim of the RDM Network is to support researchers along the entire research data lifecycle. As part of a pilot project funded by the Rectorate, this network was expanded from 2021-2022 to include decentralized data stewards embedded directly in the individual faculties. Part of the pilot project was the introduction of a train-the-trainer program to empower the data stewards and strengthen the network and knowledge exchange between them. These decentralized data stewards act as a subject-specific first point of contact for researchers. They provide tailored guidance, act as intermediaries to specialized service units, and help align faculty-specific needs with institution-wide RDM solutions.
With the support of swissuniversities (as part of action line B5.2 – action plans on data stewardship) the data stewardship program at the University of Basel was consolidated and expanded beyond the pilot phase. Key measures included onboarding new data stewards across all faculties, departments and university institutes, implementing a comprehensive training program, developing discipline-specific best practices, and integrating RDM into doctoral education.
Project Results
Between January 2023 and June 2025, the Data Stewardship Program significantly expanded and professionalized RDM support at the University of Basel. Onboarding discussions were held with 18 university units, resulting in the appointment of 16 new data stewards. Currently, 39 data stewards are active across all seven faculties and university institutes.
The train the trainer program was continued, offering the data stewards 18 courses over two and a half years, alongside 5 kickoff events and 3 Data Stewardship Conversations.
Three intensive “sprints” addressed high-priority university-wide challenges: (1) handling personal data in research, (2) assessing researchers' needs with regard to collaboration tools for sensitive research data, and (3) managing data at the end of research projects. While one sprint resulted in an internal report, the other two produced practical guidelines for researchers that have been published on Zenodo.
To help researchers translate general RDM principles into local workflows, the project launched pilot initiatives to develop discipline-specific best practices. These included a comprehensive RDM guide at the Faculty of Psychology and a checklist for onboarding and offboarding processes at the Department of Biomedicine. These examples offer concrete models that can be adapted by other departments in the future.
To raise awareness of the services and strengthen the visibility of the data stewards, eight roadshows were conducted across selected faculties and departments.
In collaboration with ten doctoral programs and graduate schools, six pilot courses for doctoral candidates were developed and delivered across multiple disciplines. The initiative led to sustainable collaborations and increased RDM visibility among early-career researchers.
A key achievement of the project was the revision of the network’s governance. To ensure the sustainability of the data stewardship program, a permanent position has been created at the University Library to coordinate the RDM Network beyond the project phase.
Massnahmenplan "Data Stewardship" der Universität Luzern

Project Description
The project “Data Stewardship Action Plan” at the University of Lucerne aimed to establish a central coordination office for Open Science and, in particular, Research Data Management (RDM). This office provides guidance, training, and strategic support to strengthen the visibility and institutional integration of Open Science topics. It engages with internal stakeholders (e.g., IT, legal services, ethics board) and supports university-wide developments such as the Open Science Policy and the research information system.
Collaborations were initiated with both internal partners and regional institutions, notably with the Lucerne University of Teacher Education and the Lucerne University of Applied Sciences and Arts. Together, the institutions developed a cross-campus RDM curriculum for researchers. On the national level, the University of Lucerne enhanced its engagement through participation in networks such as the Swiss Research Data Stewardship Network (SRDSN) and additional swissuniversities initiatives.
All project goals were fully achieved. The coordination office is now a permanent and well-established structure embedded in both the strategic and operational frameworks of the university. A wide range of activities, including training sessions, workshops, informational materials, and targeted events, increased visibility and awareness among researchers. The high demand for consultations and the positive feedback from faculties and leadership confirm the effectiveness and relevance of the measures.
The continuation and funding of the coordination office are secured beyond the project. This ensures the long-term sustainability of its impact. Furthermore, the project fostered good practices in areas such as academic career development, teaching, and recruitment—by integrating Open Science principles into institutional processes.
Data Stewards@UZH

Project Description
Research data – from brain scans in medicine to climate measurements in geography – is valuable for scientific progress. Yet after the initial study is complete, datasets often sit unused because they're difficult for other researchers to find, understand, or access. The University of Zurich's Data Stewardship project aims to address these challenges.
We established a network of 30 Data Stewards – experts who help researchers manage their data according to FAIR principles: making data Findable, Accessible, Interoperable, and Reusable.
Project Results
Our Data Stewards developed practical solutions: user-friendly upload tools for genomics data, converters for microscopy images, and secure transfer systems for field research. They integrated FAIR principles into university courses and created specialized guides (how-to resources) for different research disciplines.
Well-managed research data can be reused by other scientists, potentially accelerating discovery and saving resources. When researchers can build on existing work rather than starting from scratch, science becomes more efficient and collaborative.
The UZH Data Stewardship Network contributes to UZH's commitment to responsible data practices, helping ensure that research investments create lasting value. This work supports a more open and collaborative approach to research – one step at a time.
Data Stewardship at USI
Project Description
The project “Data Stewardship at USI” examined the state of Research Data Management (RDM) and Open Research Data (ORD) practices at Università della Svizzera italiana (USI). Its primary goal was to identify existing gaps, propose measures to address them and set a long-term vision on RDM and ORD according to USI Strategic Planning. As part of the project, the roles and responsibilities of the Data Steward, along with the operational framework, were defined. The project also aimed to foster synergies between the Data Steward and relevant USI services and departments - such as IT and Legal - to ensure the effective implementation of RDM and ORD best practices. The project resulted in several initiatives that have significantly enhanced the comprehension and adoption of RDM and ORD principles and practices at USI. These efforts culminated in the establishment of a robust, holistic support system for researchers. At its core, the project helped researchers adopt best practices in RDM and ORD and fostered the creation of an environment in which researchers have the opportunity to develop their skills on these areas, acknowledging the growing importance of data management in today’s academic environment. Through this commitment, USI has positioned itself as an active participant in national and international discussions on these critical topics.
Project Results
As part of the Data Stewardship initiative at USI, several measures were implemented to support researchers in managing and sharing their research data effectively, and the institution in positioning itself in the Swiss RDM and ORD landscape:
- dedicated web pages were developed to provide centralized access to guidance, tools, and institutional resources;
- a curated list of institutional databases was published to promote their use within the academic community;
- biannual training workshops on DMPs were launched, targeting all interested researchers and in particular SNSF project holders. Individual support for drafting DMPs and SNSF project budgets was also made available;
- close collaboration with IT services was established on key issues such as data storage, security, and access to research data;
- institutional procedures were defined for acquiring and managing research databases, involving IT and Legal team where needed, and promoting the reuse of institutionally-owned data resources;
- a feasibility study on personal data protection led to the development of an action plan with implementable measures to support researchers handling sensitive data;
- draft guidelines on RDM practices were prepared to provide clearer institutional direction;
- two internal funding calls were organized in 2023 and 2024. A total of 7 ORD-focused projects were awarded for a total budget of CHF 340,000;
- active support was granted to researchers for submitting ORD-related PgB proposals.
Together, these efforts contribute to a solid, institution-wide system for RDM support, empowering USI researchers to adopt best practices and meet evolving data management requirements.
Action Plan Data Stewardship ETH Zurich (2023-2024) – DSETHZ

Projektbeschreibung
Das Projekt DSETHZ wurde an der ETH Zürich durchgeführt, unter Leitung der ETH-Bibliothek und in Kooperation mit den ID Scientific IT Services (SIS) sowie einer Pilotgruppe aus Data Stewards an 6 ETH-Departementen. Projektziele waren (1) die Etablierung von Data Stewards innerhalb der ETH Zürich zu incentivieren, (2) vorbereitende Schritte zu dieser Etablierung zu unternehmen, sowie (3) Personen mit Data-Stewardship-Aufgaben untereinander und mit den zentralen Dienstleistern fürs Forschungsdatenmanagement (FDM) zu vernetzen. Diese Ziele wurden durch zwei Tracks unterstützt: (A) Kommunikation und Austausch unter Data Stewards und ETH-Mitarbeitenden mit Aufgaben im FDM mittels dem «Data Stewardship Network an der ETH Zürich»; (B) Die Implementation von ORD-Praktiken innerhalb von Forschungsgemeinschaften an der ETH, insbesondere durch die Umsetzung von Unter-Projekten der Pilotgruppe aus Data Stewards (u.a. Aufbau von FDM-Trainingsangeboten, die Einführung eines FDM-Systems in Forschungsgruppen, Erarbeitung von Datenpublikationsworkflows), durch gezielte Trainingsangebote der zentralen FDM-Dienstleister (d.h. Bibliothek und SIS), und durch die Entwicklung von Anleitungen zur systematischen Umsetzung von FDM in Forschungsgruppen.
Projektresultate
Im Rahmen des Projekts DSETHZ an der ETH Zürich wurde eine zentrale Austauschplattform für Mitarbeitende mit Verantwortung im Forschungsdatenmanagement (FDM) geschaffen. Diese Plattform vernetzt die Beteiligten über die gesamte ETH Zürich hinweg im Data-Stewardship-Netzwerk (DSN). Durch das DSN wird der Austausch zur guten Praxis im Umgang mit Forschungsdaten gefördert und institutionell verankert. Durch regelmäßige Netzwerktreffen, Workshops und eine FDM-Seminarreihe wurde ein lebendiger Dialog zwischen Data Stewards, weiteren ORD-Fachpersonen und zentralen FDM-Dienstleistern ermöglicht und aufrechterhalten. Entwickelt wurden zudem praxisnahe Leitfäden, die die Umsetzung der ETH-internen FDM-Guidelines unterstützen. Eine Pilotgruppe von Data Stewards in Forschungseinheiten und Departementen wurde aktiv eingebunden. Ihre unterschiedlichen Rollenprofile wurden in ETH-internen News vorgestellt, um ihre Sichtbarkeit zu fördern und Anreize zur Etablierung von Data Stewardship zu setzen. Die Erkenntnisse über ihre unterschiedlichen Aufgaben liefern wertvolle Grundlagen für die Weiterentwicklung von Data-Stewardship-Modellen an der ETH. Im Rahmen des Pilotprogramms setzten ProjektpartnerInnen konkrete Maßnahmen zur Implementierung von FDM-Praktiken in ihren Forschungseinheiten um. Dazu gehörten u.a. der Aufbau von FDM-Systemen, die Entwicklung von Datenpublikationsworkflows, die strukturierte Erfassung bestehender Datensätze, sowie die Erweiterung von Schulungsangeboten zum FDM. Durch dieses Projekt wurden die unterschiedlichen Tätigkeiten von Data Stewards beleuchtet, welche als MultiplikatorInnen und BrückenbauerInnen zwischen zentralen Diensten und Forschungseinheiten agieren. Die Zusammenarbeit der zentralen Dienste mit den Data Stewards hat sich als besonders wirkungsvoll erwiesen und wird weiterverfolgt. Durch die Organisation von ORD-Veranstaltungen, sowie die Entwicklung von FDM-Guidelines in Forschungseinheiten wurden wichtige Impulse für kollaborative Forschung gesetzt, bei welcher das Teilen von sorgfältig dokumentierten Forschungsdaten und nachvollziehbaren Forschungsergebnissen wesentlich ist.
Mise en place d’un réseau data stewardship au sein du Digital Hub de l’IHEID
Project Description
The Geneva Graduate Institute is a small (1200 FTE) independent postgraduate social science research and teaching institution focusing on international and development studies, in the midst of Geneva’s many international organisations.
The data stewardship project “IHEID Digital Hub” aimed at compensating for the lack of data stewards within our academic departments, due to a limited budget, by increasing collaboration between groups of stakeholders (IT, Research office, Library, Research centres, Academic departments).
Other goals included improving communication and awareness of open research data and research data management within our academic community, as well as providing training for the upskilling of early career researchers.
Project Results
The administration’s Open Science Working Group (regrouping IT, Library, Tech Hub, and Research Office) is now meeting once per term to discuss strategic issues and service evolution, a dedicated Webex space was created for internal communication on research data management, and a draft open data policy was prepared for discussion, although it still required more work to accommodate disciplinary cultural differences.
An open science practices survey was conducted among research staff, with disappointing results (very little interest in open science in general). Sadly, the data champions network planned within departments was a failure for that reason, but collaboration and exchanges notably improved with the representatives of research centres, leading to the creation of Zenodo communities, participation in the Institute’s Research Festival, the organisation of Open Research Cafés once per term, and the setup of an Open Science Corner in the new “village of centres”.
On the training side, we participated in Love Data Week in 2024 and 2025 (156 participants in 12 sessions), and developed an internal ECTS-credited course on open science and data management for PhD students and second-year Masters, with 8 participants completing the course on its first edition.
Cellule Data Stewardship HES-SO

Description du projet
Dans le cadre du programme Open Science I, le Dicastère Recherche et Innovation de la HES-SO a mis en place une « Cellule Data Stewardship HES-SO » composée de cinq data stewards – un·e par domaine, à l’exception des deux domaines artistiques regroupés sous un même poste – représentant un total de 1,7 équivalent plein temps. Cette cellule avait pour objectifs de :
Sensibiliser la communauté scientifique de la HES-SO sur les bonnes pratiques et enjeux relatifs à la gestion et à l’ouverture des données de recherche selon les principes FAIR et en conformité avec les cadres légaux et contractuels
Sensibiliser les parties prenantes sur leur rôle clé dans la mise en œuvre réussie de l’ORD
Identifier et évaluer de manière exhaustive tous les services, outils et expertises liés à la gestion des données de recherche au sein des 28 hautes écoles de la HES-SO
Identifier les particularités liées aux données de recherche propres à chaque domaine afin d’élaborer des lignes directrices adaptées.
Résultat du projet
L’un des résultats majeurs du projet réside dans la dynamique de sensibilisation qu’il a su instaurer au sein des hautes écoles de la HES-SO. Par le biais d’actions ciblées et diverses – ateliers, webinaires, formations, discussions (formelles et informelles) et entretiens – un large public de chercheur·euses et de parties prenantes a été sensibilisé aux bonnes pratiques en matière de gestion et d’ouverture des données de recherche, ainsi qu’aux enjeux juridiques, éthiques et scientifiques associés. Cette démarche a renforcé la culture institutionnelle autour de l’ORD et a agi comme un levier stratégique, incitant plusieurs hautes écoles à mettre en place un service interne de soutien à l’ORD.
En parallèle, la cartographie des services, outils et expertises existants au sein des 28 hautes écoles de la HES-SO a abouti à un inventaire structuré, facilitant l’orientation des chercheur·euses, la mutualisation des outils et l’identification des besoins en matière de soutien. Combinée aux résultats issus des entretiens menés dans chaque domaine, cette analyse a permis de mieux cerner les attentes du terrain et d’orienter les actions futures, notamment par la création d’outils concrets (FAQs, logigrammes, guides thématiques). Enfin, ce travail de cartographie a favorisé la structuration d’un réseau interne de collaboration entre les référent·es ORD des hautes écoles posant ainsi les fondations d’un écosystème pérenne de partage de pratiques et de mutualisation des ressources.
En complément, le projet a ouvert des espaces de collaboration interinstitutionnelle, notamment à travers l’organisation d’une demi-journée d’échange réunissant des chercheur·euses des deux domaines artistiques de la HES-SO ainsi que deux institutions suisses (FHNW, SUPSI). Cette rencontre a permis de discuter des défis spécifiques liés à l’ORD dans les disciplines artistiques, et de partager des bonnes pratiques émergentes.
Massnahmenplan zum Aufbau von Data Stewardship an der Pädagogischen Hochschule Bern (PHBern) - ADASTE:PHBern

Projektbeschreibung
Das Projekt ADASTE:PHBern (Aufbau Data Stewardship an der PHBern) war Teil der Umsetzung der Open Science-Strategie von swissuniversities an der Pädagogischen Hochschule Bern in den Bereichen Open Access und Open Research Data. Das Projekt zielte im Rahmen des Programms Open Science I auf den nachhaltigen Aufbau von Data Stewardship sowie auf die Förderung von Open Research Data (ORD).
Die zentrale Massnahme von ADASTE:PHBern bestand in der Schaffung der Stelle eines Data Stewards am Institut für Forschung, Entwicklung und Evaluation (IFE). Der Data Steward wurde Anfang 2023 unbefristet angestellt und ist seitdem fachlich verantwortlich für den Bereich Open Science an der PHBern. Er wurde ins Zentrum für Forschungsförderung (ZFF) eingebunden, der zentralen Beratungs- und Fachstelle für alle Anliegen im Bereich Forschung und Entwicklung. In Zusammenarbeit mit dem ZFF-Team und im Austausch mit den Forschungsleitenden und Forschenden der PHBern sowie mit dem Rechtsdienst, dem Netzwerk Digitale Transformation, der Information Security Group und der Ethikkommission war er in der Aufbauphase 2023-2024 verantwortlich für die Umsetzung der Einzelmassnahmen von ADASTE:PHBern.
Diese Einzelmassnahmen umfassten (1) die Einführung eines Beratungs- und Unterstützungsangebots in den Bereichen Forschungsdatenmanagement und ORD sowie (2) die Durchführung von Informationsveranstaltungen und Workshops; (3) die Vernetzung der verschiedenen involvierten Stellen der PHBern und die Herstellung von Kontakten zur nationalen ORD-Community durch den Data Steward; (4) den Ausbau der fachlichen Kompetenzen des Data Stewards durch kontinuierliche Weiterbildung. Zudem war (5) die Erarbeitung von Richtlinien und Policies für das Forschungsdatenmanagement und ORD vorgesehen.
Projektresultate
Die im Rahmen von ADASTE:PHBern geplanten Massnahmen konnten zum grössten Teil während der Aufbauphase umgesetzt werden:
- Beratung und Unterstützung: Der Data Steward berät und unterstützt die Forschenden der PHBern bei Fragen rund um Forschungsdatenmanagement und ORD. Es besteht dauerhaft ein Supportangebot in diesen Bereichen.
- Informationsveranstaltungen: Das ZFF bot und bietet regelmäßig Veranstaltungen zum Forschungsdatenmanagement und ORD für die Forschenden der PHBern an und informiert auf den internen Kanälen.
- Vernetzung: Es besteht ein internes und externes Netzwerk, das weiter gepflegt und ausgebaut wird.
- Weiterbildung: Der Data Steward nahm und nimmt regelmäßig Weiterbildungsangebote wahr und pflegt den fachlichen Austausch.
- Richtlinien und Policies: Anders als geplant, wurden verbindliche Richtlinien und Policies noch nicht eingeführt.
Was (5) betrifft, hat sich herausgestellt, dass die Einführung von verbindlichen Richtlinien und Policies nicht sinnvoll ist, bevor die nötigen Kompetenzen im Forschungsdatenmanagement aufgebaut sind. Im Anschlussprojekt ADASTE_plus wird es darum gehen, in Zusammenarbeit mit den Forschenden Best Practices und praktikable Prozesse im Umgang mit Forschungsdaten einzuführen und damit die Voraussetzungen für eine verbindliche ORD-Policy zu schaffen.
Insgesamt hat das Projekt ADASTE:PHBern maßgeblich zur Etablierung von Data Stewardship und zur Umsetzung von Open Science an der PHBern beigetragen. Die durchgeführten Maßnahmen haben zu einer nachhaltigen Aufwertung der Bereiche Forschungsdatenmanagement und ORD geführt.
Data Stewardship PHLU

Project Description
Basierend auf der Nationalen Schweizer Strategie für Open Research Data (ORD) setzte sich die Pädagogische Hochschule Luzern den Aufbau von Data Stewardship zum Ziel. Mit dem Projekt wurde angestrebt, eine institutionelle Grundlage für das Forschungsdatenmanagement (RDM) an der PH Luzern zu schaffen, die den FAIR-Prinzipien (FAIR, Findable, Accessible, Interoperable und Reusable), entspricht und ORD sowie OA fördert. Ziel war es, rechtliche, technische und organisatorische Voraussetzungen zu schaffen, um Mitarbeitende in der Datenverwaltung und -nutzung zu unterstützen.
Project Results
Während es im Jahre 2023 darum ging, die Grundlagen für das Data-Stewardship-Projekt an der PH Luzern auszuarbeiten (u. a. die ORD-Policy sowie die Anpassung der Projekt- und Publikationsdatenbank), eine Bedürfnisabklärung bei den Mitarbeitenden durchzuführen und Kontakte mit diversen internen sowie externen Akteuren (Rechtsdienst und ICT der PH Luzern, Kooperation mit den Luzerner Hochschulen und weiteren Pädagogischen Hochschulen der Schweiz) aufzubauen, konnten 2024 diese umgesetzten Massnahmen weiterentwickelt werden. So wurden im Jahre 2024 zusammen mit dem Rechtsdienst Mustervorlagen und Leitlinien für rechtliche Abklärungen entwickelt, welche in zahlreichen durchgeführten Beratungen direkt Verwendung fanden. Darüber hinaus wurde der Kontakt zum aufgebauten Netzwerk gepflegt und intensiviert (siehe Abbildung 1). Im Rahmen dieser Kooperationen wurden Workshops und Events durchgeführt (siehe Auflistung Austauschtreffen/Workshops).
Weiter standen folgende Beratungsthemen im Fokus: DMP (Forschungsdaten und -ergebnisse digital archivieren), Datenschutz, Geheimhaltungspflicht, Datenmanagement und Dokumentation mit R, «Principles of Good Scientific Practice», Open Access und Informationssicherheit.
Das Projekt wurde jährlich in der Leistungsbereichskonferenz für Forschung und Entwicklung an der PH Luzern besprochen. Um die geleisteten Arbeiten zu verstetigen, den Wissenstransfer innerhalb der Institution zu gewährleisten und die strategische Weiterentwicklung von Open Science fortzusetzen, verfolgt die PH Luzern die im Rahmen von Open Science II ausgeschriebenen Projektziele. Längerfristig setzt sich die PH Luzern zum Ziel, das Konzept von Data Stewardship nachhaltig zu integrieren. Der grundlegende Betrieb soll nach der Förderperiode für Open Science II weitergeführt werden.
Während der Projektdauer nahm der Open Research Data Steward, Sebastian Stuppan, an diversen Austauschtreffen/Workshops mit anderen Hochschulen bzw. von swissuniversities zu Themen wie ORD, Einverständniserklärung, Data Life Cycle, Non-Invasive Data Governance, rechtliche Rahmenbedingungen von ORD, Sekundäranalysen, Management von vertraulichen Forschungsdaten etc. teil. Im Jahr 2024 leitete er Workshops oder veranstaltete Events zu OS. Dabei arbeitete er entweder mit weiteren RDM-Spezialist*innen zusammen oder führte diese Anlässe eigenständig durch.
Implementierung von fachspezifischem Forschungsdatenmanagement-Support an der Universität Bern
Projektbeschreibung
Das Projekt «Implementation von fachspezifischem Forschungsdatenmanagement-Support an der Universität Bern» (Antragsteller/Leading House: Universität Bern) zielt auf den Ausbau des bestehenden, zentral an der Universitätsbibliothek (UB) angesiedelten Support im Forschungsdatenmanagement (FDM) zu einem breiten domänenspezifischen Schulungs-, Beratungs- und Unterstützungsangebot für das Forschungsdatenmanagement (Data Stewards). Es wurden domänenspezifische Anlaufstellen für alle Fragen des FDM geschaffen, die zugleich stärker als zuvor mit den anderen Unterstützungseinheiten der Universität im Bereich Datenerhebung und -verwaltung vernetzt sind. So wird eine nahtlose FDM-Support-Landschaft für Forschende realisiert. – Zu diesem Zweck wurde der bestehende FDM-Support um drei Stellen erweitert und das Support-Modell von einem fachunspezifischen Support auf Support durch Data Stewards umgestellt. Die sieben Data Stewards arbeiten eng mit den Forschenden ihrer jeweiligen Domäne sowie den Infrastruktur- und Forschungsunterstützungseinheiten der Universität zusammen. Querschnittsbereiche (QSB) des FDM-Supports adressieren spezifische Probleme quer durch alle Domänen.
Projektresultate
Projektziele waren:
1) Implementierung fachspezifischer Standards. Es wurden neue Veranstaltungen und Formate zur Vernetzung und Sensibilisierung für disziplinäre FDM-Problemlagen und -Lösungen eingeführt. Gemeinsam mit der Berner Fachhochschule (BFH) wurde die Veranstaltung «Bern Data Talks» konzipiert und bisher drei Mal durchgeführt, in der Forschende aus verschiedenen Fachrichtungen sich in informeller Atmosphäre über FDM-Probleme und -Praktiken austauschen. Zudem wurde ein Sensitive-Data-Event durchgeführt, das gemeinsam mit Forschenden den Umgang mit sensiblen Daten diskutierte. Im Februar findet die Veranstaltung «Data licensing and legacy forum. Legal and ethical insights» für Fächer wie Geschichte, Archäologie, Ökologie, Geografie statt, die sich dem Umgang Legacy-Daten widmet. Mit Services zu IIIF- und TEI-Publisher wurden Dienstleistungen zu zwei zentralen Standards für die Publikation digitaler Bilder und Texte implementiert, dies gemeinsam mit Digital Humanities (DH), Data Science Lab (DSL) und IT.
2) Zentrale Anlaufstelle für FDM-Fragen, Aufbau und Konsolidierung neuer Dienstleistungsangebote in Kooperation mit Partner*innen. Die Data Stewards sind die zentrale Anlaufstelle für FDM. Die Kooperation mit anderen Forschungs- und Unterstützungsabteilungen wurde intensiviert: Direktion Lehre und Forschung (DLF) des Inselspitals, DH, DSL, Vizerektorat Forschung und Innovation (VRFI), Core Facilities. Neben den TEI-Publisher- und IIIF-Services wurde gemeinsam mit der DLF ein Support-Workflow über den gesamten Forschungszyklus für die Forschung am Inselspital entwickelt.
3) Nachhaltige Kultur des FDM. Gemeinsam mit dem VRFI wurde eine Forschungsdatenguideline für die Universität Bern als Grundstein einer institutionsweiten nachhaltigen FDM-Kultur erstellt. Für Forschungsgruppen (z.B. Pathologie) wurden spezifische FDM-Guidelines entwickelt. FDM-Angebote für Early-career-Forschende wurden im Rahmen der Kurse zu überfachlichen Kompetenzen ausgeweitet und neu etabliert. Zudem wurde eine Walk-in-Sprechstunde für Forschende als niedrigschwelliges Beratungsformat eingeführt.
Data Stewardship UniNE
Description du projet
Située entre Genève, Berne et Zurich, l’Université de Neuchâtel (UniNE) se compose de quatre facultés qui accueillent quelque 4200 étudiantes et étudiants, dont 50% proviennent d’autres cantons suisses et 22% de l’étranger. On y propose des bachelors, ainsi que des masters en Lettres et sciences humaines, Droit, Sciences et Sciences économiques, souvent originaux, tous reconnus par la Déclaration de Bologne.
Avant le projet swissuniversities, la thématique des Open Research Data (ORD) était très peu développée à l’UniNE. L’objectif du projet visait à promouvoir les ORD et le Data Stewardship à l’UniNE.
Cela signifie concrètement 1) doter l’UniNE d’une stratégie ORD se traduisant dans une directive ORD pour la communauté UniNE, 2) fournir un support aux chercheurs en matière de gestion des ORD par des personnes spécialement formées sur cette thématique (Data Stewards) dans les différentes facultés, dans les bibliothèques et au Grant office.
Résultats du projet
Les objectifs fixés dans le cadre du projet ont été atteints. 1) L’UniNE s’est dotée d’une stratégie ORD traduite par une directive; 2) L’UniNE est devenue membre de SWISSUbase qui est la plateforme officielle d’hébergement des ORD pour la communauté UniNE; 3) L’UniNE fournit un support aux chercheuses et chercheurs en matière de gestion des ORD sous forme de Data Stewardship; 4) un outil est à disposition pour la réalisation du Data Management Plan (DMP); 5) des informations détaillés sur la thématique ORD figurent sur des pages spécifiques du site web de l’UniNE; 6) différentes formations sur les ORD sont proposées pour différents publics (notamment pour les doctorants en collaboration avec la CUSO).
Un des challenges était que, s’agissant d’une nouvelle thématique pour l’UniNE, tout était à faire dans ce domaine. Nous avons eu la chance de pouvoir engager une personne qui avait déjà travaillé comme data steward dans une haute école étrangère (Science Po à Paris) et qui bénéficiait d’une bonne expérience et d’excellentes compétences en ORD. Nous avons eu un excellent soutien du rectorat. La principale difficulté rencontrée concerne les chercheuses et chercheurs qui en théorie sont toutes et tous très favorables aux ORD mais en pratique se montrent parfois réluctants à déposer et ouvrir leurs données. Les obligations formulées par les organismes de financement ne sont malheureusement pas toujours respectées et cela reste sans conséquences. L’UniNE était également partenaire du projet swissuniversities recORD qui visait à faire évoluer cette situation mais on se rend compte qu’il n’y a pas de baguette magique et que le chemin est encore long.
Massnahmenplan Data Stewardship
Projektbeschreibung
Der Massnahmenplan Data Stewardship zur Umsetzung der BFH-Strategie Open Science dient dazu, die Praxis der Open Research Data (ORD) in der wissenschaftlichen Tätigkeit der BFH-Angehörigen zu stärken und eine Kultur des gezielten Forschungsdatenmanagements (Research Data Management, RDM) zu etablieren. Die geplanten Massnahmen basieren auf der Open Science-Strategie sowie auf einer Bedarfsanalyse zu RDM und ORD an der BFH. Die Schwerpunkte liegen in folgenden Bereichen:
- Kompetenzaufbau auf institutioneller Ebene, Rekrutierung und Ausbildung von Data Stewards
- Auf- und Ausbau von Dienstleistungs- und Supportangeboten zu ORD, Aufbau von Infrastruktur
- Einbezug von Data Stewardship in der Ausbildung des wissenschaftlichen Nachwuchses
- Schaffung entsprechender Weiterbildungsangebote für Forschende und Lehrende
- Vernetzung und Kooperation mit weiteren Hochschulen
- Aus- Und Weiterbildungsangebote für Data Stewards, Wissenstransfer
Projektresultate
Der auf zwei Jahre angelegte Massnahmenplan Data Stewardship sah zehn Massnahmen vor (M0 – M9), deren Abschluss für 2024 geplant war. Erfreulicherweise konnten zwei Massnahmen bereits 2023 abgeschlossen werden (Aufbau RDM-Community (M5), Aufbau ORD-Monitoring (M9)).
Die übrigen acht Massnahmen wurden 2024 abgeschlossen.
Für die drei Weiterbildungsmassnahmen (für Data Stewards (M3), Forschende (M4) und Studierende (M6)) wurden auf Initiative der BFH in Zusammenarbeit mit weiteren Fachhochschulen (Hochschule Luzern, Interkantonale Hochschule für Heilpädagogik, Pädagogische Hochschule Zug, Pädagogische Hochschule Zürich, Universität Luzern) Unterrichtsmaterialien sowie Kompetenzprofile erarbeitet. Die Umsetzung der Schulungen für Forschende erfolgte 2024 mit einer ersten Schulungsreihe, die während der Love Data Week vom 12. bis 16.2.2024 lanciert wurde. Die geplanten Weiterbildungen für Studierende, die gemäss ursprünglicher Planung in verschiedene Curricula als Teilmodule hätten eingebaut werden sollen, wurden aufgrund von unerwarteten Hürden und einer zu langen Implementierungsdauer schliesslich in Form von mehreren Kurzvideos umgesetzt. Diese werden den Dozierenden sowie Studierenden via interner Lernplattform zur individuellen Integration in den Unterricht zugänglich gemacht.
Für die fachspezifische Umsetzung von ORD in den Departementen (M2) wurde ein Fördergefäss entwickelt, welches 2024 angeboten wurde und ab 2025 als Teil des Fonds Open Science der BFH verstetigt wird. Das Fördergefäss diente dazu departementale Einzelprojekte finanziell zu unterstützen, vorallem im Bereich von Personenstunden für die Aufbereitung von Forschungsdaten.
ORD Stewardship FHNW
Projektbeschreibung
Mit dem Projekt ORD Stewardship stiess die FHNW die Erweiterung interner Strukturen und Services im Forschungsdatenmanagement (FDM) erfolgreich an. Die langfristigen Ziele waren, die Kultur des offenen Forschungsdatenmanagements (oFDM) zu fördern und ein optimales FDM im Sinne der FAIR-Prinzipien zu ermöglichen. In diesem Sinne sensibilisierte das Projekt interne Entscheidungsträger*innen in der Direktion, den Hochschulen sowie in den zentralen und dezentralen Services für die Herausforderungen von oFDM. Es stiess den Kompetenzenaufbau und die Entwicklung von Beratungsservices zu oFDM zentral in der FHNW an. Zur Erreichung dieser mittelfristigen Ziele integrierte die FHNW die Thematik ORD in die rechtlichen Rahmenpapiere der FHNW. Zudem setzt sie eine:n Beauftragte:n für FDM auf Ebene FHNW und Data Stewards in drei Pilothochschulen ein. Diese evaluierten die vorhandenen Verantwortlichkeiten, Angebote sowie Infrastruktur für O-FDM und entwickeln ein Konzept für deren Optimierung. Sie entwickelten zudem einen Aktionsplan für die Umsetzung des Konzepts unter Einbindung der anderen Hochschulen bzw. Datengemeinschaften der FHNW.
Projektresultate
Im Jahr 2023 wurden die zentralen Projektgremien (Expertisen-AG, Data Stewardship Panel) aufgebaut. Der Kreis der einbezogenen internen Expert*innen wurde stetig erweitert. Das Projekt konnte das interne sowie externe Netzwerk zu Fragen von ORD stark ausbauen. Externe Expert:innen (andere FHs, Switch, NDB, SNF) wurden für Sensibilisierungsmassnahmen eingesetzt. Das Projekt übertraf hier den geplanten Rahmen mit einer intensiven Debatte zu O-FDM und Schutz vor Wissenschaftsspionage/Anforderungen an Geheimhaltung. Zweites Ziel war die Erarbeitung der rechtlichen Rahmen der FHNW für (offenes) FDM. Diese Erarbeitung nahm mehr Zeit in Anspruch als ursprünglich gedacht und zog als Konsequenz nach sich, dass eine Vielzahl von bereits existierenden Dokumenten in einem parallellaufenden Prozess angepasst bzw. erweitert werden müssen. Eine Open Science Policy FHNW, welche auch ORD hinreichend berücksichtigt, ist in der Vernehmlassung der Direktion (Entscheidungsgremium FHNW). Ergänzend liegt ein Merkblatt FDM FHNW vor, dass im Sommer ebenfalls in die Vernehmlassung geht. Basierend auf den beiden neuen und den angepassten Dokumenten werden die FHNW Hochschulen ihre internen Dokumentationen weiterentwickeln.
Das im Oktober 2023 eingesetzte Data Stewardship Panel evaluierte das angestrebte Data-Stewardship Modell (1 Steward pro Hochschule) für die 3 Pilothochschulen. Im Ergebnis verfolgt die FHNW das dezentrale DS-Model nicht weiter, baut jedoch Beratungskapazitäten auf zentraler Ebene aus, zu denen die Hochschulen individuell Zugang erhalten, und unterstützt die FHNW Hochschulen im Expertisenaufbau entsprechend ihrer jeweiligen Strukturen (ORD Beratung kann über die Bibliothekexpert*innen oder den Forschungssupport erfolgen). Im 2024/25 wurden die zentralen Vorarbeiten dafür geleistet: Dies umfasste die Schwerpunkte Angliederung ORD an das Vizepräsidium Hochschulentwicklung (80% Fachperson), Breitstellung von Dokumenten und Informationsmaterialien, Wissenserwerb DS sowie Infrastrukturevaluation. Alle Schwerpunkte wurden mehrheitlich abgeschlossen. Die Fachperson O-FDM wurde in das Grants Office integriert und wird im Jahr 2025 ein Vouchersystem für O-FDM-Services etablieren. Parallel wird in Zusammenarbeit mit der Bibliothek FHNW ein Trainingsprogramm aufgebaut und soll ab Herbst 2025 starten. Durch Weiterbildungen der Data Stewards und Austauschen mit anderen HS eignete sich die FHNW grundlegendes Wissen zu FDM an und entwickelten Schulungen. Dieses Know-how wird im oben erwähnten Vouchersystem zentrale Grundlage für die Angebote an die FHNW Hochschulen sein. Die Hochschule für Musik entwickelte eine tech. Lösung zur Archivierung spezifischer Datenformate.
B5.2 Massnahmen zu Data Stewardship HSLU
Projektbeschreibung
Die Hochschule Luzern (HSLU) führt das Projekt durch und setzt anhand eines Massnahmenplans unterstützende Angebote im Forschungsdatenmanagement um.
Das Projektziel bestand darin, das Forschungsdatenmanagement (FDM) an der HSLU durch die Vernetzung bestehender Servicestellen und die Klärung von Schnittstellen zwischen Kompetenzbereichen zu stärken. Es zielte darauf ab, das Serviceangebot weiter aufzubauen und sichtbar zu machen und damit gute wissenschaftliche Praxis im FDM zu stärken. Verschiedene Akteure der HSLU-Forschung arbeiteten gemeinsam an der Entwicklung der Massnahmen. Ein Konzept für ein Netzwerk unter Forschenden soll dazu animieren als "Ambassadors" für Data Stewardship innerhalb ihrer Community zu wirken.
Einzelne Projektschritte:
- Netzwerkbildung und Etablierung Data Stewardship
- Klärung der Rahmenbedingungen an der HSLU (ORD Policy)
- Entwicklung eines Informationsportals, das Forschenden leichten Zugang zu Informationen bzgl. FDM bietet
- Aufbau eines Schulungsprogramms
- Sensibilisierungskampagne an der HSLU
- Gewinnung von Data Stewardship Ambassadeurs
Projektresultate
Netzwerkbildung: In den Jahren 2023 und 2024 fanden Netzwerktreffen mit den im Data-Stewardship-Netzwerk eingebundenen Servicestellen statt. Im September 2025 ist ein weiteres Treffen geplant, das sowohl Servicestellen als auch Forschende (Ambassadors) zusammenbringt. Die Veranstaltung markiert den Abschluss der ersten Projektphase und bildet gleichzeitig den offiziellen Auftakt des Ambassador-Programms.
Fazit: Das Netzwerk – insbesondere die Servicestellen - wurde gebildet, Anmerkungen siehe Frage 2b
Rahmenbedingungen an der HSLU: Im Mai 2024 wurde die Open Science Policy der HSLU eingesetzt. Sie enthält einen aktualisierten Teil zu Open Access und einen neu eingesetzten Teil zu Open Research Data an der HSLU.
Fazit: Rahmenbedingungen HSLU wurden geschaffen, Anmerkungen zu den departementsspezifischen ORD-Richtlinien siehe Frage 2b
Informationsportal: Das Data Stewardship Portal der HSLU ist online. Es bündelt Informationen rund um das Forschungsdatenmanagement, stellt Ansprechpersonen und Servicestellen im HSLU-weiten Netzwerk vor, informiert über das Ambassador-Programm und bietet einen laufend aktualisierten Newsbereich zu relevanten Entwicklungen und Angeboten.
Fazit: Informationsportal wurde entwickelt/aufgeschaltet
Schulungsangebot: Eine strukturierte Kursreihe mit fünf Modulen à 60 Minuten zum Forschungsdatenmanagement wurde in Kooperation mit anderen Schweizer Hochschulen zusammengestellt. Die Online-Kurse wurden im Februar 2024 während der ‘Love Data Week’ erstmals durchgeführt und werden jedes Semester wiederholt.
Fazit: Schulungsprogramm wurde aufgebaut
Sensibilisierungskampagne: Das Data Stewardship Portal wurde mit einer Kampagne vorgestellt. Die Kampagne beinhaltete Flyer und eine Veranstaltung an der Love Data Week 2025.
Fazit: Sensibilisierungskampagne läuft
Data Stewardship Ambassadeurs: Im Rahmen der konzeptionellen Arbeiten zum Aufbau eines Ambassador-Programms erweiterte man die inhaltliche Ausrichtung auf Open Access und Open Research Data. Durch eine integrierte Ausrichtung von Open Science Ambassadors können Synergien genutzt und die Sichtbarkeit von Open Science und Forschungsdatenmanagement hochschulweit gestärkt werden.
Fazit: Die Etablierung von Ambassadoren wurde initiiert und kann im Folgeprojekt (2025/2026) fortgesetzt werden.
SUPSI ORD Stewardship Action Plan
Project Description
In line with the Open Research data national Strategy, this project aimed at addressing the existing gaps related to Open Science (OS) and Open Research Data (ORD) identified at the University of Applied Sciences and Arts of Southern Switzerland (SUPSI), ranging from organization creation to competence strengthening and cultural awareness. Within this setting, eight objectives have been identified, four regarding the academic community (understand, apply, embed and advocate) and four concerning the institution (assimilate, align, support and contribute). These have been included in the action plan composed by five topics, namely 1) establishing an ORD Alliance, 2) form ORD stewards for each SUPSI department, 3) foster ORD practices within the institution, 4) develop a SUPSI ORD policy, 5) adapt institutional infrastructures and processes. To realize this action plan, we worked in close collaboration with the existing services (libraries, research direction, IT services and legal services).
Project Results
Overall, most of the activities declared in the action plan (12 out of 16) have been fully performed, while the remaining 4 have been partially performed. More in details, all activities regarding the first three topics of the action plan (i.e.: esablishing an ORD alliance, form ORD Stewards for each SUPSI department and foster ORD practice within SUPSI), as well as 3 out of 4 activities concerning the 4th topic (develop ORD policy in SUPSI), have been fully performed. Three out of 5 milestones (i.e.: establish the ORD alliance, train the departmental steward and adopt the implemented ORD policy) have been fully achieved, while the remainig 2 (i.e. ORD infrasructure and guidelines are delineated and academic community has reached ORD awareness) have been partially achieved. We also performed several additional activities (not included in the action plan) to stregthen the project, namely the administration of two surveys to all SUPSI academic community (one on ORD knowledge and practicies and the other on Open Science and academic career), the organization of several seminars on specific Open Science and ORD topics and the creation of the SUPSI Open Science Competence Centre (CC-OS). We faced some challenges related to the revision at the SUPSI level of 1) the research website and 2) human resources valorisation and career patterns, that prevented from the full completion of 4 activities related to topics 4 and 5 (develop ORD policy in SUPSI and Infrastructure and processes in SUPSI).
Preparing Readiness for Data Stewardship — FH Graubünden
Projektbeschreibung
Das Projekt hat zum Ziel, die Bibliothek der FH Graubünden darin zu stärken, im Kontext ihrer spezifischen Möglichkeiten und Herausforderungen (kleine Hochschule mit begrenztem Volumen an nicht-industriell finanzierter Forschung), Beratungen und Dienstleistungen in den Bereich Open Science, Forschungsdatenmanagement und Openness anzubieten. Diese Dienstleistungen sollen den Forschenden der Hochschule bedarfsgerecht zur Verfügung stehen.
Der Fokus liegt dabei auf dem Aufbau von Fachwissen und einem umfassenden Überblick über die bestehenden Angebote in der Schweiz, auf die bei Bedarf verwiesen werden kann.
Projektresultate
Die Projektziele wurden grundsätzlich erreicht. Im Verlauf des Projekts wurde deutlich – unter anderem bei Treffen, die von swissuniversities im Rahmen des Gesamtprojekts organisiert wurden –, dass das Thema Data Stewardship vor allem von grösseren Hochschulen aktiv vorangetrieben wird. Dies ist kein schweizspezifisches Phänomen, sondern zeigt sich auch in anderen Ländern. Nur dort, wo ein expliziter politischer Wille besteht, alle Hochschulen in das Thema einzubinden, und zugleich die politischen Möglichkeiten vorhanden sind, Hochschulen zur Mitwirkung zu verpflichten (z. B. in Kanada oder Dänemark), gestaltet sich die Situation anders.
Diese Erkenntnis war zu erwarten, wurde im Projekt jedoch nochmals bestätigt. Kleine Hochschulen, wie die FH Graubünden, stehen in der Schweiz beim Thema Data Stewardship weitgehend allein und die erforderlichen Strukturen und Kompetenzen eigenständig aufbauen. Gleichzeitig blieb die Anzahl an Anfragen von Forschenden in solchen Hochschulen bislang überschaubar.
Darüber hinaus wurden die Module für die Schulungen zum Forschungsdatenmanagement (FDM) inkl. Stresstest entwickelt und erfolgreich durchgeführt. Die Module sind so konzipiert, dass sie auch künftig – etwa bei der Einarbeitung neuen Bibliothekspersonals oder an anderen kleinen Hochschulen – einfach eingesetzt werden können.
Integrating Discipline-specific Know-How into Data Stewardship – DSembedded
Projektbeschreibung
Das Projekt zielte darauf ab, Data Stewardship an der ZHAW strategisch mittels Einbindung von fach- bzw. domänenspezifischem Expertenwissen weiterzuentwickeln. Ein Team an Forschenden aus unterschiedlichen Disziplinen und Departementen («Embedded Experts») unterstützte das zentrale Forschungsdaten Support Team (ZHAW Services Forschungsdaten, kurz ZSF) zu – während der Projektlaufzeit - jeweils 0.2 VZÄ pro Departement. Ihre Tätigkeiten gliederten sich in drei Aktionsfelder: 1) Hands-on Support; 2) Kommunikation und Förderung von Best Practices im Bereich Forschungsdatenmanagement sowie dem Publizieren von Daten in den Forschungscommunities; 3) Entwicklung von Guidelines und Hilfestellungen zu verschiedenen Stadien im Data Life Cycle. Ziel des Projekts war es, die Rolle der Embedded Experts nachhaltig an den Departementen verstetigen zu können. Damit sollten mittel- und langfristige Schnittstellen zwischen der ZSF und den Forschungscommunities aufgebaut werden, die einen fruchtbaren Informationsaustausch sowie, auf Basis eines breiten Pools an Expert:innen, massgeschneiderten Support ermöglichen.
Projektresultate
Aktivitäten in allen drei Projektzielen bzw. -pfeilern wurden durchgeführt (Informationskampgangen bzw. das Bewerben von ORD; fachspezifischer Support in FDM; sowie das Ausarbeiten von Guidelines, Prozessen, und Best Practices). Das übergreifende Ziel ein Netzwerk an FDM Expert:innen innerhalb der Forschungscommunities der Hochschule aufzubauen wurde erreicht. Die Zusammenarbeit zwischen den Embedded Experts und der ZSF hat eine gute Konjunktur angenommen. Ein zentraler Aspekt des Projekts war es, die Rollen der Embedded Experts an den Departementen zu verstetigen. Dies ist uns mehrheitlich mittels departementsinterner Finanzierung gelungen. Das Kern-Projektteam wird nach Projektablauf in ein Forschungsdatenpanel überführt, das quartalsweise tagt, und dabei aktuelle Problemstellungen diskutiert sowie einen Erfahrungsaustausch pflegt.
Eine Feststellung war, dass 0.2 VZÄ pro Departements, insbesondere bei den grösseren Departementen, bloss minimale Ressourcen darstellen, und die Wirkung entsprechend begrenzt war. Extensiver Support kann z.B. im Rahmen von 0.2 VZÄ kaum geleistet werden. Künftig werden die Rollen der personellen Schnittstellen an den Departementen daher insbesondere auf 3 Kernfunktionen reduziert:
1) Soundingboard, Feedback, und Usability Tests zu Services, die durch die ZSF entwickelt werden
2) Kommunikationsknotenpunkt: Informationen zu neuen FDM/ORD relevanten Entwicklungen in den Forschungscommunities an die Servicestelle herantragen bzw. umgekehrt in den Forschungscommunities streuen
3) Initialsupport: erste niederschwellige Support Leistung. Extensiver Support, der über 3 Stunden hinausgeht, muss künftig auf die Projekte ausgebucht werden.
WORDS: Wallis Open Research Data and Stewardship
Description du projet
L’objectif du projet “WORDS” était principalement double, à savoir établir une stratégie institutionnelle en matière d’ORD qui soit intégrée à la stratégie Open Science de la HEP-VS et établir le domaine R&I comme point de contact pour les questions touchant à la GDR. Pour ce faire, il a été envisagé dès le début de créer une commision interne ORD pour développer la stratégie et traiter des différents aspects liés à la GDR (juridiques, éthiques, techniques, informationnels) avec les experts internes et une bibliothécaire externe spécialiste en GDR. Le projet visait également à mener une étude des pratiques et besoins existants auprès des chercheur-euse-s et à développer de premiers éléments concrets de soutien pour les équipes de recherche comme un Data Management Plan (DMP) institutionnel. Ainsi, le projet WORDS avait pour but de mettre en oeuvre une offre de soutien jusqu’alors inexistante en matière de soutien à la GDR.
Résultats du projet
Les objectifs du projet ont été majoritairement atteints. Nous reprenons ici le contenu des différents Work Packages (WP) du plan de mesures pour mesurer l’écart avec les objectifs fixés.
Concernant la mise en œuvre du Data Stewardship: les objectifs sont majoritairement atteints. Le domaine R&I est à présent établi comme point de référence et de contact institutionnel en matière de GDR. Tant les journées professionnelles, les contacts établis et le travail de recherche ont permis une nette montée en compétences du bibliothécaire scientifique qui assume le rôle de Data Steward. La stratégie ORD institutionnelle est en voie de finalisation et reste à valider par la Direction de la HEP-VS. Les processus en lien avec le suivi qualité doivent encore être créés.
Concernant l’analyse de l'existant: cet objectif est majoritairement atteint. L’analyse de l’existant a été produite. Il reste à référencer les datasets existants auprès des membres des équipes de recherche.
Concernant l’accompagnement au DMP: cet objectif est majoritairement atteint. Un travail de recherche d’informations couplé à plusieurs entrevues avec des experts d’autres institutions a permis d’établir un modèle de DMP institutionnel. Il reste à le communiquer à l’ensemble des équipes de recherche, à mettre à leur disposition des ressources complémentaires et à en faire une promotion interne efficace.
Concernant l’information, la formation et la collaboration: cet objectif est majoritairement atteint. Plusieurs collaborations inter-institutionnelles (HES-SO, UNIL, notamment) ont été faites et des synergies trouvées. L'initiation au changement de culture et aux principes FAIR auprès des équipes de recherche reste à mener.
Massnahmenplan zum Aufbau von Data Stewardship an der Pädagogischen Hochschule Zug
Projektbeschreibung
Die Pädagogische Hochschule Zug hat bei swissuniversities im Rahmen des Programms Open Science, Phase B-ORD, für die Dauer von zwei Jahren (2023-2024) den Betrag von Fr. 38’215.- zum Aufbau der neuen Funktion «Data Steward» beantragt. Die PH Zug hatte bereits vor dem Beginn des Projektes mit Open Access erste Schritte in Richtung Open Science gemacht. Diese Entwicklung wurde im Rahmen der zweijährigen Projektarbeit mit der Einrichtung der neuen Funktion «Data Stewardship» konsolidiert und weitergeführt. In Anlehnung an die ORD-Strategie von swissuniversities wurden die folgenden drei Teilziele verfolgt:
- Einführung der Funktion “Data Stewardship” zur Unterstützung der Forschenden bei der Konzeption und Umsetzung von ORD-Praktiken (Ziel A).
- Entwicklung, Förderung und Erhaltung von finanziell nachhaltigen Basis-Infrastrukturen und -Dienstleistungen für die Forschenden (Ziel B).
- Ausstattung der Forschenden im Hinblick auf ORD: Beratung, Kompetenzentwicklung und Austausch von Best Practices (Ziel C).
Im Rahmen der zweijährigen Projektphase wurden diese Teilziele auf unterschiedlichen Ebenen bearbeitet und umgesetzt, damit sich ORD an der PH Zug langfristig und nachhaltig als Teil der Forschungspraxis etablieren kann. Das Projekt wurde von einem Team aus drei Personen durchgeführt, das sich aus Vertreter/-innen verschiedener Bereiche zusammensetzt (Mediothek und ICT, Weiterbildung, Dienstleistung und Beratung, Forschung & Entwicklung). Die aus dem Projekt gewonnen Erfahrungen, die etablierte Infrastruktur und das Knowhow stehen den Forschenden der PH Zug auch nach der Beendigung des Projekts weiterhin zur Verfügung. Die im Projektantrag beschriebene Langfristigkeit ist somit gewährleistet.
Projektresultate
Auszug aus dem Bericht 2023:
Der Projektstand Ende 2023 entspricht in weiten Teilen der Planung. Mit der neu aufgeschalteten Webseite und mit ersten internen Beratungen und Schulungen konnte das neu geschaffene Angebot hochschulintern sichtbar gemacht werden. Es wurden rechtliche Abklärungen getroffen zur Verwendung von persönlichen Daten, Datensicherheit, Einverständniserklärungen etc. Bezüglich der technischen und infrastrukturellen Entscheidungen sind Gespräche mit der ICT geführt worden. Das Projektteam entschied in Absprache mit der Hochschulleitung, kein eigenes Datenrepositorium aufzubauen. Dies nicht nur aus Kostengründen, sondern auch aufgrund der beschränkten Anzahl an Projekten mit geeigneten Datensätzen. Ausserdem ist auf einem professionellen Datenrepositorium (z.B. SWISSUbase oder Zenodo) die Datenkuration langfristig gewährleistet.
Zur hochschulübergreifenden Koordination wurden im Austausch mit anderen Hochschulen (BFH, FHNW, HfH, HSLU, PHLU, PHZH) Arbeitsgruppen gebildet, die sich mit der Ausbildung der Forschenden im Zusammenhang mit ORD-Praktiken befassten und ein Anforderungsprofil von Datastewards erstellten. Die gemeinsam konzipierten Kurzschulungen werden regelmässig zu verschiedenen thematischen Schwerpunkten seit Januar 2024 durchgeführt. Der Einsitz in verschiedenen schweizweiten Gremien (Akord, Soundingboard von swissuniversities, SRDSN) ermöglicht es der Projektgruppe, die lokalen Herausforderungen und Bedürfnisse mit den nationalen Vorgaben und Lösungsansätzen zu koordinieren.
Eine Herausforderung des ersten Projektjahres bestand darin, die verschiedenen Dimensionen von ORD (technische, institutionelle, regulatorische, ethische und rechtliche) auf die Möglichkeiten und Bedürfnisse der Institution abzustimmen. Die dynamischen Entwicklungen einzelner ORD-Aspekte (vgl. z.B. der kantonal verschiedene urheberrechtliche Status von (Personen-)Daten) hat zusätzliche Abklärungen erfordert.
Berichtsjahr 2024:
Auf der Basis der Vorarbeiten des ersten Projektjahres wurden die verschiedenen Teilbereiche des Projektplans weiterbearbeitet. Die Erarbeitung der ORD-Policy wurde im zweiten Projektjahr finalisiert. Die Verabschiedung durch die Hochschulleitung ist noch ausstehend. Zu den wichtigen Arbeiten, die fortgeführt wurden, gehört auch die Etablierung eines Open-Science-Fonds: Der zuvor bereits existierende Open-Access-Fonds wurde um die Dimension ORD erweitert. Neu ist es möglich, für ORD-bezogene Aktivitäten (z.B. Anonymisierung von Daten) Gelder zu beatragen. Die Anträge werden vom Data Steward geprüft und die Gelder gesprochen, wenn sie den Vergabebedingungen entsprechen. Dazu mussten Regelungen angepasst und von der Hochschulleitung genehmigt werden. Wegleitungen wurden aktualisiert und Prozesse etabliert. Des Weiteren galt es auch Lösungen für Antragsformulare und Ablagestrukturen zu finden. Nachdem darüber hinaus auch die Homepage angepasst worden war, konnten erste Anträge entgegengenommen werden. Dass sich die Bemühungen rund um den Open-Science-Fonds zu etablieren begannen, war daran ersichtlich, dass Anträge aus verschiedenen Forschungsprojekten eingereicht wurden und bewilligt werden konnten. Dem Projektteam war es ein Anliegen, bei der Erarbeitung von Handreichungen (Ethikhandreichung, Nutzung von Repositorien etc.) die Zielgruppe(n) in angemessener Form miteinzubeziehen.
Parallel zu den oben erwähnten Tätigkeiten investierte das Projektteam Ressourcen in die Kommunikation und Sichtbarkeit der Projektziele, indem auf hochschulinterne und (inter)nationale Tätigkeiten aufmerksam gemacht wurde. Um nicht nur auf ORD-Anliegen hinzuweisen, sondern auch ein entsprechendes Bewusstsein zu fördern, wurden Anstrengungen unternommen, um im direkten Austausch (z.B. anlässlich der Bereichskonferenz F&E) auf Fragen Bezug nehmen zu können, die sich bei Forschenden im Zusammenhang mit ORD stell(t)en. Das Angebot individueller Beratungen wurde mehrfach wahrgenommen und als hilfreich eingestuft.
Das Projektteam nahm an nationalen und internationalen Veranstaltungen zum Thema ORD teil und bildete sich in diesem Themenbereich weiter. Unter den genutzten Angeboten, die von diversen Hochschulen angeboten werden, finden sich zahlreiche Kurzschulungen (zumeist online), aber auch mehrtägige Weiterbildung.
Implementierung von Open Research Data an der PH Zürich
Projektbeschreibung
Die PH Zürich unterstützt Open Science und setzt sich für die Professionalisierung des Forschungsdatenmanagements und die Verankerung von Open Research Data (ORD) an der Hochschule ein.
An der PH Zürich sind Massnahmen geplant, deren Umsetzung darauf abzielen, (1) zentrale rechtliche, ethische und archivarische Fragen im Umgang mit Forschungs(meta)daten und deren Publikation zu klären, (2) Best Practices im Forschungsdatenmanagement zu etablieren und in bestehende Prozesse des Projektmanagements zu integrieren sowie (3) umfassende Supportleistungen und Infrastrukturen in den Bereichen Forschungsdatenmanagement und ORD einzuführen.
Zu den Massnahmen gehören die Entwicklung einer ORD-Policy (1a), Überprüfung von Reglementarien und Prozesse (1b), Definition von Standards für Forschungs(meta)daten (1c), Entwicklung und Einführung eines internen Datenmanagementplans (2a), Konsolidierung von Forschungsdaten bei Projektabschluss (2b), Monitoring und Sichtbarmachung (2c), sowie die Einrichtung einer Koordinations- und Beratungsstelle (3a) und die Etablierung von Standardinstrumenten (3b) für Fragen des Forschungsdatenmanagements und des offenen Datenzugangs. Ausserdem findet ein regelmässiger Austausch mit den Data Stewards anderer Hochschulen statt.
Projektresultate
Die gesetzten Projektziele und die daraus resultierenden Massnahmen wurden in der zurückliegenden sowie in der gesamten Projektphase weitestgehend erfolgreich realisiert – auch wenn in der letzten Periode die personellen Ressourcen nicht wie geplant ausgeschöpft werden konnten.
Die ORD-Policy (1a) wurde am 08.05.2024 durch die Hochschulleitung beschlossen und ist seitdem in Kraft. Die Policy wurde gemeinsam mit den Forschenden, den zuständigen Ressorts und unter der Berücksichtigung von Reglementarien und Prozessen (1b) erarbeitet. Sie zeigt die Grundsätze und Empfehlungen für die Umsetzung von ORD an der PH Zürich.
Zur Etablierung eines qualitätsgerechten Forschungsdatenmanagements wurden handlungsleitende Handreichungen (1c & 3b) für die Forschenden erarbeitet. Diese basieren auf einer internen Befragung der Forschenden zur Art und zum Umgang mit Forschungsdaten zu Projektbeginn (1c). Diese Handreichungen wurden in ein neu geschaffenes internes Open Science Portal (2c, 3a & 3b) integriert und stehen den Forschenden seit dem Sommer 2024 zur Verfügung. Das Portal wird fortlaufend auf Aktualität geprüft und um neue Inhalte ergänzt.
Darüber hinaus wurden neben einer Beratungsstelle regelmässige Workshops zu ORD-Themen als Unterstützungsleistungen für die Forschenden angeboten (3a & 3b).
Im Jahr 2024 bis Projektende konnte unter Einbezug von Forschenden die Verfassung eines Merkblatts «Datenmanagement PHZH» und die Erstellung eines internen Datenmanagementplans (2a & 2b) umgesetzt werden. Zentral in der Umsetzung war der regelmässige Austausch mit den Forschenden, um die fachspezifischen Bedürfnisse einfliessen zu lassen. So konnte bereits zu Projektbeginn eine erste Sensibilisierung für die Thematik stattfinden. Für eine nachhaltige Umsetzung der Massnahmen wird jedoch ein längerer Zeithorizont benötigt wird, der über die Projektdauer hinausgeht.
Massnahmenplan der Eidgenössischen Hochschule für Sport Magglingen im Bereich Data Stewardship
Projektbeschreibung
Projektziele:
- Erstellung von Leitfaden für Forschende mit konkreten Anleitungen
- Weiterbildung von 50% Forschenden zum Thema Open Research Data
- Begleitung und Unterstützung von Forschenden
Projektinhalte:
- Interne Workshops mit Forschenden zum Thema ORD
- Austausch mit Rechtsdienst zum Thema «Umgang mit personenbezogenen und sensiblen Daten»
- Verfassen des Leitfadens
- Teilnahme an von swissuniversities organisierten Workshops¨
Projektresultate
- Erstellung von einem Leitfaden für Forschende mit konkreten Anleitungen: Im Sinne der Anstellung eines Data Stewards wurde ein Mitarbeitende für die Entwicklung des Projekts engagiert. Der Leitfaden wurde erstellt und kommuniziert.
- Weiterbildung von 50% Forschenden zum Thema ORD: Durch die internen Workshops und der Wissenstransfer in die Ressorts der EHSM (z.B. durch die Arbeitsgruppe F&E) wurde das Bewusstsein bei einer grossen Anzahl der Forschenden an der EHSM für ORD geschärft. Konkrete weitere Schulungen (z.B. Micro-credits, oder e-learning) wurden nicht vorgenom-men. Diese Situation ist damit verbunden, dass die Aufgaben und Tätigkeiten des Prorekto-rats F&E inkl. Prorektor und Arbeitsgruppe F&E, in Diskussion sind. Es ist ein Auftrag für das Prorektorat F&E das Thema Data Policy weiterzuentwickeln und die Ergebnisse des Projektes zu integrieren.
- Begleitung und Unterstützung von Forschenden: Durch die Fertigstellung des Leitfadens steht ein Dokument zur Verfügung, welches Forschende in Zukunft beim Umgang mit Forschungsdaten unterstützt. Es wurde mit RedCap ein Tool implementiert, welches Forschende beim Datenmanagement unterstützt. Eine spezifische Anlaufstelle (beispielsweise für konkrete Unterstützung bei Bedarf) wurde nicht gewährleistet. Diese Situation ist damit verbunden, dass die Aufgaben und Tätigkeiten des Prorektorats F&E inkl. Prorektor und Arbeitsgruppe F&E, in Diskussion sind. Es ist ein Auftrag für das Prorektorat F&E das Thema Data Policy weiterzu-entwickeln und die Ergebnisse des Projektes zu integrieren.
Allgemein war es durch personelle Änderungen während die Projektperiode, insbesondere an Schlüsselpositionen im Bereich F&E der EHSM (Prorektor und Ressortleiter) eine Herausforderung Entscheide auf strategischer Ebene zu treffen. Dies wiederrum schränkte den Handlungsspielraum auf operativer Ebene ein.
Massnahmenplan zur Implementierung von Data Stewardship an der Interkantonalen Hochschule für Heilpädagogik
Projektbeschreibung
Das Projekt «Data Stewardship an kleinen und mittelgrossen Pädagogischen Hochschulen» mit dem Leading House der HfH umfasst mehrere Einzelprojekte, in denen jeweils spezifische Massnahmenpläne für die beteiligten Hochschulen HfH, EHB, PHSG, PHSZ und PHTG definiert wurden. Das Gesamtprojekt geht die Herausforderung an, einen professionellen Support – sogenannte Data Stewards – für Open Research Data (ORD) aufzubauen. Kleine bis mittelgrosse Hochschulen sind einerseits ähnlich bezüglich ihres Fortschritts in diesem Aufbau sowie bezüglich ihrer thematischen und methodischen Spezifitäten. Andererseits unterscheiden sich ihre organisationalen Strukturen teils beträchtlich. Mithilfe von Projekttreffen und Workshops der beteiligten Hochschulen werden spezifische Herausforderungen (z.B. organisationale Einbettung von Data Stewardship in den Hochschulen, konkrete Umsetzung der FAIR-Prinzipien, Forschungsethik, Nachnutzung von Forschungsdaten) thematisiert und gemeinsame Lösungen erarbeitet. Ein weiteres Ziel dieser Kooperation ist die Förderung der Vernetzung und nachhaltige Zusammenarbeit bezüglich Data Stewardship und ORD. In dem Rahmen wurden die Massnahmenpläne der einzelne Hochschulen umgesetzt.
Projektresultate
Um die inhaltlichen Ziele zu erreichen, wurde im Gesamtprojekt geplant, dass es regelmässige Projekttreffen und insgesamt 4 Workshops geben soll. Diese Treffen und die Workshops konnten wie geplant stattfinden und für einen produktiven und konstruktiven Austausch genutzt werden. Diese Zusammenarbeit trug massgeblich dazu bei, dass die einzelnen beteiligten Hochschulen ihre jeweiligen Massnahmenpläne konsequent bearbeiten und wechselseitig voneinander lernen konnten. Besonders erfreulich war, dass alle 4 Workshops (2x im Jahr 2023 und 2x im Jahr 2024) wie geplant durchgeführt werden konnten und auf breites Interesse über die beteiligten Hochschulen hinaus stiessen. Die Workshops wurden in der Kommission F+E der PH durch die Projektleitung für sämtliche PH bekannt gemacht. Damit wurde erreicht, dass jeweils auch Forschende und Data Stewardships von weiteren PH teilnahmen, wodurch sich der formelle Austausch während der Workshops sowie der informelle Austausch in anschliessenden Apéros sehr produktiv gestaltete und sich Data Stewards vernetzen konnten.
Die Massnahmenpläne der einzelnen Hochschulen (HfH, PHSZ, PHTG, EHB und PHSG) konnten vorgesehen durchgeführt werden (genauer unten beim Inhalt dargestellt). Es haben sich keine neuen Herausforderungen ergeben. Alle Projektziele konnten angegangen und erreicht werden. Eine Veränderung im Budget war nicht notwendig. An einzelne Hochschulen (HfH) werden einzelne Massnahmen im Jahr 2025 und 2026 noch vertiefter umgesetzt (z.B. ORD in der Ausbildung).
Plan de mesures Data Stewardship
Description du projet
Le plan de mesure Data Stewardship vise la mise en place des data stewards au sein de l’Université (Leading House) et de la Haute école pédagogique de Fribourg comme premier niveau de soutien dans le domaine de la gestion des données de la recherche (GDR). En même temps, il va permettre la mise en réseau des services existants dans ce domaine au sein des deux institutions et mettre en place une coordination entre les différents acteurs concernés (data stewards et services existants). Avant la mise en place de cette nouvelle structure, le projet définira les compétences et connaissances des data stewards et développera un concept de formation modulaire et des cahiers des charges pour les bibliothécaires scientifiques qui assumeront ces nouvelles tâches.
Résultats du projet
Les objectifs du projet ont été globalement atteints. Le retard dans la formation des Data Stewards pris en 2023 a pu être rattrapé sans problème en 2024. La mise en réseau des services existants a pu être réalisé seulement en partie pendant la duré du projet. Ceci était dû au fait qu’il était difficile à identifier tous les services des deux hautes écoles qui sont impliqués par la thématique. La leçon de ce constat est que la mise en réseau des services existants doit aussi être interprété par un processus continue comme le mot anglais «networking» l’expresse très bien.
Plan d’action Data Stewardship pour l’Université de Genève – Data Stewardship @ UNIGE
Description du projet
Le projet de Data Stewardship de l'Université de Genève vise à promouvoir une gestion responsable et ouverte des données de recherche. Il s'articule autour de quatre axes principaux: renforcer la coordination autour de la gestion des données FAIR (Findable, Accessible, Interoperable, Reusable); soutenir les chercheurs-euses dans la gestion et l'ouverture de leurs données; renforcer et diversifier l'offre de formations sur des sujets émergents; et créer des communautés de pratiques autour de la gestion de données FAIR. Ce plan d'action vise à promovoir un changement culturel dans la conduite de la recherche scientifique, en encourageant l'accès aux données brutes et la réutilisation des données selon les principes FAIR. La mise en œuvre de ce plan implique une approche transversale, intégrant diverses entités de l'université, et est conçue pour s'aligner avec la vision de la science ouverte soutenue par swissunivesities.
Résultats du projet
Le démarrage a été retardé, car la première cheffe de projet a rencontré des problèmes de santé avant de démissionner en mars 2024. Les objectifs ont alors été revus selon six axes de travail qui ont été développés durant les 18 mois suivants:
- Établir une gouvernance interne;
- Organiser des réunions thématiques réunissant les différentes entités offrant des services ORD (Open Research Data) visant à enrichir et à mettre à jour le portail institutionnel www.unige.ch/researchdata;
- Analyser les besoins des chercheurs-euses pour élaborer des recommandations institutionnelles;
- Organiser des événements et une liste de diffusion faisant office de canal de communication à la communauté ORD;
- Pérenniser les actions menées durant le projet;
- Participer à la conception du CAS DataStewardship mis en place par l’UNIL (SwissDS-ENV)
Les fonds alloués par swissuniversities n’ont pas été intégralement employés. Ils auraient pu servir à former et à engager des «Data Consultants» ou des «Data Champions». Cela n’a pas été possible par manque de temps, car il aurait fallu trouver des profils intéressés, les sensibiliser à la GDR (Gestion des données de recherche) et à l’ORD, les former et les soutenir dans leurs actions
Bien que le Data Stewardship ait une place au sein de la stratégie numérique institutionnelle pour 2025-2028, les principaux défis restent le développement de nouvelles actions et la mise à jour continue du portail institutionnel, assurés pour l’instant par le plan d’action soumis et accepté dans la phase II du projet pour la prochaine période 2025-2026.
Swiss Data Stewardship Environment: Profile - Training - Network (SwissDS-ENV)
Description du projet
Leading House de SwissDS-ENV, l’UNIL, via son Service des Ressources Informationnelles et Archives (UNIRIS), s’est associée à 7 autres partenaires académiques pour développer un CAS en Data Stewardship. Cette formation certifiante doit permettre une meilleure reconnaissance du profil des Data Steward tout en renforçant leurs compétences et en offrant de nouvelles opportunités de carrière dans le milieu de la recherche scientifique académique. Elle permettra aussi de fédérer une communauté de praticien·ne·s dans le milieu académique au niveau suisse.
Pour ce faire, les objectifs principaux du projet étaient de:
• Définir le profil Data Steward dans le contexte de la communauté scientifique suisse
• Identifier ses compétences et aptitudes clés
• Spécifier la formation pour répondre au mieux aux enjeux et aux besoins identifiés
• Concevoir, développer et mettre en place la formation
• Formaliser et coordonner un réseau de futur·e·s et actuel·le·s Data Stewards, ainsi que de
professionnel·le·s (y compris enseignant·e·s) en Data Stewardship
• Assurer la pérennité du réseau
Le CAS est développé par des hautes écoles pour les membres des hautes écoles. Il n'est, par conséquent, pas en concurrence avec des offres privées, conformément à l’article 9 sur la concurrence de la Loi fédérale sur la formation continue.
Résultats du projet
Après la réalisation des objectifs de l’action 1 en 2023, les objectifs de l’action 2: conception et production du CAS, dont la réalisation a été initiée en 2023, ont été complètement atteints en 2024. L’ensemble du matériel de cours: supports de cours, activités préparatoires et post-leçon, travaux de fins de modules spécialisés, a été développé et mis en place sur la plateforme dédiée Moodle. Les aspects administratifs (règlement d’études, plan d’études, budget, rattachement officiel du CAS à la faculté SSP de l’UNIL, procédures de défraiement et de rémunération pour les intervenant·e·s) ont été finalisés.
La première édition du CAS s’est ouverte en octobre 2024 et se termine en juillet 2025. Elle a accueilli seize participant·e·s, pour la plupart affilié·e·s à une institution partenaire du projet. Elle a permis de tester certaines procédures ou façons de faire sur différents aspects, afin de retenir les plus adaptées pour les prochaines éditions: par exemple la quantité de travail personnel demandé; la répartition des activités avant la leçon, pendant, après; les modalités d’évaluation des participant·e·s; ou encore la méthode de collecte des retours des participant·e·s sur cette édition.
Aktionslinie B5.3: Netzwerk für Data Stewardship
Im Rahmen der Aktionslinie B5.3 konnten interessierte Hochschulen Projektvorschläge zur Förderung von Data Stewardship und zur Etablierung eines entsprechenden Netzwerks in der Schweizer Hochschullandschaft einreichen. Das Projekt zielte darauf ab, ein Netzwerk aufzubauen, das den interinstitutionellen Austausch fördert, Kooperationen anstösst und auf die Bedürfnisse verschiedener Institutionen eingeht. Das Netzwerk sollte zudem als Ansprechpartner für Fragen zu Data Stewardship dienen und die internationale Anschlussfähigkeit gewährleisten.
SRDSN: Swiss Research Data Support Network
Projektbeschreibung
Das Projekt wurde von 31 Partnerinstitutionen getragen und von der Universität Bern als Leading House gemeinsam mit der Universität Basel geleitet. Das Ziel war der Aufbau und die Etablierung einer schweizweiten, möglichst inklusiven, Community für den Forschungsdatenmanagement-Support (FDM-Support), an der alle öffentlichen Hochschul- und Forschungsinstitutionen teilnehmen können. Das Swiss Research Data Support Network (SRDSN) soll die Zusammenarbeit, den Wissensaustausch und die Entwicklung von Best Practices des FDM-Supports zwischen den relevanten Einrichtungen wie Bibliotheken, IT, Forschungsdiensten und Verwaltung fördern. Dafür wurde eine Netzwerkstruktur mit Operational Committee, Steering Committee und einem international besetzten Sounding Board geschaffen. Eine Governance mit Ethikkodex, Mitgliedschaftsregeln und einem Memorandum of Understanding wurde erarbeitet und mit dem Sounding Board abgestimmt. Zur Sichtbarkeit und Zusammenarbeit wurden eine Website sowie ein digitaler Arbeitsbereich eingerichtet. Das Netzwerk trifft sich zweimal jährlich. Zudem entstanden zwei spezialisierte Nodes für Data-Stewardship-Koordinator:innen und den Umgang mit sensitiven Daten.
Projektresultate
Das Projekt verfolgte mehrere Ziele: Es sollte ein inklusives Netzwerk für die Professionalisierung und Zusammenarbeit der FDM-Support-Stellen der gesamten Schweiz geschaffen werden. Dafür wurde im Projekt eine Organisations- und Koordinationsstruktur geschaffen, die ein Steering Committee für strategische Fragen, ein Organisationskomitee für Webseite, Veranstaltungen und Mitgliederverwaltung, ein Sounding Board für Feedback und Nodes für spezielle Themen umfasst. Für die Zusammenarbeit wurden eine Governancestruktur, ein Memorandum of Understanding, Mitgliederbestimmungen sowie ein Code of Conduct verabschiedet.
Für Sichtbarkeit und zur Kommunikation wurde eine Webseite https://researchdatasupport.ch und ein Kommunikationsplan erstellt. Neben der Veröffentlichung von Neuigkeiten und Veranstaltungshinweisen, fördert die Webseite die Teilnahme an Trainings. Für die interne Zusammenarbeit wurden nach Evaluation Google Drive, Switch Drive und Matrix/Element gewählt. Für Veröffentlichungen wurde eine Zenodo-Community eingerichtet: https://zenodo.org/communities/srdsn.
Während der Projektlaufzeit fanden vier ganztägige Veranstaltungen für die gesamte Community und internationale Gäste statt. Zudem wurden zwei thematisch spezialisierte Nodes aufgebaut: Der Node „Data Stewardship Coordination“ zählt 44 Mitglieder und organisierte vier Meetings und Workshops zu Erfahrungen und Best Practices institutioneller Data-Stewardship-Programme. Ende 2024 wurde ein Node zum Thema „Personal and Sensitive Data“ gegründet (47 Mitglieder).
Zur Einbettung in den internationalen Kontext wurde eine Analyse von RDM-Initiativen erstellt (https://zenodo.org/records/15712229). Kontakte zu anderen Netzwerken wurden aufgebaut und SRN, RDA und das Data-Steward-Network Belgien wurden zu Treffen eingeladen. Mitglieder dieser und weiterer Initiativen (u.a. CLARIN-CH, SPHN, SRN, SAGW, das niederländische Open-Science-Programm sowie swissuniversities) stellten das erste Sounding Board.
Im Verlauf des Projekts gab es keine inhaltlichen Verschiebungen der Ziele. Aufgrund von Abhängigkeiten kam es zu Verzögerungen bei der Umsetzung der Webseite. Die Registrierung von Mitgliedern über die Webseite konnte erst nach Projektende im Juli 2025 freigeschaltet werden.
Aktionslinie C1.3: Mobilisierung und Erleichterung der Teilnahme an relevanten internationalen Initiativen
Das Ziel von Aktionslinie C1.3 war es, eine angemessene Vertretung Schweizer Forschender in internationalen Foren und Initiativen zu gewährleisten. Der Aufruf zur Einreichung von Projekteingaben richtete sich an beitragsberechtigte Schweizer Hochschulen, Hochschulinstitutionen und Initativen und zielte darauf ab, deren Teilnahme an relevanten europäischen und internationalen Initiativen durch die Finanzierung von Mitgliedsbeiträgen zu ermöglichen.
Projekt Swiss Associated EGI Membership
Project Description
Since 2010, the association EnhanceR (www.enhancer.ch), including its predecessor association SwiNG, provides the Swiss Membership in EGI (egi.eu) for the research IT community and its users.
The EGI federates services connecting research data and computing resources across Europe. The services are part of the EOSC. EnhanceR is the Swiss legal entity which represents the Swiss re-search and service providers in EGI. It is thus responsible for providing the annual fee (27’500 EUR for associate membership, the double for regular membership). In order to provide a domain neutral membership, EnhanceR facilitates federal support for the related expenses.
On behalf of EnhanceR, its member the University of Bern has been the leading house in the project.
Project Results
The EGI participation enables Swiss researchers access to EGI/EOSC services and the possibility to integrate own services in the federation. For example, the Swiss high-energy physics community has four computing centres (PSI, CSCS, UNIBE LHEP, UNIBE ID) in this federation. This enables them to share data and computing resources with hundreds of other centres engaged in the CERN research activities. The EGI impact report 2023 for Switzerland is attached.
The project objective, i.e. ensure the associated membership in EGI for 2023 and 2024, was met. However, due to the lack of funding, EnhanceR had to terminate its EGI membership for 2025.
Aktionslinie C2.1: Entwicklung von good practices in der Aus- und Weiterbildung von Forschenden im Bereich Forschungsdatenmanagement
Die Aktionslinie C2.1 zielte darauf ab, "good practices" für RDM-Schulungen an Schweizer Hochschulen zu entwickeln. In den Prozess der Entwicklung mussten Forschungsgemeinschaften und andere relevante Akteure im Bereich RDM einbezogen werden.
ROADS: Reusing Openly Accessible research Data for Student theses

Project Description
In recent years, researchers have been increasingly encouraged to share their data, as it can be potentially reused in new contexts. This project explored whether (openly) available datasets are indeed reusable and what data reusability means in practice. To evaluate this, the project adopted an approach in which students at Bachelor’s, Master’s, and PhD levels reused existing datasets in various assignments (e.g., theses, term papers) across disciplines. The process of data reuse was supervised by researchers and lecturers, with additional support from data stewards – all affiliated with ZHAW. In doing so, the project aimed not only to investigate the practical reusability of data, but also to teach students how to reuse data effectively.
Project Results
The project's findings revealed skills gaps in two key areas related to handling available data: the ability to search for datasets and the competence to evaluate data quality. At the same time, the quality of available data was often found to be insufficient, e.g. due to a lack of detailed documentation. These challenges led to the conclusion that data reusability depends on both the quality of the data and the skills of the user: Even when publicly accessible datasets meet quality criteria (e.g., being well-documented and are technically findable), they may still be unusable without essential skills, such as knowing how and where to search for suitable data. The project insights are delivered as tangible outcomes, including a checklist for evaluating data quality and recommendations for reusing data in student assignments.
Aktionslinie C2.2: FDM-Ausbildung in Lehrplänen
Die im Rahmen dieser Aufforderung eingereichten Projekte mussten darauf abzielen, einen Modelllehrplan für eine bestimmte Disziplin zu entwickeln, der Forschungsdatenmanagement (FDM) in die Ausbildung von Doktorierenden und Nachwuchswissenschaftler:innen einbezieht. Bevorzugt wurden Konzepte, die ein hohes Potenzial für die Anwendung an anderen Institutionen und in anderen Disziplinen aufweisen. Gegebenenfalls sollten die Projektvorschläge die verschiedenen Hochschultypen und andere relevante Akteure im Bereich des FDM einbeziehen.
RDM curriculum Campus Luzern
Projektbeschreibung
Im Rahmen des Projekts „RDM-Campus Luzern“ haben sich die Universität Luzern, die Hochschule Luzern (HSLU) und die Pädagogische Hochschule Luzern (PHLU) zusammengeschlossen, um ein gemeinsames Curriculum für Forschungsdatenmanagement (RDM) zu entwickeln. Ziel war es, den wachsenden Bedarf an praxisnahen Weiterbildungsangeboten im Bereich Open Research Data (ORD) zu adressieren und ein breites, niederschwelliges Qualifizierungsangebot für Forschende aller Disziplinen zu schaffen.
Das Curriculum basiert auf einem modularen Aufbau und deckt zentrale Aspekte des RDM ab, darunter Datenmanagementpläne, rechtliche Fragen, Datenpublikation und Archivierung. Die Veranstaltungen wurden in verschiedenen Formaten angeboten (online, hybrid, Präsenz) und auf unterschiedliche Zielgruppen (Doktorierende, Postdocs, Projektleitende) zugeschnitten. Die enge Zusammenarbeit der drei Luzerner Hochschulen ermöglichte einen Wissenstransfer über institutionelle Grenzen hinweg und förderte eine abgestimmte regionale RDM-Kultur.
Projektresultate
Die Pilotierung des Curriculums im Studienjahr 2023/24 war ein voller Erfolg: Mehr als 90 Forschende nahmen teil. Die Rückmeldungen waren durchwegs positiv und unterstrichen die Relevanz und Aktualität des Angebots. Besonders geschätzt wurden der praxisorientierte Zugang, die Vernetzungsmöglichkeiten und die sofortige Anwendbarkeit des Gelernten im eigenen Forschungsalltag.
Das Curriculum wird weiterhin gemeinsam getragen und in die regulären Weiterbildungsangebote integriert. Damit trägt das Projekt nachhaltig zur Verankerung von RDM-Kompetenzen bei und stellt ein Beispiel guter Praxis für andere Standorte dar. Zudem leistet es einen Beitrag zur strategischen Umsetzung von Open Science an den beteiligten Hochschulen.
RDM@SSM: Research Data Management @ Summer School in Social Science Methods
Project Description
The project, "Research Data Management @ Summer School in Social Science Methods (RDM@SSM)," was led by the Università della Svizzera italiana (USI; Leading House) with support of the Swiss Centre of Expertise in the Social Sciences (FORS) and two independent experts. Its primary objective was to develop a curriculum for Research Data Management (RDM) and Open Science (OS) training for social scientists, utilising the tested pedagogical model of the Summer School in Social Science Methods (SSM) to create a tailored offer for PhD and junior researchers in social sciences. This curriculum was successfully integrated into the SSM to allow for testing and ensure its sustainability for Swiss and international social scientists. The project content involved designing modules, creating interactive e-learning materials, conducting pilot courses online in August 2024 and in-person in November 2024, and refining the curriculum based on feedback to ensure its long-term sustainability and broader dissemination to other Swiss Higher Education Institutions.
Project Results
The RDM@SSM project largely achieved its objectives over the past year. A comprehensive curriculum for RDM and OS training, tailored for social scientists, was successfully developed. This involved a robust methodology including a literature review, landscape analysis of existing offerings, a survey of PhD students and early career researchers (89 responses), and 12 interviews with PhD supervisors across Europe.
The curriculum was iteratively refined and tested twice: initially online in August 2024, and then in-person with a larger cohort in November 2024, leveraging the Summer School's pedagogical model. This second testing pushed the project timeline, leading to a no-cost extension until the end of June 2025. This extension allowed for the finalisation of all outputs and the holding of a promotional event in June 2025. This event was conducted online for accessibility and to save funds, with the slides subsequently shared as an open-access resource. This integration into the SSM has ensured the long-term sustainability of the offer for Swiss and international social scientists, with the course now permanently integrated into the SSM's annual offerings. All curriculum and teaching materials, along with the report on the literature and landscape reviews and the needs assessment, have been published open access.
Aktionslinie C2.3: Rahmen für die systematische Kommunikation zwischen Ausbildenden und Datenverwaltenden zur Erleichterung Professionalisierung und des Austauschs
Aktionslinie C2.3, "Framework for systematic communication between trainers and data stewards to facilitate professionalisation and the exchange of experiences, best practices, needs, and to develop training modules", plante die Durchführung einer Lückenanalyse zum Status quo der RDM-Ausbildung und der Kommunikation zwischen Ausbildenden in der Schweiz.
Framework for systematic communication between trainers and data stewards to facilitate professionalisation and the exchange of experiences, best practices, needs, and to develop training modules
Project Description
Mandate C2.3 was assigned by swissuniversities in the late summer of 2024 to Università della Svizzera italiana, which led the project in collaboration with FORS and ZHAW.
The objective of the mandate was to monitor the state of communication practices between RDM support staff (typically Data Stewards and analogous figures) and RDM trainers, by mapping the current situation at both the Swiss and international levels, identifying gaps and needs, and proposing potential forward-looking solutions.
The deliverable required by the Mandate was a final report, which was submitted to the OS delegation of swissuniversities on June 30, 2025.
At the same time, two other mandates were assigned to the Leading Houses at the University of Bern (Mandate B5.1) and the University of Basel (Mandate B5.4), respectively. The work carried out under the three mandates involved close collaboration between the three Leading Houses.
Project Results
The main project objectives set in the Mandate contract were reached thanks to the thorough team work as well as the collaboration with Mandates B5.1 and B5.4.
The major Mandate objectives were:
- analysis of the existing Swiss, European and international reports and surveys dealing with the roles and principles for communication between RDM trainers and data stewards;
- analysis of the current state of communication between RDM trainers and data stewards (where, how, by whom and to whom) and the role of existing networks as well as the intra-institutional relations;
- target and gap analysis, potential future implementation measures
The biggest challenge was to organize and conduct the Focus Group interviews: the setting that the Three Mandates agreed upon was a balance between the intention to collect meaningful data from a panel of Swiss HEI representatives and the necessity not to stress out interview participants with an overextended event.
Aktionslinie D1.3: Anreize und Belohnungen
Als Schritt zur Förderung und Belohnung von ORD-Praktiken konnten interessierte Hochschuleinrichtungen einen Projektvorschlag zur Förderung des interinstitutionellen Austauschs und der Verbreitung best practices für die Berücksichtigung von ORD-Praktiken bei Einstellungs- und Karriereentwicklungsprozessen einreichen.
recORD
Projektbeschreibung
Das Projekt recORD hatte zum Ziel, die Anerkennung von Beiträgen zu Open Research Data weiterzuentwickeln und über die Mitglieder des Projektkonsortiums hinweg zu koordinieren. Dazu wurde die Anerkennung von ORD-Beiträgen auf drei unterschiedlichen Ebenen vom Konsortium weiterentwickelt: 1. bei der Beurteilung von Forschungsanträgen, 2. beim Karriere-Assessment und 3. Bei der institutionellen Akkreditierung von Hochschulen. Die Zürcher Hochschule der Angewandten Wissenschaften (ZHAW) war das Leading House dieses Projekts.
Projektresultate
Das recORD Konsortium hat sein Arbeitsprogramm wie im bewilligtem Projektantrag spezifiziert durchgeführt:
- Die Literaturstudie zu bestehenden Frameworks für die Anerkennung von ORD-Beiträgen wurde rechtzeitig erstellt.
- Die Landschaftsanalyse zu den Herausforderungen und Ausgangslagen der einzelnen Schweizer Hochschulen wurde rechtzeitig erstellt.
- Die hochschulinterne Vorbereitung auf die 3 nationalen Workshops hat rechtzeitig stattgefunden.
- Die 3 nationalen Workshops zur Anerkennung von ORD-Beiträgen wurden planmässig unter Mitwirkung aller Partner durchgeführt.
- Die Resultate der 3 Workshops wurden zu einem Endbericht synthetisiert.
- Die Resultate wurden an relevante Zielgruppen kommuniziert.
Veränderungen gab es im Budget, da die FHNW sich noch vor Projektbeginn aus Ressourcengründen aus dem Projekt zurückziehen musste. In Absprache mit swissuniversities wurden das Budget im Projekt umverteilt. Die HESSO konnte gesundheitsbedingt nur beschränkt teilnehmen und ein paar Partner haben die Mittel nicht vollständig ausgeschöpft.
Aktionslinie D2.3: Anreize, Unterstützung und Finanzierung für Forschungsdatenschutzbeauftragte (RDPO) an Hochschulen
Aktionslinie D2.3 zielte darauf ab, die Funktion von Research Data Protection Officers (RDPO) an den Hochschulen zu fördern, zu unterstützen und zu finanzieren, um die Forschungsgemeinschaften bei Bedarf in rechtlichen Fragen zu unterstützen. Diese Aktionslinie wurde in Form eines Mandats umgesetzt, welches die folgenden Leistungen beinhaltet: Vernetzung der Datenschutzbeauftragten der Schweizer Hochschullandschaft und wo sinnvoll mit weiteren Expert:innen, Sammlung und Konsolidierung der datenschutzrechtlichen offenen Fragen zu ORD an Schweizerischen Hochschulen sowie eine Analyse der eidgenössischen, kantonalen und internationalen Gesetze und der von ORD betroffenen Normen (Panorama der betroffenen Normen).
DPO & ORD
Projektbeschreibung
Das Projekt D2.3, gefördert von swissuniversities, zielte darauf ab, die Funktion von Datenschutzbeauftragten (DPO) an Schweizer Hochschulen zu stärken und zu unterstützen. Von Januar bis Dezember 2024 arbeiteten 8 Hochschulen als Partner und 19 weitere als Stakeholder zusammen, um die komplexen rechtlichen Fragen rund um ORD und Datenschutz zu klären.
Hauptziele und Methoden:
- Vernetzung der DPO: Aufbau eines Netzwerks zur Förderung des Austauschs und der Zusammenarbeit zwischen DPO und Experten.
- Sammlung und Analyse rechtlicher Fragen: Konsolidierung und rechtliche Bewertung der offenen Fragen zum Datenschutz im Zusammenhang mit ORD.
- Gesetzesanalyse: Untersuchung der eidgenössischen, kantonalen und internationalen Gesetze, die ORD betreffen, und Erstellung von Informationsdokumenten für Hochschulen.
- Abschlussbericht: Veröffentlichung eines Berichts mit Empfehlungen und Handlungsoptionen für die Open-Science-Delegation.
Projektresultate
Das Projekt führte zu einem umfassenden FAQ-Dokument, das 92 häufig gestellte Fragen zum Datenschutz und ORD beantwortet. Dieses Dokument in deutscher und französischer Sprache ist ein wertvolles Hilfsmittel für DPO und Forschende, um rechtliche Unsicherheiten zu klären und die Einhaltung der Datenschutzbestimmungen zu gewährleisten.
Das Projekt D2.3 hat gezeigt, dass ein gemeinsamer Ansatz und die Bündelung von Ressourcen entscheidend sind, um die Herausforderungen im Bereich Datenschutz und ORD zu bewältigen. Kritische Punkte umfassen die Fragmentierung der Datenschutzgesetze, den Mangel an interdisziplinären Kompetenzen und die unzureichenden Ressourcen. Es wird empfohlen, die Analyse der kantonalen Unterschiede fortzusetzen, DPO-Stellen zu finanzieren und Schulungen für Forschungspersonal auszubauen.
Aktionslinie D2.5: Entwicklung von Leitlinien für die Zusammenarbeit mit dem Privatsektor
Aktionslinie D2.5 zielt darauf ab, Leitlinien für ORD im Falle von Kooperationen mit dem privaten Sektor zu entwickeln. Ziel des Mandats ist es, die bestehenden Regeln (den rechtlichen Rahmen) für die gemeinsame Nutzung von Daten aus der Zusammenarbeit mit dem privaten Sektor zu analysieren und die derzeitigen Praktiken in diesem Zusammenhang zu dokumentieren.
Projekt ORD in Forschungskooperationen zwischen Hochschulen und dem Privatsektor
Projektbeschreibung
Die ETH Zürich hat das Mandat angenommen und die Projektarbeiten unter Mitwirkung von FehrAdvice durchgeführt. Die ETH ist aufgrund ihrer zahlreichen Kooperationen mit Unternehmen des Privatsektors prädestiniert, um ein solches Mandat durchzuführen. Zentrales Projektziel war es, anhand einer Meta-Studie die Regeln und Vorgaben zur gemeinsamen Nutzung von Forschungsdaten in Kooperationen zwischen Hochschulen und dem Privatsektor zu analysieren. Weiter sollte eine Umfrage durchgeführt werden, welche die Erwartungen und Spannungsfelder erhebt, welche sich stellen, wenn Hochschulen in der Zusammenarbeit mit dem Privatsektor Forschungsdaten als ORD verfügbar machen wollen. Die beiden Arbeitsresultate (Meta-Studie und Auswertung der Umfrage) sollen als Grundlage dienen, um eine spätere Guideline für die Anwendung von ORD in Kooperationen zwischen Hochschulen und dem Privatsektor erarbeiten zu können.
Projektresultate
Die Projektverantwortlichen haben sich erst einen Überblick über die zahlreichen Berichte und existierende Policies zum Thema verschaffen müssen. Anschliessend wurde ein Konzept im Sinne eines Inhaltsverzeichnisses der Meta-Studie und der Questionnaires für die Umfrage erarbeitet, diese auch gemeinsam mit swissuniversities an einem Conference Call vom 24. April 2025 besprochen. Eine Schwierigkeit lag dabei im Umstand, dass sich rasch zeigte, dass private Unternehmen ORD zum Teil mit erheblicher Skepsis begegnen, weil sie befürchten, dass die Veröffentlichung von Forschungsdaten als ORD diese dem Zugriff durch Konkurrenten aussetzen würde, sie hierdurch Nachteile im Wettbewerb erleiden könnten. Aus diesen Gründen ist ORD im Sinne der FAIR-Prinzipien regelmässig nicht durchsetzbar in solchen Kooperationsformen von Hochschulen mit Privaten. In der Praxis stehen deshalb Modelle im Vordergrund, für welche die Projektverantwortlichen den Begriff «Shared Data» verwendet haben. Bei diesen werden Forschungsdaten zwischen festgelegten Partnern (z. B. Universität und Unternehmen) ausgetauscht, jedoch nicht veröffentlicht. Sie unterliegen vertraglichen Vereinbarungen (DUA, NDA) und Zugriffsbeschränkungen. Die Shared Data-Modelle spiegeln somit die gelebte Wirklichkeit in solchen Kooperationen wider. Diese Fragestellungen wurden nach Rücksprache mit swissuniversities an einem Conference Call vom 24. April 2025 in die Studie aufgenommen. Die Meta-Studie skizziert hybride Kooperationsmodelle, welche auch konkrete Vorschläge für künftige Guidelines enthalten.
Unterstützung für die Entwicklung und zur Umsetzung der ORD-Aktionslinien an Dritte (Development Funds)
Akademien

Projektbeschreibung
Die Akademien der Wissenschaften Schweiz sind im Rahmen der Nationalen ORD-Strategie für verschiedene Aktionslinien und Aktionsbereiche des zugehörigen Nationalen ORD-Aktionsplans verantwortlich. Dabei nimmt der Präsident von a+ Einsitz in den ORD-Strategierat (StraCo) und der Delegierte Open Science vertritt a+ in der Coordination Group (CoG).
Seit November 2022 koordiniert die eingerichtete ORD-Fachstelle unter der Leitung der Spezialistin für Open Science der Akademien das ORD Sounding Boards Researchers (SB R). Das Board setzt sich aus 17 ORD-Experten:innen verschiedener Fachdisziplinen und Karrierestufen zusammen und dient dem ORD-Strategierat als beratenes Organ. Ferner nimmt das SB R die Jury-Funktion für den Nationalen ORD-Preis wahr.
Seit 2023 richten die Akademien jährlich unter der Leitung der ORD-Fachstelle den Nationalen Preis für offene Forschungsdaten (ORD-Preis) aus, der Schweizer Forschende für innovative Forschungspraktiken und Best Practices im Bereich Open Research Data auszeichnet.
Für das Awareness Raising zum Thema offene Forschungsdaten und das Community Building wurden eine ORD-Website lanciert sowie Social-Media-Kanäle (LinkedIn, Instagram und X bis Ende 2024) eingerichtet. Zudem wurden mehrere Events in Form von Science-After-Noons und Smart Breaks durchgeführt sowie Präsentationen an nationalen und internationalen Veranstaltungen gehalten.
Zur Implementierung von offenen Forschungspraktiken in verschiedenen Fachgesellschaften wurde die Umsetzung von ORD Codes of Conducts für disziplin- und datenspezifische Communities ermöglicht.
Im Bereich Wissenschaftskultur widmeten sich die Akademien weiteren mit Open Science in Verbindung stehenden Themen: Data-Literacy, Data-Stewardship und CoARA.
Projektresultate
Das Sounding Board Researchers hat drei Mandate zu ORD-relevanten Fragen für den ORD-Strategierat bearbeitet, die verschiedene Themen wie Sensitive Data umfassten. Ferner fungierte das SB R zweimal als Jury des Nationalen ORD-Preises. Der Fokus der Ausschreibungen lag 2023 auf der Wiederverwendung von Forschungsdaten und berücksichtige 2025 auch kollaborative/interdisziplinäre Ansätze sowie bildungsorientierte Outreach-Massnahmen.
Der ORD-Preis hat das Bewusstsein für offene Forschungsdaten in der Schweiz geschärft und eine offene Forschungskultur innerhalb wissenschaftlicher Communities gefördert. Die UNESCO beabsichtigt, den ORD-Preis als gutes Beispiel für einen positiven Anreiz zur Förderung von ORD-Praktiken in der Forschung in ein neues Online-Kompendium zu Open Science Praktiken aufzunehmen.
Während die ORD-Website als etabliertes Informationsportal dient, versorgt der LinkedIn-Kanal (950 Follower) relevante (Fach-)Gruppen und die ORD-Community mit aktuellen Infos zu Veranstaltungen und dient als Sensibilisierungsinstrument zum Thema der offenen Forschung. Der Instagram-Kanal (230 Follower) richtet sich an eine jüngere Followerschaft und bietet über die Story-Funktion zusätzliche Eindrücke wie «behind the scenes» sowie kreative Wissensvermittlungselemente in Form von Reels. Die ORD-Fachstelle setzte eine Awareness-Kampagne namens «Open research data through the seasons» um und partizipierte mehrmals aktiv an der Love-Data-Week.
Ferner wurden drei hybride Science-After-Noon-Events und eine Smart Break zu Themen wie Data-Literacy, Citizen Science und CoARA veranstaltet. Durch eine Zusammenarbeit der AG Open Science und externen Experten wurde die Data-Literacy-Charta Schweiz publiziert.
Insgesamt wurden drei Codes of Conducts umgesetzt: Code of Conduct for Preclinical Neuroimaging Data (COCOPREND), Code of Conduct for Visual Social Research (CodeVis) und Code of Conduct for Indoor Positioning Research (Coordinance).
Strategy Council

Projektbeschreibung
Das übergreifende Ziel des StraCo ist es, den Forschenden in der Schweiz die bestmögliche ORD-Infrastruktur und -Dienstleistungen bereitzustellen, um eine nahtlose Zusammenarbeit mit nationalen und globalen Forschungsnetzwerken zu ermöglichen.
Zu diesem Zweck wendet der StraCo den Blueprint-Prozess an, eine strukturierte Methode der strategischen Planung zur Konsolidierung und Strukturierung der Schweizer ORD-Landschaft. Konzeptionell umfasst der Blueprint drei Schritte: (1) Analyse der Landschaft; (2) Formulierung strategischer Orientierungen (Blueprint Stufe A); (3) Überführung dieser Orientierungen in konkrete Umsetzungspfade (Blueprint Stufe B).
Der Blueprint hat nicht zum Ziel, sämtliche bestehenden Infrastrukturen vollständig zu erfassen, sondern eine zukunftsgerichtete Einschätzung zu liefern, die die langfristige Planung unterstützt. Ein zentrales Prinzip des Prozesses ist die Ko-Kreation mit den relevanten Akteurinnen und Akteuren, um sicherzustellen, dass die Analysen auf einem gemeinsamen Verständnis und praktischer Erfahrung beruhen. Der Blueprint dient als strategisches Orientierungsinstrument: Er informiert Entscheidungen zu Finanzierung und Koordination, ohne diese direkt festzulegen.
Angesichts der Komplexität und der mehrstufigen Struktur des ORD-Ökosystems wird der Blueprint mittels eines Cluster-Ansatzes umgesetzt. Anstatt die gesamte Landschaft auf einmal zu analysieren, konzentriert sich der StraCo auf spezifische thematische oder disziplinäre Bereiche, in denen vertiefte Analysen die strategische Entscheidungsfindung am wirksamsten unterstützen.
Ein Cluster ist ein thematischer oder disziplinärer Bereich, in dem:
- eine Konzentration von verwandten ORD-Initiativen vorhanden ist oder anderweitige Bereiche mit einer hochdynamischen ORD-Entwicklung,
- mehrere Akteure, sowohl national als auch international, tätig sind,
- strategische Koordination erforderlich und/oder erwünscht ist,
- Infrastrukturen von «herausragender nationaler Bedeutung» vorhanden sein dürften.
Des StraCo hat derzeit zwei Cluster priorisiert:
- Gesundheit und Lebenswissenschaften (Health and Life Sciences, HLS)
- Sozial- und Geisteswissenschaften (Social Sciences and Humanities, SSH)
Für jedes Cluster wurden eigene Task Forces eingesetzt, um strategische Analysen nach einer standardisierten Methodik durchzuführen. Ihre Ergebnisse wurden in Berichten zusammengefasst und dem StraCo vorgelegt, wodurch dieser unterschiedliche Entwicklungsszenarien beurteilen und strategische Orientierungen festlegen konnte.
Für das Cluster Gesundheit und Lebenswissenschaften hat die Task Force ihre Landschaftsanalyse im Februar 2024 abgeschlossen (Endbericht lesen), und das Dokument mit den strategischen Orientierungen (Blueprint Stufe A) wurde im September 2024 veröffentlicht (Blueprint HLS Stufe A lesen). Für das Cluster Sozial- und Geisteswissenschaften veröffentlichte die Task Force ihre Landschaftsanalyse im April 2025 (Endbericht lesen).